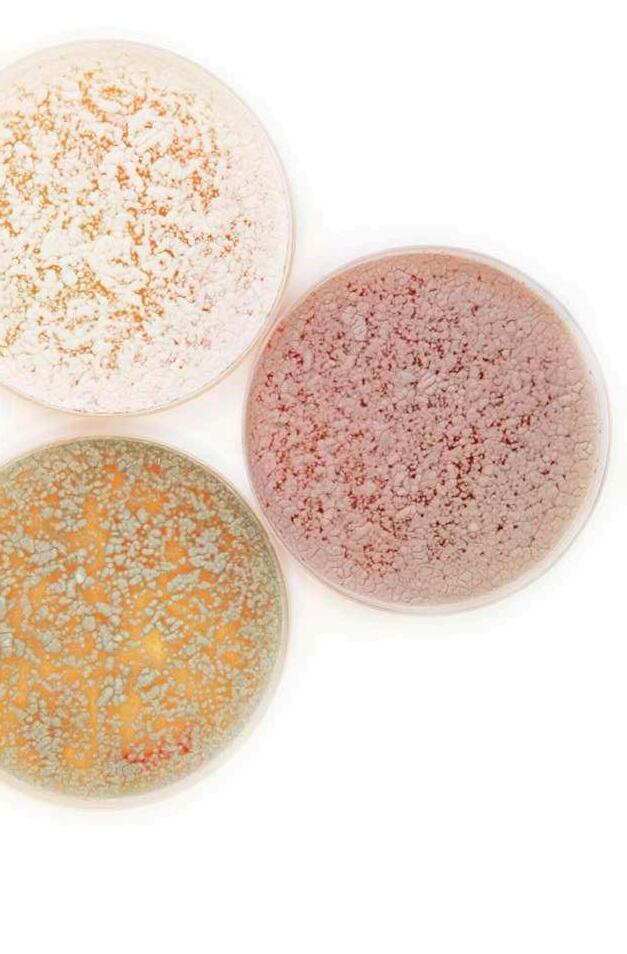

¡Suscríbete!


¡Suscríbete!






Suvaxyn® PRRS MLV liofilizado y disolvente para suspensión inyectable para porcino. Composición: Cada dosis (2 ml) contiene: Virus PRRS vivo modificado, cepa 96V198: 102,2 – 105,2 DICC50*. ** Dosis infectiva en cultivo celular 50%. Indicaciones: Para la inmunización activa de cerdos clínicamente sanos a partir de 1 día de edad en un ambiente contaminado por el virus del síndrome respiratorio y reproductivo porcino (PRRS), para reducir la viremia y la excreción nasal causada por la infección con cepas europeas del virus PRRS (genotipo 1). Establecimiento de la inmunidad: 21 días después de la vacunación. Duración de la inmunidad: 26 semanas después de la vacunación. Cerdos de engorde: Además, la vacunación de lechones seronegativos de 1 día de edad demostró una reducción significativa de las lesiones pulmonares frente al desafío administrado 26 semanas después de la vacunación. La vacunación de lechones seronegativos de 2 semanas de edad demostró una reducción significativa de las lesiones pulmonares y excreción oral frente al desafío administrado a los 28 días y 16 semanas después de la vacunación. Cerdas nulíparas y adultas: Además, la vacunación antes de la gestación en cerdas nulíparas y adultas clínicamente sanas, tanto previamente expuestas al virus PRRS (es decir, bien inmunizadas frente al virus PRRS mediante vacunación, o expuestas al virus PRRS por infección de campo) como no expuestas anteriormente, demostró una reducción de la infección transplacentaria causada por el virus PRRS durante el último tercio de la gestación y reducción del impacto negativo asociado al rendimiento reproductivo (reducción de la incidencia de mortinatos, de la viremia de los lechones al nacimiento y al destete, de las lesiones pulmonares y de la carga viral en los pulmones de los lechones al destete). Contraindicaciones: No usar en explotaciones donde el virus PRRS europeo no haya sido detectado por métodos de diagnóstico fiables. No usar en verracos donantes de semen, puesto que el virus PRRS puede ser excretado en el semen. No usar durante la segunda mitad de la gestación en cerdas nulíparas y adultas gestantes si no han estado expuestas previamente al virus PRRS porque la cepa vacunal puede atravesar la placenta. La administración de la vacuna a cerdas nulíparas y adultas gestantes que no han estado previamente expuestas al virus PRRS durante la segunda mitad de la gestación puede afectar a su rendimiento reproductivo. Advertencias especiales para cada especie de destino: Vacunar únicamente animales sanos. Precauciones especiales para su uso en animales: Deben tomarse precauciones para evitar la introducción de la cepa vacunal en un área en la que no esté presente el virus PRRS. Los animales vacunados pueden excretar la cepa vacunal durante más de 16 semanas después de la vacunación. La cepa vacunal puede propagarse a cerdos en contacto. La vía de propagación más común es el contacto directo, pero no puede excluirse la propagación a través de objetos contaminados o por vía aérea. Deben adoptarse precauciones especiales para evitar la propagación de la cepa vacunal a animales no vacunados (p.ej.: cerdas nulíparas y adultas gestantes no expuestas previamente al virus PRRS en la segunda mitad de la gestación) que deben permanecer libres del virus PRRS. Se recomienda vacunar a todos los cerdos de una explotación a partir de la edad mínima recomendada. Los animales que no hayan tenido contacto con el virus PRRS, introducidos en la explotación (p.ej., cerdas nulíparas de reposición de lotes negativos para el virus PRRS) deben ser vacunados antes de la gestación. Puede utilizarse en cerdas nulíparas y en cerdas adultas antes de la cubrición no expuestas con anterioridad al virus PRRS o en la primera mitad de la gestación. Puede utilizarse en cerdas nulíparas y adultas expuestas con anterioridad al virus PRRS en la segunda mitad de la gestación. No ha quedado demostrada la seguridad de la vacuna durante la lactancia. Conservación: Conservar y transportar refrigerado (entre 2 °C y 8 °C). El disolvente puede ser conservado fuera de la nevera entre 15 °C – 25 ºC. No congelar. Proteger de la luz. Período de validez después de su reconstitución: uso inmediato. Eliminación: Todo medicamento veterinario no utilizado o los residuos derivados del mismo deberán eliminarse de conformidad con las normativas locales. Tiempo de espera: Cero días. Titular: Zoetis Belgium SA. Nº Registro: EU/2/17/215/001–003. Medicamento sujeto a prescripción veterinaria.
DIAGNÓSTICO DE LABORATORIO DE PROCESOS INFECCIOSOS – TOMA DE MUESTRAS Y TÉCNICAS DIAGNÓSTICAS
Sofía Lázaro, Gema Chacón y Clara Baselga Exopol
ANESTESIA Y ANALGESIA EN LA CASTRACIÓN PORCINA
Cristina Bonastre Ráfales
DVM, PhD - Departamento de Patología Animal de la Facultad de Veterinaria de la Universidad de Zaragoza
ESTRATEGIAS DE MANEJO EN GRANJAS PORCINAS BASADAS EN NUEVOS PROGRAMAS VACUNALES
Entrevista a Jesús Bollo, Product Manager Business Unit Swine en MSD Animal Health
MICOTOXINAS EMERGENTES Y SUS EFECTOS EN EL PORCINO
Panagiotis Tassis
Profesor Adjunto de Medicina y Reproducción Porcina Clínica de Animales de Producción, Facultad de Medicina Veterinaria de la Universidad Aristóteles de Tesalónica, Grecia.
FALLOS EN LAS ESTRATEGIAS DE CONTROL DE CYSTOISOSPORA SUIS RECOMBINACIÓN DE PCV2: UN NUEVO DESAFÍO PARA LOS PROGRAMAS DE CONTROL DE CIRCOVIRUS PORCINO
Salvador Oliver, Sonia Cárceles, Laura Garza, Carlos Casanovas y David Espigares
Servicio Técnico Porcino - Ceva Salud Animal
SÍNDROME SPLAY LEG EN LECHONES - ACTUALIZACIÓN DE UN DEFECTO CONGÉNITO CONOCIDO DESDE HACE
TIEMPO
Toni Schumacher, Monika Röntgen y Steffen Maak, Instituto de biología y crecimiento muscular, Instituto Leibniz de biología de animales de granja (fbn), Dummerstorf, Alemania
PROTECCIÓN CRUZADA FRENTE A PCV-2¿SON EFECTIVAS LAS VACUNAS ACTUALES FRENTE A LOS DIFERENTES GENOTIPOS?
Gisela Girmé y Sebastián Figueras
Boehringer Ingelheim Animal Health España, S.A.U.
CINÉTICA DE INFECCIÓN CON VIRUS DE LA INFLUENZA A Y VIRUS PRRS EN CERDOS
Małgorzata Pomorska-Mól1, Katarzyna Podgórska2 , Ewelina Czyżewska-Dors2 , Hanna Turlewicz-Podbielska1, Maciej Gogulski1, JanWłodarek1 y Anna Łukomska1
1 Departamento de Ciencias Preclínicas y Enfermedades Infecciosas, Facultad de Medicina Veterinaria y Ciencias Animales, Universidad de Ciencias de la Vida de Poznan, Polonia
2Departamento de Enfermedades Porcinas, Instituto Nacional de Investigación Veterinaria, Pulawy, Polonia
Kevin Shulz
National Hog Farmer
HALLAZGOS PATOLÓGICOS EN JABALÍES INFECTADOS CON UNA CEPA VIRULENTA DEL VIRUS DE LA PESTE PORCINA AFRICANA
Antonio Rodríguez-Bertos 1 , 2, Estefanía Cadenas-Fernández 1 , 3, Agustín Rebollada-Merino1, 2, Néstor Porras-González 1, Francisco J. Mayoral-Alegre 1, Lucía Barreno 1 , 2 , Aleksandra Kosowska 1 , 3, Irene Tomé-Sánchez 1, José A. Barasona 1 , 3 y José M. Sánchez-Vizcaíno 1 , 3
1Centro de Vigilancia Sanitaria Veterinaria (VISAVET), Universidad Complutense de Madrid
2Departamento de Medicina Interna y Cirugía Animal, Facultad de Veterinaria, Universidad Complutense de Madrid
3Departamento de Sanidad Animal, Facultad de Veterinaria, Universidad Complutense de Madrid
AVANCES EN EL DESARROLLO DE MÉTODOS DE DETECCIÓN DE RESIDUOS ANTIBIÓTICOS EN ANIMAL VIVO
Dra. Mª Jesús Serrano Andrés
Unizar-IA2
Agradecemos a nuestros anunciantes por hacer posible la publicación de esta revista: Boehringer Ingelheim, Ceva, Elanco, MSD Animal Health, S.P. Veterinaria, Syva y Zoetis.
Pyrsvac-183 ®
Vacuna viva atenuada frente al PRRS liofilizado y disolvente para suspensión inyectable
COMPOSICIÓN POR DOSIS: Virus vivo PRRS, cepa atenuada europea ALL183 ≥ 105,0 DICT50 INDICACIONES: Inmunización activa frente al PRRS (síndrome reproductivo y respiratorio porcino). Reduce los signos clínicos tras la infección por una cepa virulenta del PRRS. Reduce el índice de transmisión de la enfermedad. Inicio de la inmunidad: 2 semanas después de la vacunación. Duración de la inmunidad: 16 semanas tras la vacunación. CONTRAINDICACIONES: No usar en animales hipertérmicos, antes de ser transportados o cualquier otra situación que pueda dar origen a inmunosupresión. VÍA DE ADMINISTRACIÓN: Intramuscular.
POSOLOGÍA: 2 ml/animal. TIEMPO DE ESPERA: Cero días. PRESENTACIÓN: Envase con 50 dosis (10 viales de 5 dosis). Envase con 50 dosis (2 viales de 25 dosis). Envase con 500 dosis (20 viales de 25 dosis). Con prescripción veterinaria. Nº de registro: 2918 ESP.


www.facebook.com/syvacontigo
Sede Central: Parque Tecnológico de León Avda. Portugal s/n Parc. M20 • 24009 León - España Teléfono: 987 800 800 • e-mail: mail@syva.es www.syva.es
@syvacontigo
¿Qué tiene la ciencia que nos atrae, nos intriga y nos cautiva para siempre? Sin duda, cuando uno vislumbra el mundo por primera vez bajo el prisma de la ciencia, ya no hay vuelta atrás y es imposible no sentirse abrumado, maravillado por la complejidad y elegancia de los sistemas biológicos que han evolucionado, cada uno con sus propios mecanismos de supervivencia y reproducción, hasta la actualidad.
La curiosidad, esa cualidad innata que subyace a cualquier descubrimiento científico, es lo que ha impulsado al ser humano en su afán por comprender los misterios del mundo que nos rodea.
Esta misma curiosidad es la que nos permite descifrar los enigmas que se ocultan en los genes o destapar las estrategias de invasión y evasión de los patógenos que comprometen la salud porcina y HUMANA.
¿Por qué hacer hincapié en la salud humana en una revista para veterinarios de porcino? La razón es sencilla.
La profesión veterinaria está irremediablemente ligada a la salud humana, siendo los veterinarios garantes esenciales de la seguridad alimentaria y del uso responsable de antibióticos, y la primera barrera frente a las enfermedades zoonóticas.
Y es que el lema “Hygia pecoris, salus populi - La higiene del ganado, la salud del pueblo" tiene hoy más relevancia que nunca con el concepto más actualizado y universal de “ONE HEALTH – UNA SOLA SALUD”.
La importante labor de los profesionales veterinarios conlleva alimentar esa curiosidad innata con información veraz, objetiva y contrastada, permitiendo el desarrollo de estrategias de prevención, resiliencia y productividad que, una vez más, nos permitan colocar y mantener al sector porcino donde debe estar, al servicio de la humanidad, produciendo una fuente de proteína segura, asequible y saludable.
¡Elfuturotraeconsigonuevos retos frente a los que será necesario estar preparados!
porciSapiens nace para ofrecer a los veterinarios de porcino información rigurosa y actualizada sobre los últimos avances en técnicas de diagnóstico, patología, vacunación, uso responsable de antibióticos, genética y reproducción en un novedoso y espectacular formato.

¡La veterinaria nos ofrece la oportunidad de adquirir nuevos conocimientos cada día y con porciSapiens no querrán dejar de aprender!
porciS apiens
EDITOR
GRUPO DE COMUNICACIÓN AGRINEWS S.L.
DISEÑO GRÁFICO & WEB
Marie Pelletier
Enrique Núñez Ayllón
Sergio Rodríguez
PUBLICIDAD
Laura Muñoz +34 629 42 25 52 laura@mediatarsis.com
Luis Carrasco +34 605 09 05 13 lc@agrinews.es
REDACCIÓN
Daniela Morales
Osmayra Cabrera
F.X. Mora
Jose A. Silva
ADMINISTRACIÓN
Mercè Soler
Barcelona
España
Tel: +34 93 115 44 15 info@agrinews.es
www.porcino.info
www.porcino.info/porcisapiens/
Precio de suscripción anual:
España 45 €
Extranjero 120 €
DIRIGIDA A VETERINARIOS DE PORCINO
Depósito Legal PorciSapiens B 7620-2021
Un espacio único para ahondar en la ciencia que impulsa al sector porcino
l diagnóstico de enfermedades infecciosas tiene como principal objetivo identificar el agente o los agentes causantes para poder aplicar el tratamiento más eficaz, así como establecer las medidas de prevención adecuadas.
Para tal fin, existen diversas técnicas o metodologías que permiten determinar la presencia del agente patógeno de forma directa (por cultivo microbiológico o por técnicas moleculares) o indirecta (detección de anticuerpos mediante técnicas serológicas). Además, en muchas ocasiones no siempre es suficiente con identificar la especie que está causando el problema sino llegar a su caracterización a nivel de subespecie


La obtención de resultados de calidad, es decir, fiables y representativos del proceso de la explotación, está supeditada a una correcta selección de animales y muestras a tomar.
A la hora de seleccionar los animales se debe tener en cuenta:
1 2 3 4 5
Analizar más de un animal para que los resultados sean representativos del grupo de animales afectados.
Seleccionar animales con sintomatología clínica al inicio del proceso, lo que permitirá evaluar los agentes primarios desencadenantes del proceso.

Enviar muestras antes de instaurar el tratamiento antibiótico, ya que éste interfiere en los resultados microbiológicos.
Enviar muestras de animales sacrificados o en su defecto recién muertos, ya que la autolisis de las muestras afecta en gran medida al éxito diagnóstico.
Al seleccionar el número de muestras, es importante estratificarlas en función de la edad de los animales, del estado productivo etc.
Sofía Lázaro, Gema Chacón y Clara Baselga ExopolEl tipo de muestra se seleccionará en función de:
El tipo de proceso: reproductivo, digestivo, respiratorio, cutáneo, articular, poliserositis o nervioso.
El agente patógeno a estudiar.
La técnica diagnóstica solicitada: cultivo microbiológico, qPCR, serología, etc.
El objetivo del análisis: monitorización o diagnóstico.

Se recomienda consultar previamente con el laboratorio. En la Tabla 1 se recogen los principales tipos de muestras en función del proceso a estudiar.
Proceso/ tipo de muestra Órganos Lavados Raspados Hisopos Heces Sueros Fluidos orales Muestra ambiental
Respiratorios
Nerviosos
Poliserositis
Articulares
Digestivos
Reproductivos
Cutáneos
El cultivo microbiológico es la técnica clásica para diagnóstico de enfermedades infecciosas bacterianas. Consiste en cultivar la muestra clínica en medios de crecimiento específicos y la posterior identificación de las colonias con interés clínico obtenidas.
La identificación y caracterización de las colonias se ha realizado tradicionalmente por pruebas bioquímicas, aunque en los últimos años, el uso de tecnologías como la espectrometría de masas -equipos
MALDI-TOF (Matrix-Assisted Laser Desorption/Ionizationdesorción/ionización láser asistida por matriz)- han cobrado una gran relevancia para este propósito. Este tipo de análisis destaca por la rapidez y la identificación fiable que proporciona a nivel de género y especie.

La tecnología MALDI-TOF permite detectar el conjunto de proteínas de las distintas especies bacterianas ya que cada una de ellas posee una “huella molecular” característica. Estas huellas se comparan con una base de datos con miles de entradas de bacterias patógenas en veterinaria para saber de qué bacteria se trata (Figura 1)
FIGURA 1
Identificación de bacterias por MALDI-TOF. En una placa se depositan las colonias y, a continuación, un láser destruye las células y volatiliza las proteínas del interior, llegando estas últimas al detector dando lugar a un espectro característico.
Los aislamientos bacterianos de interés que pueden estar causando el proceso clínico deben someterse a pruebas de sensibilidad antibiótica, siendo de especial importancia dada la creciente problemática de la aparición de resistencias.
Las pruebas de sensibilidad antibiótica, entre las que destacan el método de Kirby Bauer (disco-placa) o Concentración Mínima Inhibitoria (CMI), permiten determinar el perfil de sensibilidad de las cepas analizadas y decidir la mejor opción de tratamiento.
La técnica de Kirby Bauer o disco-placa consiste en sembrar la bacteria en una placa de agar y colocar discos impregnados con una cantidad de antibiótico estandarizada. Si el antibiótico inhibe el crecimiento de la misma, se creará un halo de inhibición de un determinado diámetro. Este diámetro se compara con unos puntos de corte clínicos establecidos previamente determinando si la bacteria es sensible o resistente a cada uno de los antibióticos evaluados (Figura 2)

FIGURA 2
CONCENTRACIÓN
CONCENTRACIÓN
En la técnica de CMI, la bacteria se enfrenta a diferentes concentraciones de un antibiótico, siendo el valor de concentración mínima inhibitoria la menor concentración frente a la cual la bacteria no es capaz de crecer
Al igual que con la técnica Kirby Bauer, esta concentración se compara con puntos de corte clínicos establecidos para conocer el perfil de sensibilidad. La determinación de la CMI puede realizarse por diferentes métodos, siendo el método de microdilución (Figura 3) y tiras de celulosa los más utilizados.
FIGURA 3
Técnica Kirby Bauer. La evaluación del diámetro de halo de inhibición de crecimiento bacteriano en torno a discos impregnados de antibióticos permite valorar las probabilidades de éxito terapéutico frente a cada uno de los antibióticos. Así la bacteria evaluada mostrará un perfil de sensibilidad a distintos antibióticos, desde más SENSIBLE (antibiótico D) a más RESISTENTE (antibiótico C), pudiendo encontrarse niveles de sensibilidad intermedia.
32 puntos de corte clínicos para el antibiótico B
sensible: ≤ 8
resistente: ≥ 32 antibiótico B es sensible porque 4 es ≤ 8
Técnica de CMI mediante microdilución. Se realiza en placas de 96 pocillos donde la bacteria a evaluar se enfrenta a diferentes concentraciones de antibiótico, de modo que el valor de CMI es la concentración más pequeña que inhibe el crecimiento bacteriano.
Las técnicas inmunológicas permiten evaluar la presencia de inmunoglobulinas (anticuerpos) en suero como respuesta inmunitaria humoral a un agente infeccioso. Se basan en la unión irreversible entre una sustancia antigénica (Ag) como virus, bacteria o parásito y su correspondiente anticuerpo (Ac). La formación de los complejos Ag-Ac se evalúa mediante:
Marcadores enzimáticos, fluorescentes o quimioluminiscentes. Observación de la aglutinación.
El ELISA (enzyme linked immunosorbent assay) es un tipo de inmunoensayo en el que el Ag se encuentra ligado a una fase sólida (placas de 96 pocillos). Los diseños de los ensayos son diversos (Figura 4) pero todos ellos tienen en común la utilización de enzimas como marcador
Los anticuerpos del suero se unen al antígeno (Ag) pegado en la placa, bloqueando la posterior unión al anticuerpo (Ac) marcado enzimáticamente.
Los anticuerpos del suero se unen al antígeno (Ag) que está pegado a la placa, así será reconocido por el anticuerpo marcado enzimáticamente.
FIGURA 4
Técnicas de ELISA más utilizadas (ELISA de bloqueo y ELISA indirecto) para la detección de agentes infecciosos en la especie porcina.
A la hora de seleccionar una técnica de ELISA deberemos valorar una serie de premisas:
Tipo de inmunoglobulina: se pueden detectar inmunoglobulinas totales, IgM y/o IgG.
Las IgM se producen durante las primeras fases de la respuesta inmunitaria.
Las IgG predominan en la respuesta inmunitaria secundaria.
Estado de vacunación de los animales: la mayoría de las técnicas serológicas no diferencian entre anticuerpos vacunales y anticuerpos producidos por una infección, siendo una limitación en caso de animales vacunados. No obstante, existen en el mercado algunos ensayos DIVA (como Aujeszky gE) que permiten la diferenciación si los animales han sido vacunados con vacunas marcadas.
Objetivo del análisis:
Los ELISA indirectos están diseñados para evaluar prevalencias de enfermedades a nivel de población, muy útiles en el seguimiento y monitorización de explotaciones positivas.
Los ELISA de bloqueo tienen por objetivo la realización de diagnósticos individuales, siendo habitual su uso para confirmar resultados de otra técnica screening
Por último, indicar que en ocasiones no es suficiente un único análisis serológico para llegar a una conclusión diagnóstica, sino que se deben realizar dos análisis con una separación de 2-3 semanas para demostrar seroconversión frente al agente infeccioso.
TÉCNICAS DE AGLUTINACIÓN TÉCNICAS DE AGLUTINACIÓN
MACROAGLUTINACIÓN
La macroaglutinación consiste en la observación macroscópica de la aglutinación por la unión Ag-Ac.
El ejemplo más conocido es la técnica de Rosa de Bengala para la detección de Brucella spp. (Figura 5). Esta técnica es económica y sensible, pero, debido a la reacción cruzada con otras bacterias (Yersinia enterocolitica o algunos serovares de Escherichia coli), los resultados positivos deben ser confirmados.
Rosa de Bengala positivo negativo
FIGURA 5
Técnica de Rosa de Bengala para la detección de anticuerpos frente a Brucella spp. La observación de aglutinación macroscópica evidencia la presencia de anticuerpos.
MICROAGLUTINACIÓN
En el caso de las técnicas de microaglutinación (MAT) es necesaria la utilización de un microscopio para evaluar la aglutinación.
La serología de Leptospira se realiza mediante MAT y es específica de cada serovar. En porcino los serovares más estudiados son L. bratislava y L. pomona al ser los considerados adaptados a la especie.
Las técnicas moleculares son aquellas técnicas basadas en la detección de ácidos nucleicos (ADN o ARN) para determinar la presencia del agente etiológico en la muestra clínica. También se engloban dentro de este grupo aquellas que analizan las proteínas.
En los últimos años, las técnicas moleculares han ido cobrando gran importancia por su rapidez,
sensibilidad y especificidad. En comparación al cultivo microbiológico son técnicas mucho más rápidas, obteniéndose resultados en unas pocas horas, y permiten detectar bacterias de difícil crecimiento o virus, cuyo diagnóstico por cultivo resulta mucho más complejo.
Dentro de las técnicas moleculares cabe destacar la PCR a tiempo real, y otras como la secuenciación, microarrays o secuenciación masiva (más conocida como NGS, Next generation sequencing).
LAS TÉCNICAS MOLECULARES
La PCR a tiempo real, también conocida como PCR cuantitativa (qPCR), es la técnica molecular más ampliamente utilizada hoy en día. Consiste en la detección y amplificación de regiones específicas del genoma de los diferentes agentes patógenos.
La detección se realiza tras cada ciclo de PCR gracias al uso de oligonucleótidos marcados con moléculas fluorescentes que se unen a la región amplificada de modo que,
a mayor cantidad de genoma del agente, mayor fluorescencia.
El ciclo en el que esta señal supera umbral de detección es lo que se conoce como el valor Cq , de modo que valores Cq menores indican una mayor cantidad del agente en la muestra inicial. Así, utilizando una muestra de ácido nucleico cuantificado se puede determinar la cantidad de patógeno en la muestra inicial.
Muestra 1: Positiva***(valor Cq=25)
Muestra 2: Positiva* (valor Cq=31)
LOS VALORES C q
MENORES INDICAN
UNA MAYOR CANTIDAD DEL AGENTE EN LA MUESTRA INICIAL
FIGURA 6
Señal
40
Ciclos
Umbral de detección
Muestra 3: Negativa
Gráfica de la señal de fluorescencia en diferentes muestras durante un ensayo de PCR a tiempo real.
La PCR a tiempo real permite detectar, además de bacterias, virus o parásitos, genes codificantes de factores de virulencia, como toxinas, fimbrias, adhesinas, etc. que, en algunas ocasiones, son imprescindibles para evaluar la implicación del agente infeccioso en la patología (por ejemplo, en caso de Escherichia coli o Clostridium perfringens). Esta técnica también permite una identificación a nivel de subespecie (por ejemplo, diferentes serotipos de Streptococcus suis o Actinobacillus pleuropneumoniae).
Entre las técnicas de secuenciación, la más empleada es la secuenciación de Sanger que permite determinar la secuencia de nucleótidos de una o varias regiones específicas del genoma de un determinado patógeno.
Dentro del ámbito de las enfermedades infecciosas, esta herramienta posibilita, entre otros, establecer el origen de un brote, es decir, conocer si la cepa circulante estuvo antes, si se trata de una nueva o si por el contrario dicha cepa es una cepa vacunal.
La secuenciación es una técnica muy útil para el control y monitorización de ciertas enfermedades como, por ejemplo, el virus del Síndrome Respiratorio y Reproductivo Porcino (PRRS). No obstante, las aplicaciones de la secuenciación pueden ir más allá, por ejemplo:
Es posible genotipar el rotavirus A en base a las secuencias codificantes de las proteínas virales VP7 (determina el genotipo G) y VP4 (genotipo P).
Se puede genotipar el virus de la Influenza A, cuyo genotipo está definido por las secuencias de la hemaglutinina (H) y la neuraminidasa (N) (ejemplo: H1N1).
Otro técnica basada en secuenciación que puede ser empleada para el tipado a nivel de subespecie es la de MLST (Multi Locus Sequence Typing), la cual permite clasificar las cepas bacterianas en un tipo u otro (denominado sequence type o ST) en función de la secuencia de ADN de siete de sus genes de acuerdo a una clasificación previamente descrita. Un ejemplo en porcino es la realización de MLST para diferenciar entre cepas de Brachyspira hyodysenteriae.
Por último, cabe destacar las tecnologías de secuenciación de nueva generación (Next Generation Sequencing , NGS) que han aumentado la capacidad de secuenciación, permitiendo secuenciar desde genomas completos a ecosistemas (microbioma, metagenómica) y proporcionando una gran cantidad de información de una sola muestra.
En definitiva, la base del diagnóstico en el laboratorio comienza en la propia toma de muestras y continúa con la elección de la técnica más adecuada para realizar un correcto diagnóstico que abarca diferentes objetivos, desde la identificación del agente etiológico hasta estudios de tipado o variabilidad de cepas. Es importante tener claro que cada una de las técnicas proporciona un tipo de información diferente y que se pueden complementar aumentando la sensibilidad diagnóstica y permitiendo conocer el agente etiológico de forma precisa.
La castración quirúrgica de los lechones en las granjas es una práctica que habitualmente se realiza en los lechones macho para prevenir o evitar la presencia de olor sexual en las canales, la agresividad entre los individuos y las montas indeseadas (EFSA, 2004; Fredriksen et al., 2011).
CONTEXTO ACTUAL Y LEGISLACIÓN VIGENTE
En España, según el Real Decreto 1135/2002 de 31 de octubre, relativo a las normas mínimas de protección de cerdos y de acuerdo con la Directiva de la Comisión Europea 2001/93/EC, está permitido realizar la castración de los lechones macho sin necesidad de aplicar ningún tipo de anestesia ni analgesia prolongada dentro de los primeros siete días de vida, mediante métodos que no supongan el desgarro de los tejidos y siempre que esta práctica sea realizada por personal cualificado.
Cristina Bonastre Ráfales DVM, PhD - Departamento de Patología Animal de la Facultad de Veterinaria de la Universidad de Zaragoza
DVM, PhD - Departamento de Patología Animal de la Facultad de Veterinaria de la Universidad de Zaragoza
A partir del séptimo día de vida, la normativa vigente obliga a que la castración de los machos se realice bajo anestesia y aportando analgesia prolongada, debiendo ser ambas administradas por un veterinario (RD 1135/2002 de 31 de octubre).
En relación a la castración de las hembras, la normativa vigente sólo permite dicha intervención excepcionalmente por motivos
terapéuticos o profilácticos, como en el caso de las hembras de explotaciones porcinas de extensivo.
La cirugía debe realizarse siempre bajo anestesia y administrando analgesia por parte del veterinario, que además es el que debe realizar y certificar la intervención quirúrgica (RD 1221/2009 de 17 de julio).
En Europa, según el informe publicado con el Consorcio CASTRUM (2016), la situación en los diferentes países miembros respecto a la castración quirúrgica de los lechones seguía siendo heterogénea.
La castración quirúrgica se había abandonado parcialmente en países como España y Portugal y casi en su totalidad en otros como Irlanda o Reino Unido.
En ambos casos la alternativa a la castración quirúrgica de los lechones es la cría de machos enteros que son sacrificados
Castración permitida sin aplicar anestesia/analgesia prolongada
OBLIGATORIO aplicar anestesia/analgesia prolongada
Prohibido usar métodos que provoquen desgarro de tejidos
Anestesia/analgesia aplicada por veterinario
antes de alcanzar la pubertad, obteniendo un menor peso de las canales en el momento del sacrificio.
En Croacia, Bulgaria, Eslovenia, Polonia, Hungría o Italia entre otros, la castración quirúrgica seguía haciéndose mayoritariamente sin anestesia ni analgesia.
Países como Suiza, Bélgica o Noruega permitían la castración quirúrgica de los lechones macho, realizada únicamente por veterinarios y bajo anestesia y analgesia prolongada, independientemente de la edad de los animales (Fredriksen et al., 2009; Fredriksen et al., 2011; CASTRUM consortium, 2016).

Actualmente, tan solo dos países europeos, Alemania y Francia, han fijado como fecha para el fin de la castración quirúrgica el año 2021.
En el caso de Alemania se ha regulado el uso de isoflurano como anestésico inhalatorio en la castración de lechones por parte de personal cualificado que deberá acreditar formación teórico-práctica.
En Francia se ha autorizado a los ganaderos al uso de anestésicos y analgésicos para reducir el dolor en este y en otros procedimientos de manejo del ganado porcino.
El abordaje de la anestesia y analgesia en el momento de la castración no puede hacerse sin una comprensión clara de los conceptos de nocicepción y dolor. La nocicepción hace referencia al procesamiento por parte del sistema nervioso periférico y central (SNC) de la información sobre el entorno interno o externo, generada por la activación de los nociceptores. Por otro lado, según la International Association for the Study of Pain (IASP), el dolor es una experiencia sensorial y emocional desagradable asociada con, o similar a la asociada con, daño tisular real o potencial. Se trata siempre una experiencia individual que puede tener efectos adversos en la fisiología y en el bienestar del individuo (Raja et al., 2020).
ACTUALMENTE, TAN SOLO DOS PAÍSES EUROPEOS, ALEMANIA Y FRANCIA, HAN FIJADO COMO FECHA PARA EL FIN DE LA CASTRACIÓNFIGURA 1 Castración de los lechones Personal cualificado
activa los nociceptores presentes en las estructuras periféricas, transmitiéndose la información al asta dorsal de la médula espinal o a su homólogo del trigémino, el núcleo caudal. Desde allí, la información continua hacia el tronco cerebral y, en última instancia, hacia la corteza cerebral, donde se produce la percepción del dolor.
La evaluación de la presencia de dolor es fundamental para poder garantizar el bienestar animal. Para ello, existe una serie de indicadores fisiológicos y comportamentales (Mellor et al., 2000; Prunier et al., 2002 y Hay et al., 2003):
INDICADORES FISIOLÓGICOS
Concentración de hormonas en sangre, saliva u orina: ACTH, cortisol, adrenalina, noradrenalina
Metabolitos en sangre: glucosa, lactosa, ácidos grasos libres
Concentración de marcadores de la inflamación (haptoglobina, fibrinógeno, IL-1, etc.
Actividad del sistema nervioso
autónomo: frecuencia cardíaca y respiratoria, presión arterial, temperatura corporal, dilatación pupilar, sudoración, conductividad cutánea, temblor muscular
INDICADORES COMPORTAMENTALES
Vocalizaciones: cantidad y duración, intensidad, características del espectrograma
Posturas
Expresiones faciales
Comportamientos: lamido frecuente, arañar, frotar, conducta evasiva, inmovilidad tónica, falta o exceso de movimiento, agresividad, agitación o ausencia de actividad, postración, aislamiento, pérdida de apetito, etc.
FIGURA 2 Fisiología del dolor – transformación de un estímulo nocivo en una experiencia dolorosa. El estímulo nocivo Médula espinal Corteza cerebral Médula espinalLa prevención y/o tratamiento del dolor en los cerdos en las granjas porcinas debe hacerse no solo por cuestiones legales de cumplimiento de la normativa vigente, sino también por cuestiones éticas y de bienestar animal. Por todo ello, se hace necesario implementar correctamente las técnicas de anestesia y analgesia dentro de las prácticas quirúrgicas que se realizan rutinariamente.
El dolor no tratado en los cerdos puede tener diversas consecuencias para el animal como alteraciones en el comportamiento, en su fisiología o en la propia percepción del dolor

IMAGEN 1
Comportamiento de amamantamiento normal en lechones de 5-6 días.
En el caso de la castración, se ha observado que la respuesta al dolor perdura en el tiempo (hasta 4-6 días post-castración), provocando retraso en la recuperación, disminución de la ingestión de agua y alimento, alteración de la capacidad de respuesta inmunitaria, hipersensibilidad y mayor estrés al asociar el manejo al dolor agudo. Los productos anestésicos tienen una gran utilidad a la hora de llevar a cabo prácticas que ocasionen dolor. Sin embargo, es importante tener en cuenta una serie de condicionantes, como las limitaciones económicas y el tiempo de trabajo del veterinario.
Además, debemos recordar que en los animales destinados a
consumo humano es imprescindible conocer y respectar periodos de supresión y los límites de residuos máximos (LRM) permitidos por la legislación vigente.
Por otro lado, existe un escaso número de anestésicos y analgésicos aprobados para su uso en porcino, siendo imprescindible conocer y aplicar la prescripción en cascada.
A la hora de elegir un protocolo anestésico, es importante que sea rápido, económico, efectivo, seguro y de rápida recuperación.
Además, se deben tener en cuenta dos aspectos:
1
El tipo de cirugía que hay que realizar: castración del macho mediante orquidectomía o de la hembra mediante ovariectomía.
2
La edad y tamaño del animal, que condicionará una mayor o menor necesidad de contención física.
Cuando se trata de lechones muy jóvenes es importante conseguir una recuperación anestésica rápida tras el procedimiento para que recuperen cuanto antes su fisiología y comportamientos naturales y se minimice el riesgo de aplastamiento por parte de la madre (Imagen 1).
Las técnicas que pueden ser de utilidad en condiciones de granja para realizar la castración del cerdo incluyen:
A Uso de anestesia inyectable
B Uso de técnicas de anestesia locorregional
C Uso de agentes anestésicos inhalatorios (en algunos países).
La anestesia general inyectable resulta muy adecuada para la realización de sedaciones o anestesias en la granja, ya que en ellas se precisa de un equipamiento mínimo. Pero puede resultar costosa en tiempo de aplicación y recursos económicos dependiendo del número de animales a tratar.
La anestesia general inyectable es necesaria para inmovilizar y facilitar el manejo en la castración en el caso de lechones fuera del periodo neonatal (de más edad o peso) y de verracos (Anderson y St. Jean, 2012).
En las técnicas de anestesia inyectable suelen combinarse diferentes productos:
Agonistas α 2: xilacina, medetomidina
Anestésicos disociativos: tiletamina, ketamina
Tranquilizantes: azaperona, zolacepam, midazolam, etc.
Analgésicos opioides: butorfanol
Antiinflamatorios no esteroideos: meloxicam, ácido tolfenámico, etc.
AZAPERONA
La azaperona se emplea como tranquilizante/sedante, pero NO propociona analgesia.
Se aplica a una dosis de 1-3 mg/kg IM (tranquilización moderada) a 5-8 mg/kg IM (tranquilización profunda), con una duración de 60-120 min y un tiempo de latencia de 5-15 min.
La combinación de tiletamina (agente disociativo) y una benzodiacepina (zolacepam) ofrece una pobre analgesia , con una posible recuperación excitada, depresión cardiaca, hipotermia y aparición de movimientos involuntarios (temblores).
Se aplica a una dosis de 4-10 mg/kg IM, con una duración de 20-30 min y un tiempo de latencia de 2-5 min.
La combinación de medetomidina y xilacina produce tranquilización, analgesia y buena relajación muscular, aunque puede provocar depresión cardiovascular.
Se aplica a una dosis de 30-80 µg/kg IM medetomidina y 0,5-3 mg/kg IM xilacina, con una duración de 30-60 min y un tiempo de latencia de 1-5 min.
La combinación de medetomidina + xilacina con tiletamina-zolacepam proporciona una analgesia profunda y buena relajación muscular, por lo que se evita la aparición de temblores y excitación.
En la Tabla 1 se resumen algunas de las posibles combinaciones de fármacos anestésicos que se pueden usar para realizar una sedación o una anestesia general para una castración en porcino.
Posibles combinaciones anestésicas inyectables usadas en castración en porcino (Lin y Walz, 2014).
Protocolos anestésicos inyectables Anestesia Locorregional Analgesia Prolongada
Castración en lechones
Castración en cerdos jóvenes y verracos
Castración de hembras ibéricas extensivo (RD 1221/2009)
Tiletamina/zolacepam 6-10 mg/kg
Tiletamina/zolacepam 4 mg/kg + medetomidina 0,03 mg/kg IM
Ketamina 20 mg/kg + xilacina 2 mg/kg IM
Medetomidina 0,08 mg/kg + ketamina 10 mg/kg + butorfanol 0,2 mg/kg IM
Azaperona 2 mg/kg + xilacina 0,2 mg/kg + ketamina 2 mg/kg
Ketamina 20 mg/kg + xilacina 2 mg/kg + butorfanol 0,2 mg/kg IM
Bloqueo intratesticular con lidocaína 2%
Bloqueo intratesticular con lidocaína 2%
Meloxicam (0,4 mg/kg IM)
Meloxicam (0,4 mg/kg IM)
Infiltración de la línea de incisión con lidocaína al 2%
Meloxicam (0,4 mg/kg IM)
Las técnicas de anestesia locorregional como el bloqueo intratesticular (Imagen 2) y en menor medida la infiltración del cordón espermático (Haga y Ranheim, 2005), son quizá la mejor opción para realizar la castración de lechones jóvenes.
En el caso de lechones de más edad o verracos, por cuestiones de manejo, el bloqueo intratesticular debe ir precedido de una sedación profunda o de una anestesia general que permita una buena contención del animal.

El anestésico local más frecuentemente utilizado en porcino es la lidocaína. Generalmente se utiliza en solución inyectable al 2% o combinado con adrenalina (1:200.000) para potenciar la duración de su efecto.
La lidocaína presenta un tiempo de latencia de aproximadamente 5-10 min y la duración de su efecto es como máximo de 2 horas (Lin y Walz, 2014; Malavasi, 2015)
IMAGEN
2La castración de hembras solosepermiteenel porcino de extensivo.
En estos casos es imprescindible el uso de una anestesia general que permita una buena contención farmacológica delanimalyqueproporcione buena analgesia y relajación muscular.
En estas intervenciones también puede ser de utilidad la infiltración de la línea de incisión con un anestésico local como la lidocaína al 2%, así como la administración de meloxicam 20-30 minutos.
La administración de analgesia prolongada es otra parte del procedimiento anestésico que se debe llevar a cabo. En la castración de los lechones macho es frecuente el uso de antiinflamatorios no esteroideos (AINEs) como meloxicam (Imagen 3) o diclofenaco para el tratamiento del dolor perioperatorio en el cerdo (Bonastre et al., 2016).
Los AINEs, además de proporcionar un efecto analgésico prolongado de unas 24 horas, son también agentes antiinflamatorios y tienen efecto antipirético (Malavasi, 2015).
IMAGEN 3
Administración de meloxicam intramuscular como analgesia prolongada.
Actualmente, las opciones más empleadas como alternativa a la castración quirúrgica en lechones son:
1 2
La producción de machos enteros que se sacrifican antes de que alcancen la pubertad
La inmunocastración o inmunización activa frente a la hormona liberadora de gonadotropinas (GnRH).
Por otra parte, otras opciones como el sexaje del semen para la selección y cría de hembras o la más novedosa técnica de edición génica para mantener de forma indefinida a los machos en un estado prepuberal podrían ser una opción factible quizá en un futuro no muy lejano (EFSA, 2004; Fredriksen et al., 2009; von Borell et al., 2009; Yang y Wu, 2018).
Anderson DE, St. Jean G. Cap. 10: “Anesthesia and Surgical Procedures in Swine” en Diseases of Swine. Wiley- Blackwell, 10th Edition, 2012.
Bonastre C, Mitjana O, Tejedor MT, Calavia M, Yuste AG, Úbeda JL et al. Acute physiological responses to castration-related pain in piglets: the effect of two local anesthetics with or without meloxicam. Animal 2016;10(9):1474-81.
CASTRUM consortium (2016): Pig castration: methods of anaesthesia and analgesia for all pigs and other alternatives for pigs used in traditional products. Disponible en: https://op.europa.eu/en/publication-detail/-/publication/5fe8db00-dbb8-11e6-ad7c-01aa75ed71a1 (último acceso el 26-Octubre- 2020). DOI 10.2875/057159.
EFSA. Welfare aspects of the castration of piglets. The EFSA Journal, 2004; 91: 1-18.

Fredriksen B, Font i Furnols M, Lundström K, Migdal W, Prunier A, Tuyttens FAM, Bonneau M. Practice on castration of piglets in Europe. Animal, 2009; 3(11):1480–1487.
Fredriksen B, Johnsen AM, Skuterud E. Consumer attitudes towards castration of piglets and alternatives to surgical castration. Res Vet Sci, 2011; 90(2): 352-7.
Haga HA, Ranheim B. Castration of piglets: the analgesic effects of intratesticular and intrafunicular lidocaine injection. Vet Anaesth Analg 2005; 32(1):1-9.
Lin H, Walz P, eds. Farm Animal Anesthesia: Cattle, Small Ruminants, Camelids, and Pigs, 1st edn. , 2014.
Malavasi LM. Swine. In: Tranquili WJ, Thurmon JC, Grimm KA, eds. Lumb and Jones’ Veterinary Anesthesia and Analgesia, 5th edn. Ames, IA:
Blackwell Publishing, 2015; 928–940.
Raja SN, Carr DB, Cohen M, Finnerup NB, Flor H et al. The revised International Association for the Study of Pain definition of pain: concepts, challenges, and compromisos. Pain, 2020; 161(9): 1976-1982.
Real Decreto 1221/2009 de 17 de Julio, relativo a las normas mínimas para la protección de los cerdos. Real Decreto 1135/2002 de 31 de Octubre, por el que se establecen normas básicas de ordenación de las explotaciones de ganado porcino extensivo.
von Borell E, Baumgartner J, Giersing M, Jäggin N, Prunier A, Tuyttens FA, Edwards SA. Animal welfare implications of surgical castration and its alternatives in pigs. Animal, 2009; 3(11):1488-96.
Yang H, Wu Z. Genome Editing of Pigs for Agriculture and Biomedicine. Front Genet. 2018; 9: 360.


CCCystoisospora suis (C. suis) es un patógeno muy común en lechones lactantes de todo el mundo. Los lechones se infectan por ingestión de ooquistes esporulados y los esporozoítos liberados penetran en los enterocitos del intestino delgado, destruyéndolo y provocando diarrea no hemorrágica. Como resultado, los lechones presentan retraso en el crecimiento. El cuadro clínico puede verse agravado debido a coinfecciones con otros patógenos víricos o bacterianos, dando lugar a grandes pérdidas económicas.

La reducción o inactivación de los ooquistes es un factor clave para prevenir la enfermedad en los lechones a edades tempranas.
En este sentido, los sistemas de limpieza con vapor y el uso de desinfectantes con actividad frente a este parásito han demostrado ser estrategias eficaces (Straberg and
2007).
En las granjas donde se han detectado diarreas causadas por coccidios, se recomienda el tratamiento metafiláctico con toltrazurilo. Sin embargo, este tratamiento debe ser aplicado en los lechones antes de la excreción de los ooquistes en las heces, es decir, antes de que se puedan detectar mediante análisis coprológico.
Salvador Oliver, Sonia Cárceles, Laura Garza, Carlos Casanovas y David Espigares-Servicio Técnico Porcino. Ceva Salud Animal
Daugschies, FIGURA 1 Cistoisospora suis. Parásito intracelular perteneciente a la familia Eimeridae que infecta a las células epiteliales intestinales, causando diarrea no hemorrágica en lechones.1 2
Los objetivos de este estudio fueron:
Evaluar la prevalencia de C. suis en granjas porcinas convencionales con diferentes condiciones de manejo en cuatro países europeos (Austria, Alemania, República Checa y España).
Evaluar la asociación entre presencia de C. suis y las estrategias de manejo y tratamiento de la infección, en particular, con el tratamiento con toltrazurilo.
En 2018, se muestrearon 49 granjas de cuatro países diferentes seleccionadas arbitrariamente:
Austria: 7 granjas
República Checa: 17 granjas
Alemania: 7 granjas
España: 18 granjas
De cada granja, se tomaron 4 muestras por camada de heces de lechón recogidas del suelo y se procesaron manteniendo los pools por camada.
El objetivo fue tomar muestras de al menos el 10% de las camadas nacidas durante el período de estudio y, como máximo, 30 camadas por granja.
Debido a que los ooquistes se excretan durante cortos periodos de tiempo, se tomaron muestras de cada camada dos veces, en la segunda y tercera semana de vida, con el objetivo de aumentar la sensibilidad del análisis coprológico (Joachim et al., 2018).
También se evaluó la consistencia de las heces puntuándolas de 1 a 4, donde 3 y 4 se consideraron heces diarreicas.
Con respecto a los análisis coprológicos, se examinaron por autofluorescencia 0,1-0,2g de heces de cada muestra homogeneizada según lo descrito por Joachim y col. (2018), considerándose una muestra como positiva si al menos se detectaba un ooquiste.
Por otro lado, se realizó una encuesta dirigida al veterinario de cada granja para obtener información sobre la estructura y el manejo de la granja, así como de la medicación de los lechones durante el periodo de lactación y del historial de diarreas de la granja.

El tamaño de las granjas incluidas en el estudio varió entre 65-10.000 cerdas por granja. En Austria, solo se examinaron las granjas con un máximo de 200 cerdas, mientras que en los otros países también se incluyeron las granjas con más de 2.000 cerdas (Tabla 1).
En total, el 71,4% de las granjas y el 50,1% de las camadas muestreadas fueron positivas a C. suis al menos en uno de los muestreos. Sin embargo, la prevalencia de C. suis entre las granjas varió entre el 0 y el 100%.
En las granjas alemanas se observó el nivel más bajo de infección por C. suis, mientras que en España se observó el más alto, mostrando prevalencias en granja significativamente más altas que en los demás países (Austria: P=0,006, República Checa: P = 0,011, Alemania: P = 0,009).

En España, dos tercios de las granjas positivas a C. suis tenían más del 50% de las camadas infectadas, mientras que, en los demás países, solo se detectó menos de una quinta parte de granjas con el 50% de camadas infectadas (Tabla 1).
Sin embargo, se debe tener en cuenta que en España se tomó un mayor número de muestras en comparación al resto de países.
EN 2/3 DE LAS GRANJAS POSITIVAS
EL 71,4% DE LAS GRANJAS Y EL 50,1% DE LAS CAMADAS MUESTREADAS FUERON POSITIVAS A C.SUIS, TENIENDO ESPAÑA MÁS DEL 50% DE LAS CAMADAS INFECTADAS
Curiosamente, las granjas de tamaño medio (1.000-1.500 cerdas) fueron las que tenían las tasas de infección más altas. Con los datos recopilados en el cuestionario no se pudo detectar ningún factor explicativo para esta observación.

El hecho de que las granjas de tamaño medio estaban ubicadas principalmente en España también podría enmascarar la verdadera razón de las mayores tasas de infección en este subgrupo.
En contraposición, las granjas con cebaderos tenían menos infecciones por C. suis que las formadas solamente por fase I (o fase I + II). De nuevo, las granjas sin fase III muestreadas fueron principalmente explotaciones de tamaño medio y ubicadas en España.
Por lo tanto, es difícil concluir si la mayor tasa de infección por C. suis es debida al tamaño de la granja, al país o si se debe a otros factores desconocidos.
PREVALENCIA DE C. SUIS VS PROTOCOLO DE DESINFECCIÓN
PREVALENCIA DE C. SUIS VS PROTOCOLO DE DESINFECCIÓN
En cuanto a la desinfección, el 80,9% de las granjas proporcionaron información sobre los productos utilizados.
Sin embargo, solo dos granjas aplicaban desinfectantes (a base de cresol) considerados como efectivos contra los coccidios y en estas granjas no se detectaron ooquistes en heces.
PREVALENCIA DE C. SUIS VS TRATAMIENTO TOLTRAZURILO
PREVALENCIA DE C. SUIS VS TRATAMIENTO TOLTRAZURILO
De las 49 granjas muestreadas, 30 trataban a los lechones con toltrazurilo. El 66,7% de estas granjas fueron positivas a C. suis y en el 53,3% de ellas se detectaron diarreas.
En las 19 granjas en las que no se trataba con Toltrazurilo, el 79% fueron positivas a C. suis y en el 52,6% se detectaron diarreas.
A pesar de la aplicación de toltrazurilo, sorprendentemente no se observó una reducción significativa ni en la incidencia de diarreas ni en la infección por C. suis respecto a las granjas no tratadas, hecho que contrasta con previos estudios experimentales y de campo (Mundt et al., 2007; Kreiner et al., 2011). Posiblemente esto sea debido a una incorrecta aplicación del tratamiento a los lechones y a una higiene ineficaz contra el parásito.
UNA HIGIENE INEFICAZ
Aunque no se trata de un número significativo de granjas, la desinfección con productos con actividad anticoccidial es altamente recomendada, ya que permite disminuir la presión de infección en las salas de parto.
De las granjas que trataban con toltrazurilo, nueve informaron que el tratamiento se aplicaba de forma temprana (antes del tercer día de vida), diez informaron que se suministraba de forma tardía (después del tercer día de vida) y siete, entre temprana y tardía.
Todas las granjas con tratamiento tardío fueron positivas a C. suis, mientras que en las granjas en las que se aplicaba el toltrazurilo de forma temprana se obtuvieron mejores resultados (57,1% de granjas positivas). Este hecho concuerda con estudios previos en condiciones de campo (Mengel et al., 2012).
La evaluación de la consistencia de las heces de las muestras reveló que el 5,1% de las muestras tenían consistencia líquida y el 48% tenía consistencia pastosa. Se observó que las muestras con consistencia pastosa estaban significativamente relacionadas con la excreción de un gran número de ooquistes (P = 0,005), mientras que las heces líquidas no lo estaban. Esta diferencia puede ser debida a que el pico de excreción de ooquistes no suele coincidir con la aparición de la diarrea.
En este sentido, fue importante tomar muestras de las camadas dos veces, ya que, aunque el porcentaje de camadas positivas fue similar entre los dos muestreos (43,6% y 45,8%, en la semana dos y tres de vida, respectivamente), las camadas positivas fueron distintas entre muestreos, lo que permitió mejorar la sensibilidad del diagnóstico.
En base a estos resultados, podemos concluir que la infección por C. suis continúa siendo un problema en las explotaciones porcinas, principalmente en los lechones procedentes de granjas de tamaño medio.
UN CORRECTO DIAGNÓSTICO COPROLÓGICO DE LA INFECCIÓN EN BASE A MUESTREOS CONSECUTIVOS, UNA CORRECTA ADMINISTRACIÓN DE TOLTRAZURILO Y UNA ADECUADA
LIMPIEZA Y DESINFECCIÓN DE LA SALA DE PARTOS PUEDE SER DE GRAN AYUDA PARA EL CONTROL DE LA COCCIDIOSIS
Artículoadaptadode:CystoisosporasuiscontrolinEuropeisnotalwayseffective(2020).Hinney,B.,Cvjetkovic,V.,Espigares,D.,Vanhara,J.,Waehner,C., Ruttkowski,B,Selista,R.,Sèrñomg,D.,Joachim,A.Front.Vet.Sci.7:113.doi:10.3389/fvets.2020.00113
Joachim A, Ruttkowski B, Sperling D. Detection of Cystoisospora suis in faeces of suckling piglets - when and how?
A comparison of methods. Porcine Health Manag. (2018)
4:20. doi: 10.1186/s40813-018- 0097-2
Kreiner T, Worliczek HL, Tichy A, Joachim A. Influence of toltrazuril treatment on parasitological parameters and health performance of piglets in the field–an Austrian experience. Vet Parasitol. (2011) 183:14–20. doi: 10.1016/j. vetpar.2011.07.019
Mengel H, Krüger M, Krüger MU, Westphal B, Swidsinski A, Schwarz S, et al. Necrotic enteritis due to simultaneous infection with Isospora suis and clostridia in newborn piglets and its prevention by early treatment with toltrazuril. Parasitol Res. (2012) 110:1347–55. doi: 10.1007/s00436-011- 2633-8
Mundt HC, Mundt-Wüstenberg S, Daugschies A, Joachim A. Efficacy of various anticoccidials against experimental porcine neonatal isosporosis. Parasitol Res. (2007) 100:401–11. doi: 10.1007/s00436-006-0314-9
Straberg E, Daugschies A. Control of piglet coccidiosis by chemical disinfection with a cresol-based product (Neopredisan 135-1). Parasitol Res. (2007) 101:599–604. doi: 10.1007/s00436-007-0521-z



Descarga el PDF
Desde hace tiempo, se sabe que los lechones recién nacidos a veces sufren una aparente debilidad de las patas traseras, abriéndose éstas hacia los lados, y en los casos más graves, las extremidades delanteras también se ven afectadas. Esto perjudica su capacidad para ponerse de pie
y caminar, además de aumentar el riesgo de aplastamientos. Por lo demás, los lechones son en su mayoría viables y los que sobreviven no se diferencian de sus compañeros de camada sanos al cabo de unos días. En la Imagen 1 se muestra un lechón típico con Splay leg
Toni Schumacher, Monika Röntgen y Steffen Maak, Instituto de biología y crecimiento muscular, Instituto Leibniz de biología de animales de granja (fbn), Dummerstorf, Alemania
IMAGEN 1
 Fenotipo típico de un lechón con Splay leg (Schumacher et al. 2021)
Fenotipo típico de un lechón con Splay leg (Schumacher et al. 2021)
Thurley et al. describieron el síndrome Splay leg por primera vez en la literatura científica en 1967. Dedujeron que existe un componente hereditario y acuñaron el nombre aún vigente de Splayleg congénito de los lechones para el síndrome. El síndrome Splay leg congénito porcino se abrevia como PCS (del inglés, Porcine Congenital Splay leg syndrome).
Un análisis histológico posterior de varios músculos de diez lechones afectados reveló que el número de miofibrillas estaba reducido en distinto grado en las fibras musculares de los lechones con Splay leg congénito. Esto llevó a los autores a afirmar que el síndrome se caracteriza por una hipoplasia miofibrilar.
En los primeros estudios sobre la incidencia del Splay leg congénito porcino en Alemania del Este, se informó de una proporción de hasta 1/3 de todos los lechones nacidos vivos (Maas & Schulze 1979). Informes posteriores de diferentes países con producción porcina intensiva coincidieron en que normalmente menos del 1% de todos los lechones nacidos vivos podrían estar afectados, con aumentos esporádicos hasta el 8% y más (revisado por Papatsiros, 2012). No obstante, el Splay leg congénito se considera el trastorno hereditario más frecuente en el ganado porcino, siendo responsable de hasta el 45% de todos los defectos congénitos observados.
Hay consenso en que algunas razas parecen ser más propensas al síndrome. En este sentido, las camadas de cerdas Landrace se ven afectadas con más frecuencia que las de otras razas, como Yorkshire/ Large White, Duroc o Pietrain.
En algunos estudios se ha encontrado una relación entre el sexo, el tamaño de la camada, el peso al nacimiento de los lechones y la aparición del Splay leg congénito, aunque estas observaciones no se han confirmado sistemáticamente:
Los lechones macho se ven afectados con mayor frecuencia que las hembras (proporción de 1,7 a 2,1) por el Splay leg congénito.
El Splay leg congénito es más común en camadas grandes y el bajo peso al nacimiento conlleva un mayor riesgo de aparición de este síndrome.
Sin embargo, subrayaron que la hipoplasia miofibrilar tiene una variación continua, mientras que el síndrome es un fenómeno de "todo o nada", es decir, el lechón es capaz de mantenerse en pie o no.
Debido a su elevada incidencia, el síndrome Splay leg ha sido la segunda causa más común de mortalidad global en lechones (hasta un 20%) en estudios recientes con unas pérdidas que oscilan entre el 15% y el 50% de los lechones afectados. Por tanto, la importancia de esta enfermedad, por su impacto económico y su efecto negativo en el bienestar y la salud de los animales, es considerable y no debe subestimarse.
No existe ningún tratamiento médico para el Splay leg congénito. Sin embargo, un método de tratamiento muy extendido es amarrar las extremidades traseras con cintas disponibles en el mercado durante los primeros días tras el nacimiento. Esto mejora la movilidad general del lechón y garantiza una nutrición adecuada al poder acceder a los pezones de la cerda.
Este procedimiento, sencillo pero laborioso, aumenta considerablemente las posibilidades de supervivencia de los lechones afectados. En los lechones menos afectados, el proceso suele ser autolimitante, produciéndose la curación en pocos días y los lechones recuperados no se diferencian de sus compañeros de camada sanos durante el resto de su vida.
HISTOLOGÍA DE LOS MÚSCULOS SPLAY LEG
El estudio de las características estructurales y funcionales del músculo esquelético afectado dominó las investigaciones durante las primeras décadas que siguieron a la descripción inicial del Splay leg congénito. Varios estudios confirmaron el deterioro de la estructura muscular señalado inicialmente por Thurley et al. (1967) No obstante, hay que tener en cuenta que la hipoplasia miofibrilar es bastante común en los lechones recién nacidos, por lo que no se puede relacionar exclusivamente con el Splay leg (revisado por Papatsiros, 2012).
Numerosas investigaciones anteriores también han mostrado resultados contradictorios (revisado por Schumacher et al. 2021), pero actualmente se acepta que un mayor número de miofibrillas más pequeñas y menos maduras es característico de los lechones con Splay leg congénito. Sin embargo, estos cambios se expresan en distinta medida en diferentes músculos, lo que dificulta el diagnóstico de síndrome basado únicamente en la histopatología en muchos casos.
MÁS PEQUEÑAS
CON SPLAY LEG
CONGÉNITO

Los principales hallazgos a nivel ultraestructural del músculo esquelético son discos Z y filamentos mal formados que conducen a sarcómeros alterados, ensamblaje defectuoso de miofilamentos, dilatación del retículo sarcoplásmico y mitocondrias atípicas.
Además, en las muestras de músculo de los lechones con Splay leg congénito se observa un mayor número de gotas lipídicas y acumulación granular de glucógeno.
Aun así, a veces también se observan cambios similares en los músculos de los lechones fenotípicamente normales y el grado de los cambios ultraestructurales varía en gran medida en los lechones con Splay leg congénito.
En lo que respecta al perfil bioquímico del síndrome Splay leg, hay referencias a una serie de análisis bioquímicos de suero y tejidos homogeneizados. Aunque no se dispone de resultados concluyentes, algunos autores han descrito un aumento de los niveles séricos de enzimas específicas del músculo en consonancia con los cambios atróficos observados. Sin embargo, los datos inconsistentes sugerían que el Splay leg congénito era diferente de todas las miopatías descritas en otras especies.
Otras investigaciones han señalado que la síntesis y degradación de la acetilcolina están alteradas en los lechones Splay leg y que una probable desorganización de la inervación muscular podría estar implicada, al menos parcialmente, en la expresión de los signos clínicos.
Esto ha sido apoyado por un único estudio que mostraba un deterioro de la maduración de las células de Schwann, conduciendo a un revestimiento de mielina ineficaz y a la subsiguiente alteración de la inervación muscular (Szalay et al. 2001).
FIGURA 1
Características ultraestructurales del músculo esquelético de lechones con Splay leg congénito.
EN RESUMEN, MUCHOS RESULTADOS APUNTAN A UNA MADURACIÓN
INCOMPLETA DEL SISTEMA
NEUROMUSCULAR EN LOS LECHONES CON SPLAY LEG CONGÉNITO AL NACIMIENTO, PERO NINGÚN PARÁMETRO INVESTIGADO
HASTA AHORA PARECE SER EXCLUSIVO DEL SÍNDROME
Músculo Fibra muscularComo se ha mencionado anteriormente, la primera descripción del Splay leg congénito ya incluía la presunción de un componente hereditario (Thurley et al. 1967).
Más tarde, se postuló una herencia cromosómica sexual, pero se basó sólo en unas pocas observaciones (Lax et al. 1971). Esto no se ha confirmado en estudios posteriores (Sellier & Ollivier 1982, Stigler et al. 1991), sino que se ha propuesto una herencia oligo- o incluso poligénica con la participación de factores ambientales umbral.
El papel de varios factores ambientales ha sido motivo de debate. Los estudios observacionales según los cuales el suministro de colina de la cerda, las micotoxinas, el suelo de la paridera, el parto inducido e incluso las infecciones (por ejemplo, el virus del PRRS) influyen en gran medida en la aparición de lechones Splay leg no han podido ser confirmados en su mayoría o parcialmente por estudios posteriores más sistemáticos.
No obstante, es probable que uno o varios de los factores mencionados tengan un fuerte efecto modificador sobre la incidencia y/o la gravedad del síndrome. En la Figura 2 se ofrece una visión general de todos los factores analizados.
FIGURA 2
Resumen de los factores extrínsecos e intrínsecos señalados como factores causales y/o moduladores Splay leg congénito porcino.
FACTORES DE RIESGO EXTRÍNSECOS
Malnutrición de la cerda
Enfermedades infecciosas
Tipo de suelo
Parto inducido
FACTORES DE RIESGO INTRÍNSECOS
Riesgo asociado a la raza
Predisposición genética
Sexo
Tamaño de camada
DE LECHONES SANOS Y CON SPLAY LEG CONGÉNITO
Los primeros abordajes de genética molecular de nuestro grupo incluyeron la identificación de marcadores expresados en el transcriptoma muscular de los lechones Splay leg . Esto debería proporcionar la base para identificar posibles genes candidatos, pero posteriores análisis de estos candidatos no pudieron establecer un vínculo sistemático con el síndrome.
Análisis más específicos han sido posibles gracias al mayor conocimiento del genoma y el transcriptoma porcino. Así, como no estaba claro si la hipoplasia miofibrilar observada era el resultado de un retraso en el crecimiento y la diferenciación muscular o de la atrofia muscular, Ooi et al. (2006) investigaron las proteínas estructurales y los marcadores de atrofia.
El marcador de atrofia FBXO32 (proteína F-box 32, antes MAFbx) se encontró significativamente sobreexpresado junto con una expresión claramente disminuida de la proteína P311, aún desconocida e identificada posteriormente como regulador de transdiferenciación NREP implicado en la diferenciación celular.
Aun así, la cuestión de si la atrofia muscular era causa o efecto del deterioro de la maduración muscular seguía sin respuesta y la expresión diferencial de FBXO32 y P311 no pudo confirmarse en nuestro estudio de seguimiento.
Con la disponibilidad de herramientas para el análisis global de los transcriptomas, se han realizado estudios de microarrays y secuenciación de ARN (Maak et al. 2009; Wu et al. 2018). Estas investigaciones revelaron varios genes candidatos potenciales que, en su mayoría, están pendientes de una mayor exploración.
Curiosamente, Wu et al. encontraron de nuevo el marcador FBXO32 sobreexpresado en su conjunto de genes, confirmando así los resultados de Ooi et al. (2006).
L os análisis del transcriptoma tienen la desventaja inherente de proporcionar una imagen instantánea del transcriptoma altamente variable en el momento del muestreo, lo que hace que las comparaciones entre diferentes experimentos sean complicadas debido a que los protocolos de muestreo suelen ser diferentes.
Los primeros intentos de mapear la variación genética vinculada al Splay leg congénito se vieron obstaculizados por la baja cantidad de marcadores y los enormes intervalos de confianza resultantes. En consecuencia, los análisis iniciales sólo revelaron dos intervalos sugestivos de QTL (loci de caracteres cuantitativos) en una familia de referencia en los cromosomas porcinos (SSC) 5 y 11 que contenían un total de 11 genes candidatos conocidos hasta el momento.
Por el contrario, un enfoque reciente basado en un array de SNPs (polimorfismo de un solo nucleótido) de genoma completo encontró regiones relacionadas de forma significativa con el Splay leg congénito en cuatro cromosomas (SSC1, 2, 7, 15, 16), pero no en los cromosomas SSC5 o SSC11 mencionados anteriormente (Hao et al. 2018).
Entre los SNPs mapeados en regiones entre genes, dos se localizan cerca y dentro del gen de la proteína HOMER1 (homer scaffold protein 1) en el SSC2 , un gen previamente vinculado a procesos relacionados con el músculo.
En un estudio de seguimiento, Xu et al. (2018) analizaron HOMER1 en detalle en la misma población e identificaron un total de 21 SNPs. Doce de los SNPs se asociaron significativamente con el Splay leg congénito, lo que convierte a HOMER1 en un candidato prometedor para este síndrome.
HOMER1
COMO MARCADOR DE SPLAY LEG CONGÉNITO
En un enfoque completamente diferente, se realizó un cribado de mutagénesis con ENU (N-etil-N-nitrosourea) a gran escala en cerdos y se generaron más de 100 familias con rasgos heredados de forma dominante o recesiva (Hai et al. 2017).






FIGURA 3
Estudios
En una familia, se observó un fenotipo de paresia de las extremidades traseras que se asemeja al Splay leg congénito. El mapeo intrafamiliar de la variación subyacente a este fenotipo reveló una región de 1 Mb en el SSC4 que abarca 18 genes, entre ellos el previamente identificado FBXO32. Los análisis posteriores mostraron un aumento de la expresión del ARNm y la proteína de FBXO32 en tres lechones con Splay leg congénito en comparación con tres controles.
EL AUMENTO DE LA EXPRESIÓN DEL GEN FBXO32 PODRÍA RELACIONARSE CON EL SPLAY LEG CONGÉNITO
QTL Array de SNPs Cribado de mutagénesis con ENU
11 genes candidatos
HOMER1 (12 SNPs asociados a Splay leg congénito) FBXO32
A pesar de que el Splay leg congénito porcino fue descrito por primera vez hace más de cinco décadas, los conocimientos consolidados sobre la patogénesis y los factores genéticos causales siguen siendo escasos. Esto es sorprendente si se tiene en cuenta la alta incidencia relativa de lechones afectados y las pérdidas económicas resultantes. Hay consenso en que el Splay leg congénito es una enfermedad claramente distinta de otras enfermedades relacionadas con el músculo en cualquier otra especie y que tiene un fuerte trasfondo hereditario. Varias líneas de investigación apuntan a la atrofia muscular y/o al retraso en la maduración del sistema muscular al nacimiento como características del Splay leg congénito. El componente genético y la naturaleza transitoria de la enfermedad podrían ser responsables de la incidencia estable a lo largo de décadas, ya que es probable que al menos algunos lechones totalmente recuperados del síndrome se utilicen para la reproducción de la siguiente generación.
Los enfoques genéticos moleculares aún no han logrado identificar del todo los loci causales del Splay leg congénito. Sin embargo, ahora hay dos genes candidatos prometedores sobre la mesa.
La sobreexpresión de FBXO32 en el músculo esquelético de los lechones con Splay leg congénito ha sido señalada hasta ahora por tres grupos independientes. La base genómica de esta desregulación aún está por dilucidar.
Se ha demostrado que HOMER1 contiene SNPs relacionados de manera significativa con el Splay leg congénito. Los análisis funcionales posteriores han demostrado que algunos de estos SNPs tienen consecuencias en la expresión de las isoformas de este gen.
Schumacher T, Röntgen M, Maak S. Congenital splay leg syndrome in piglets—current knowledge and a new approach to etiology. Front. Vet. Sci. 2021; 8:609883.
Thurley DC, Gilbert FR, Done JT. Congenital splayleg of piglets-myofibrillar hypoplasia. Vet Rec. 1967; 80:302-304.
Maass D, Schulze J. Zur genetischen Disposition des angeborenen Beinspreizens bei Saugferkeln. Mh Vet Med (1979) 34:20–2.
Lax T. Hereditary splayleg in pigs. J Hered (1971) 62:250–252.
Stigler J, Distl O, Kruff B, Kräusslich H. Segregationsanalyse von Erbfehlern beim Schwein. Züchtungskunde (1991) 63:294–305.
Sellier P, Ollivier O. Etude genetique du syndrome de l’
abduction des membres (splayleg) chez le porcelet nouveau-ne. Modele multifactoriel a un seuil. Ann Genet Selec Anim. 1982 14:77-92.
Ooi PT, Da Costa N, Edgar J, Chang KC. Porcine congenital splayleg is characterised by muscle fibre atrophy associated with relative rise in MAFbx and fall in P311 expression. BMC Vet Res (2006) 2:23.
Szalay F, Zsarnovszky A, Fekete S, Hullár I, Jancsik V, Hajós F. Retarded myelination in the lumbar spinal cord of piglets born with spread-leg syndrome. Anat Embryol (Berl) (2001) 203:53–59.
Maak S, Boettcher D, Tetens J, Wensch-Dorendorf
M, Nürnberg G, Wimmers K, Swalve HH, Thaller G. Identification of candidate genes for congenital splay leg in piglets by alternative analysis of DNA microarray data. Int J Biol Sci (2009) 5:331–337.

Wu T, Zhang X, Tian M, Tao Q, Zhang L, Ding Y, Zhang X, Yin Z. Transcriptome analysis reveals candidate genes involved in splay leg syndrome in piglets. J Appl Genet (2018) 59:475–483.
Hao X, Plastow G, Zhang C, Xu S, Hu Z, Yang T, Wang K, Yang H, Yin X, Liu S, et al. Genome-wide association study identifies candidate genes for piglet splay leg syndrome in different populations. BMC Genet (2017) 18:64.
Hai T, Cao C, Shang H, Guo W, Mu Y, Yang S, et al. Pilot study of large-scale production of mutant pigs by ENU mutagenesis. Elife. (2017) 6:e26248.
Xu S, Hao X, Zhang M, Wang K, Li S, Chen X, et al. Polymorphisms of HOMER1 gene are associated with piglet splay leg syndrome and one significant SNP can affect its intronic promoter activity in vitro. BMC Genet. (2018) 19:110.
Descarga el PDF
LLos datos avalan la eficacia de las vacunas basadas en el genotipo PCV-2a frente a los genotipos circulantes en la actualidad fruto de la evolución del circovirus porcino.
Dra. Gisela Girmé y Dr. Sebastián Figueras
Boehringer Ingelheim
Animal Health España, S.A.U.
La evolución genética del circovirus porcino 2 (PCV-2) es un fenómeno que se ha producido de forma natural a lo largo de las últimas décadas. Los diferentes cambios producidos en la cadena de nucleótidos del PCV-2 han generado la necesidad de establecer una clasificación taxonómica para abarcar los diferentes genotipos surgidos1.
En la actualidad, se han descrito hasta ocho genotipos diferentes, de los cuales tres destacan por su relevancia clínica:
• PCV-2a
• PCV-2b
• PCV-2d
Al inicio de la epizootia, en torno a los años 1996-1997, se identificó el actualmente denominado PCV-2a, que se convirtió en el genotipo más prevalente. Más adelante, hacia el año 2005, se observó un cambio en la prevalencia, detectándose en mayor proporción otro genotipo emergente, que se clasificó como PCV-2 genotipo b y que se convirtió, en pocos años, en el más predominante.
En 2010, se observó lo que se clasificó en un inicio como un genotipo mutante de PCV-2b y que se acabó clasificando como PCV-2d, lo que dio lugar al genotipo que desde entonces es el más prevalente2. Por otro lado, el genotipo PCV-2c no parece jugar un papel importante a nivel de campo (Figura 1)
Genotipo predominante anteriormente a nivel mundial
Base de la mayoría de vacunas comerciales disponibles
Genotipo detectado con mayor frecuencia desde 2004/2005
En comparación con otros virus (por ejemplo, PRRSV), los genotipos de PCV-2 apenas se diferencian genéticamente entre sí 3





Un estudio llevado a cabo en Bélgica⁴ en el que se compararon secuencias de ORF2 de cuarenta y tres aislados de PCV-2, demostró que dichos aislados tenían identidades de secuencia de los nucleótidos del 89,7% al 100% y de secuencia de aminoácidos del 88,5% al 100%.
El análisis tridimensional de la secuencia de aminoácidos que conforman la proteína de la cápside (codificada por la fracción ORF2 del genoma), reveló que para cada genotipo la mayoría de las mutaciones se presentaban
en el exterior de la proteína con algunas mutaciones conservadas presentes en el lado interior. Este hallazgo representaría una consecuencia de la evolución de PCV-2 hacia una mejor capacidad de unión al receptor (Figura 2). Sin embargo, en términos generales, se puede concluir que esta proteína inmunizante del virus no presenta diferencias significativas entre los genotipos.
Genotipo detectado ocasionalmente, sin mayores implicaciones en el campo
Primera evidencia en 2010
Actualmente el genotipo más frecuente2
Imagen 3D de la proteína ORF2 presente en la cápside de los distintos genotipos de PCV-2 (modificado de Wei et al., 2019). Las zonas coloreadas indican las zonas de la ORF2 en las que se observan diferencias entre los genotipos.

En la actualidad, la mayoría de vacunas comerciales de PCV-2 están basadas en la expresión de la proteína de la cápside del genotipo PCV-2a. Este hecho genera discusiones sobre la capacidad de protección que puedan brindar dichas vacunas frente a los actuales genotipos circulantes. No obstante, atendiendo al hecho de que esta proteína es altamente similar en los tres genotipos, cabría esperar una protección cruzada de estas vacunas frente a los genotipos “b” y “d”.
TABLA 1
En este sentido, varias publicaciones señalan la inmunización con vacunas basadas en PCV-2a, entre ellas Ingelvac CircoFLEX® (Boehringer Ingelheim Vetmedica, Inc.), como una alternativa eficaz frente a los diferentes genotipos descritos de PCV-2 (Tabla 1).
Resumen de los resultados de los principales estudios que muestran la eficacia de las vacunas basadas en PCV-2 frente a los distintos genotipos presentes en el campo.
Autor(es)
Haiwick et al., 2014
Rodier et al., 2014
Opriessnig, et al., 2014
Cepa(s) desafío/detectado(s)
PCV-2b
PCV-2b
PCV-2b y PCV-2d
Jeong et al., 2015 PCV-2b y PCV-2d
Fiedrich et al., 2019
PCV-2d
Park et al., 2019 PCV-2a, PCV-2b y PCV-2d
Resultados en animales vacunados (vacunas basadas en PCV-2a) vs no vacunados
Reducción de la viremia
Reducción de la prevalencia del antígeno de PCV-2 en las tonsilas Reducción de la depleción linfocitaria
Estimulación de células T CD8 e IFN-γ
Menor tasa de prevalencia (p<0,001)
Niveles tisulares de ADN de PCV2 y niveles de viremia significativamente más bajos (p<0,001)
Mayor GMD
Reducción de la carga viral en sangre
Reducción de las lesiones linfoides (p<0,05)
Reducción significativa de la viremia (p<0,0001) Mayor GMD (p<0,0001)
Reducción lesiones del tejido linfoide
Reducción de la mortalidad y la aparición de signos clínicos de enfermedad asociada a PCV-2
Reducción significativa de la carga viral en sangre (p<0,05) Mayor respuesta inmune celular (p<0,05)
1 2 3
El primero, realizado por Haiwick et al. (2014) en EEUU, evidenció que Ingelvac CircoFLEX® confería protección cruzada en lechones de 7 semanas desafiados 28 días post-vacunación con un genotipo campo de PCV-2b, al compararlos con lechones no vacunados.
La vacuna redujo la viremia y evitó la depleción linfocitaria, reduciendo la prevalencia del antígeno de PCV-2 en las tonsilas de los lechones vacunados frente al grupo desafiado no vacunado.
Rodier et al. (2014) realizaron un estudio en Reino Unido vacunando lechones con 21 días de edad con Ingelvac CircoFLEX® para compararlos con un grupo control. Ambos grupos fueron desafiados 3 semanas post-vacunación con un genotipo de campo de PCV-2b.

Los resultados indicaron que la vacuna fue capaz de estimular la respuesta inmune celular basada en células T CD8, induciendo una respuesta IFN-γ de memoria.
Por otro lado, Opriessnig et al. (2014) vacunaron con tres vacunas comerciales basadas en PCV-2a, entre ellas Ingelvac CircoFLEX®, a grupos de lechones de 2 semanas infectados de forma natural con PCV-2b. Se respetó la pauta vacunal indicada por cada laboratorio, incluyendo dos grupos control (negativo y positivo). A las 11 semanas de edad, todos los lechones, excepto los controles negativos, fueron desafiados con un genotipo de PCV-2d.
Todos los grupos de lechones vacunados tuvieron tasas de prevalencia, niveles tisulares de ADN de PCV2 y niveles de viremia significativamente más bajos (p<0,001) en comparación con los lechones no vacunados desafiados, consistentes con una respuesta inmunitaria de base celular protectora.
LA ADMINISTRACIÓN DE VACUNAS BASADAS EN PCV-2a CONFIERE PROTECCIÓN CRUZADA, INDUCIENDO UNA RESPUESTA INMUNITARIA CELULAR PROTECTORA
De forma parecida, Jeong et al. en 2015 compararon la eficacia de tres vacunas monodosis basadas en PCV-2a, incluyendo Ingelvac CircoFLEX®, en una granja con infección concurrente de PCV-2b y PCV-2d8
Todos los grupos de animales vacunados mejoraron la GMD y redujeron la carga de ambos virus en sangre en comparación con los animales no vacunados.
La vacunación de los lechones a las 3 semanas de edad indujo de forma eficaz niveles más altos de anticuerpos neutralizantes y de células secretoras de interferón-γ específicos de PCV-2b y PCV-2d en comparación con los animales no vacunados.
Las lesiones linfoides microscópicas fueron significativamente más bajas (p<0,05) en los animales vacunados, lo que corroboró la protección que confieren las vacunas de PCV-2a frente a PCV-2b y PCV-2d.
En 2019, Friedrich et al. compararon la eficacia de Ingelvac CircoFLEX® frente a la de una vacuna basada en PCV-2d9 en lechones infectados de forma natural con PCV-2a. Tras vacunar a los lechones a las 3 semanas de edad, fueron desafiados 28 días después con un aislado de PCV-2d.
Para ambos grupos de tratamiento, la viremia se redujo significativamente (p<0,0001) y la GMD aumentó significativamente (p<0,0001). Además, ambas vacunas previnieron de forma similar las lesiones del tejido linfoide, la mortalidad y la aparición de signos clínicos de enfermedad asociada a PCV-2, evidenciando la efectividad de ambos protocolos vacunales frente a una exposición mixta a PCV-2a y PCV-2b.
Ese mismo año, Park et al. realizaron un estudio comparando la eficacia de Ingelvac CircoFLEX® frente a la exposición a PCV-2a, PCV-2b y PCV-2d, vacunando a un grupo de lechones a los 21 días de edad y desafiándolos 4 semanas después de la vacunación.
Todos los animales vacunados mostraron una reducción significativa (p<0,05) de los signos clínicos, la viremia de PCV-2, las lesiones linfoides y los niveles de antígeno de PCV-2 en tejido linfoide en comparación con el grupo control no vacunado.
La vacunación dio como resultado títulos significativamente más altos (p<0,05) de anticuerpos neutralizantes frente a PCV-2 y un aumento en la frecuencia de células secretoras de interferón-γ específicas de PCV-2.
La vacuna mostró una protección similar entre los grupos vacunados, independientemente del genotipo del desafío.
1Franzo, G. y Segalés, J. (2018). PLoS One, 13 (12).
2 Eddicks, M. et al., (2015). Veterinary Microbiology
176: 337 – 343.
3 Payne B. et al., (2016). AASV Annual Meeting Proceedings (202-206)
4 Wei R. et al. (2019). Virus Evolution: 5(2): 026
5 Haiwick, G. et al., (2014). AASV Annual Meeting Proceedings (129-130)
En conclusión, podemos decir que, pese a la evolución genética del PCV-2 a lo largo de estos años, las vacunas basadas en el genotipo PCV-2a, como Ingelvac CircoFLEX®, siguen siendo hoy por hoy eficaces frente a las infecciones producidas por los distintos genotipos presentes en el campo.



Ingelvac CircoFLEX® Cada dosis de 1 ml de la vacuna inactivada contiene: Proteína ORF2 de Circovirus Porcino Tipo 2. PR* mínima 1,0; PR* máxima 3,75. *Potencia Relativa (test ELISA) por comparación con una vacuna de referencia. Adyuvante: Carbómero. Indicaciones: Inmunización activa de cerdos a partir de 2 semanas frente al PCV2 para la reducción de la mortalidad, signos clínicos- incluyendo pérdida de peso- y lesiones en tejidos linfoides relacionadas con las enfermedades asociadas al PCV2 (PCVD). Además, la vacunación ha demostrado reducir la excreción nasal de PCV2, la carga viral en sangre y tejidos linfoides y la duración de la viremia. Inicio de la protección: 2 semanas tras la vacunación. Duración de la protección: al menos 17 semanas. Interacción con otros medicamentos: Existe información sobre la seguridad y la eficacia que demuestra que esta vacuna se puede mezclar con Ingelvac MycoFLEX® de Boehringer Ingelheim y administrar en un punto de inyección. Gestación y lactancia: Puede utilizarse durante la gestación y la lactancia. Reacciones adversas: De forma muy frecuente se produce hipertermia leve y transitoria el día de la vacunación. En muy raras ocasiones, pueden ocurrir reacciones anafilácticas que deberán tratarse sintomáticamente. Posología: Inyección única por vía intramuscular de una dosis (1 ml), independientemente del peso vivo. Tiempo de espera: Cero días. Conservación: Conservar y transportar refrigerado (entre 2 °C y 8 °C). No congelar. Proteger de la luz. Usar inmediatamente después de abierto. Presentación: Frascos de 50ml (50 dosis) y 100ml (100 dosis). Reg. nº: EU/2/07/079/002(50ml)-003(100ml). Titular: Boehringer Ingelheim Vetmedica GmbH.



Es frecuente encontrar varios virus respiratorios presentes de forma simultánea en infecciones en humanos y animales, incluidos los cerdos1-7. Se han descrito infecciones concurrentes de varios virus respiratorios, como el virus de la Influenza A porcina (swIAV), el virus del síndrome reproductivo y respiratorio porcino (PRRSV), el circovirus porcino de tipo 2 (PCV2) o el coronavirus respiratorio porcino (CRPV)6-8 . Además, el PRRSV y el IAV, juntos o por separado, suelen ser agentes primarios o secundarios responsables del Complejo Respiratorio Porcino 9,10 .
Małgorzata Pomorska-Mól1 , Katarzyna Podgórska2 , Ewelina Czyżewska-Dors2 , Hanna TurlewiczPodbielska1 , Maciej Gogulski1 , Jan Włodarek1 y Anna Łukomska1
1 Departamento de Ciencias Preclínicas y Enfermedades Infecciosas, Facultad de Medicina Veterinaria y Ciencias Animales, Universidad de Ciencias de la Vida de Poznan, Polonia
2Departamento de Enfermedades Porcinas, Instituto Nacional de Investigación Veterinaria, Pulawy, Polonia
Las infecciones víricas simultáneas pueden mostrar una interferencia vírica en la que un virus bloquea el crecimiento de otro11 y, dado que las infecciones mixtas del tracto respiratorio se observan con frecuencia en los cerdos, el efecto de la interacción de los patógenos en el curso de la infección merece un estudio más profundo.
El impacto de la coinfección en la gravedad y el resultado clínico no es del todo claro. Algunos estudios han demostrado que el resultado clínico de las coinfecciones víricas puede ser menos grave, o al menos no más grave, que la infección por un solo virus2,6,7,12,13 . Por el contrario, otros estudios han constatado que la coinfección vírica agrava el curso clínico1,13

Las coinfecciones de swIAV y PRRSV son comunes en el ganado porcino14-16 . Ambos virus se encuentran asociados al CRP y algunos estudios indican la posibilidad de que tengan efectos sinérgicos6,17
Debido a que muchas cepas de PRRSV tienen un potencial inmunosupresor, pueden afectar a la respuesta inmunitaria frente a otros patógenos17,18 y estudios anteriores han mostrado diversos resultados clínicos con la infección dual de PRRSV y swIAV6,7,17
No se encontraron cambios significativos en el curso clínico de la infección en un estudio en el que los lechones fueron infectados con PRRSV y una semana después con swIAV7. En cambio, otro estudio registró una enfermedad más grave tras una coinfección en comparación con la infección única por PRRSV17. En otro estudio sobre PRRSV y swIAV, se observaron resultados clínicos variables en cerdos coinfectados con PRRSV y swIAV6
El swIAV empleado en este estudio, un virus H1N1 A/Poland/Swine/14131/2014 (SwH1N1) similar al aviar, había sido aislado de un cerdo con influenza porcina aguda.
La cepa PL15-33 del PRRSV fue aislada a partir de tejido pulmonar obtenido de un cerdo con trastornos clínicos respiratorios y la secuenciación de los fragmentos ORF5 y ORF7 indicó que la cepa pertenecía al subtipo 1 del PRRSV-1.
DISEÑO EXPERIMENTALDISEÑO EXPERIMENTAL
Grupo PRRSV (n = 14)
Grupo swIAV + PRRSV (n = 14)
Grupo swIAV (n = 14)
Grupo control (n = 12)
Antes de comenzar el estudio, mediante PCR se comprobó que todos los animales experimentales estaban libres de swIAV19 y PRRSV (EZ-PRRSV MPX 4.0 real-time PCR kit, Tetracore, USA), así como la ausencia de anticuerpos frente a swIAV [(pruebas de inhibición de la hemaglutinación con A/Poland/Swine/14131/2014 (H1N1), A/Poland/Swine/14131/2014 (H1N1), A/swine/ England/96 (H1N2), A/swine/Flandes/1/98 (H3N2) y H1N1 pdm-like (A/ swine/Poland/031951/12)] y frente a PRRSV (test ELISA comercial VetExpert PRRS Ab ELISA 4.0 BioNote, Corea).
Independientemente de los resultados de los estudios previos de coinfección, nuestra comprensión del efecto de un virus sobre el otro, tanto a nivel clínico como celular sigue siendo limitada.
Por lo tanto, nuestro objetivo ha sido evaluar y comparar las características clínicas, la respuesta inmunitaria y de fase aguda, la excreción viral y la carga viral de cerdos inoculados con swIAV, PRRSV o una combinación de ambos.
El día 0, los lechones de los grupos swIAV y swIAV + PRRSV fueron inoculados por vía intranasal (IN) con SwH1N1 (107 dosis de infección de cultivo de tejidos [TCID50] en 2 mL de solución salina tamponada con fosfato (PBS). Los lechones de los grupos PRRSV y swIAV + PRRSV fueron inoculados por vía IN con PRRSV (105 TCID50 en 2 mL de PBS). Para los cerdos inoculados con ambos virus, el inóculo se mezcló justo antes de la administración IN. El volumen final de inóculo para este grupo fue el mismo (2 mL por cerdo). Por su parte, los doce cerdos inoculados con PBS (2 mL) sirvieron de control.
Los animales fueron examinados diariamente desde el día 7 de pre-inoculación hasta el final del periodo de estudio (día 21 día post-inoculación -dpi-) o hasta la eutanasia (2, 4 y 10 dpi). Los cerdos fueron observados y puntuados en función de los signos respiratorios:
Frecuencia respiratoria:
0 = normal
0,33 = ligeramente aumentada
0,66 = moderadamente aumentada y ligera respiración abdominal
1 = claramente aumentada y clara respiración abdominal
Secreción nasal:
0 = ausente
1 = presente
Tos:
0 = ausente
1 = presente
Estornudos:
0 = ausente
1 = presente
Anorexia:
0 = ausente
1 = presente
La temperatura rectal se midió diariamente, registrándose fiebre cuando la temperatura rectal alcanzaba o superaba los 40˚C. Cuando se observaba fiebre prolongada (al menos 3 días) se añadía un punto adicional a la puntuación clínica.
Se obtuvieron hisopos nasales diariamente de todos los animales y se tomaron muestras de sangre a los 7 días pre-inoculación, al día 0 (inoculación) y a los dpi 1, 2, 3, 5, 7, 10, 14 y 21. Tres lechones de los grupos inoculado y de control fueron eutanasiados a los 2, 4 y 10 dpi. El resto de los cerdos inoculados fueron eutanasiados y necropsiados a los 21 dpi.
Las lesiones pulmonares macroscópicas se utilizaron para asignar una puntuación pulmonar20 . A cada lóbulo pulmonar se le asignó un número que reflejaba un porcentaje del volumen aproximado de todo el pulmón representado:
Se asignaron 10 puntos posibles (5 para la parte dorsal y 5 para la ventral) al lóbulo anterior derecho, al lóbulo medio derecho, a la parte anterior del lóbulo anterior izquierdo y a la parte caudal del lóbulo anterior izquierdo.
Al lóbulo accesorio se le asignaron 5 puntos.
27,5 puntos (15 para la parte dorsal y 12,5 para la parte ventral) se asignaron a cada uno de los lóbulos caudales derecho e izquierdo.
La evaluación basada en este procedimiento dio como resultado una puntuación pulmonar (puntos totales = 100) correspondiente al porcentaje del pulmón afectado por neumonía.
Durante el estudio, se realizaron los siguientes análisis laboratoriales con el fin de determinar la carga viral y la respuesta inmunitaria frente a Influenza Porcina y PRRS.
Examen virológico de los hisopos y las muestras de tejido: determinación de la carga viral de swIAV en células MDCK24 y cuantificación de ARN de PRRSV mediante un kit de RT-PCR.
Serología: todos los sueros fueron sometidos a la prueba de hemaglutinación frente a swIAV y ELISA frente a PRRSV.
Prueba de proliferación de linfocitos: la prueba de proliferación de linfocitos T permitió medir las respuestas de linfocitos T específicos frente a swIAV y PRRSV de los cerdos a los 0, 7, 14 y 21 dpi21
Medición de proteínas de fase aguda: se midieron los niveles de proteína C reactiva (CRP), haptoglobina (Hp), amiloide sérico A (SAA) y Pig-MAP (proteína de fase aguda principal en el cerdo).

Siete de los catorce (50%) lechones inoculados con swIAV y tres de los catorce (21,5%) inoculados con PRRSV tuvieron una fiebre persistente (>3 días) que alcanzó los 40,0-41,4˚C.
En el grupo inoculado con ambos virus, se observó fiebre persistente en diez de los catorce lechones (71,5%; Figura 1). Además, en estos lechones, la fiebre se observó durante más tiempo (hasta 10dpi) en comparación con otros grupos inoculados.
En el grupo swIAV, la fiebre alcanzó su pico máximo a los 2 dpi, mientras que en los cerdos inoculados con ambos virus se observaron 2 picos (a los 3 y 7-10 dpi), observándose una cinética de temperatura rectal similar (2 picos) en el grupo de PRRSV.
FIGURA 1
Temperatura rectal (media ± DE) en lechones inoculados con el virus de la Influenza A porcina (swIAV), con el virus del Síndrome Reproductivo y Respiratorio Porcino (PRRSV) o con ambos.
No se encontraron diferencias significativas entre las puntuaciones clínicas medias de los grupos inoculados (P ≥ 0,05; Figura 2).
Grupo swIAV + PRRSV: Trece de los catorce lechones del grupo inoculado con ambos virus presentaban al menos uno de los signos clínicos evaluados y las puntuaciones clínicas individuales en este grupo oscilaron entre 0 y 4.
Grupo swIAV: se registraron signos clínicos en once de los catorce lechones y las puntuaciones clínicas individuales oscilaron entre 0 y 3,66.
Grupo PRRSV: diez de los 14 lechones presentaron alteraciones clínicas con unas puntuaciones clínicas individuales que oscilaron entre 0 y 3.
Grupo control: no se observaron signos clínicos.
Puntuación clínica (media ± DE) de los lechones inoculados con el virus de la Influenza A porcina (swIAV), con el virus del Síndrome Reproductivo y Respiratorio Porcino (PRRSV) o con ambos. a: diferencia significativa con respecto a los controles (P < 0,05).
Excreción nasal de virus (media ± DE) tras la inoculación de cerdos con el virus de la influenza A porcina (swIAV) (A) o el virus del Síndrome Reproductivo y Respiratorio Porcino (PRRSV) (B). La línea discontinua representa el límite de detección.
El valor AUC para la excreción de swIAV y PRRSV no difirió significativamente entre los cerdos inoculados con un solo virus o con ambos (P ≥ 0,05). La dinámica de excreción de ambos patógenos (media ± DE) durante el periodo de estudio se presenta en la Figura 3A (PRRSV) y B (swIAV).
FIGURA 2El AUC para la viremia de PRRSV no difirió significativamente entre los cerdos inoculados con uno de los virus o con ambos (P ≥ 0,05, Figura 4), detectándose el ARN del PRRSV en las muestras de suero de todos los animales inoculados con este virus, ya sea solo o en combinación con el swIAV. En general, la viremia del PRRSV comenzó a partir del dpi 1 y duró hasta el final del estudio (21 dpi). No se observaron diferencias significativas entre los grupos inoculados con el PRRSV durante todo el periodo de estudio, ni se encontró ARN del PRRSV en el suero de los lechones de los grupos control y swIAV.
4
Resultados promedios de la RT-PCR cuantitativa (±DE) en muestras de suero (copias de ARN del PRRSV/mL de suero) en cada momento del muestreo. La línea discontinua representa el límite de detección.
La respuesta humoral tras la inoculación de los lechones con swIAV, PRRSV o ambos se muestra en la Figura 5.
Siete de los ocho lechones del grupo inoculado con ambos virus mostraron seroconversión frente a SwIAV a los 7 dpi.
En el grupo SwIAV, solamente tres de los ocho lechones tuvieron seroconversión a los 7 dpi.
Todos los lechones inoculados con swIAV (solo o con PRRSV) mostraron seroconversión frente a este virus a los 10 DPI.
Todos los lechones inoculados con PRRSV (solo o con swIAV desarrollaron anticuerpos específicos a los 10 dpi (con la excepción de 1 cerdo en el grupo PRRSV + swIAV que seroconvirtió a los 14 dpi).
No se observaron diferencias en la magnitud de la respuesta humoral frente al swIAV y al PRRSV entre los grupos inoculados con uno de los virus o con ambos (P ≥ 0,05).
En el grupo control, las concentraciones séricas de todas las proteínas de fase aguda investigadas se mantuvieron estables durante el periodo de estudio y no difirieron significativamente de las concentraciones observadas a los 7 días de pre-inoculación (Figura 6)
La concentración sérica de CRP aumentó significativamente en los lechones inoculados solamente con el PRRSV y en los inoculados con ambos virus (Figura 6A) en comparación con los del grupo control (P < 0,05).
En los lechones del grupo PRRSV + swIAV, la concentración sérica media de CRP aumentó significativamente desde el día 2 post-inoculación hasta el final del estudio (en comparación con la concentración del día 0 y con los animales de control).
En el grupo de PRRSV, se observó una cinética diferente de la concentración sérica de CRP, ya que las concentraciones séricas medias de esta proteína fueron significativamente mayores a los 4, 10 y 14 DPI en comparación con el grupo control (P < 0,05).

SIGNIFICATIVAMENTE EN LOS GRUPOS PRRSV Y PRRSV + sw IAV
La concentración sérica de Hp aumentó significativamente en los grupos PRRSV y PRRSV + swIAV en comparación con el grupo control (Figura 6B), siendo la dinámica de la concentración sérica de esta proteína de fase aguda similar en ambos grupos inoculados con PRRSV.
En los lechones de los grupos PRRSV + swIAV y PRRSV, las concentraciones séricas medias de Hp aumentaron significativamente desde el día 4 al día 14 post-inoculación (en comparación con las concentraciones séricas del día 0 y con el grupo control).
Las concentraciones séricas de SAA aumentaron significativamente entre los días 2 y 4 post-inoculación en los grupos swIAV y PRRSV + swIAV en comparación con el grupo control (P < 0,05), pero a partir de los 5 dpi no hubo diferencias significativas en las concentraciones de esta proteína de fase aguda entre los grupos inoculados y el grupo control (P ≥ 0,05; Figura 6C).
PIG-MAP
La concentración sérica de Pig-MAP se mantuvo sin cambios en comparación con su concentración previa a la inoculación (P ≥ 0,05) en los cerdos inoculados con swIAV y en los animales de control (Figura 6D).
En los lechones de los grupos de PRRSV y swIAV + PRRSV, se observaron aumentos significativos a partir del día 3 post-inoculación. La concentración sérica de Pig-MAP permaneció aumentada en ambos grupos hasta los 7 dpi en comparación con la concentración del día 0 y con las concentraciones en los cerdos de control (P < 0,05), no observándose diferencias en ambos grupos inoculados con PRRVS.
Concentraciones de SAA, Pig-MAP, Hp y CRP (media ± DE) en el suero de los lechones antes y en varios momentos después de la inoculación con el virus de la Influenza A porcina (swIAV), con el virus del Síndrome Reproductivo y Respiratorio Porcino (PRRSV) o con ambos. Las diferencias significativas (P < 0,05) dentro del mismo día se indican como sigue: a, grupo swIAV + PRRSV frente a grupo de control; b, grupo PRRSV frente a grupo de control; c, grupo swIAV frente a grupo de control.

Días post-inoculación (dpi)
Días post-inoculación (dpi)
Días post-inoculación (dpi)
FIGURA6Se observaron lesiones pulmonares características de una infección viral de gravedad variable (puntuaciones de 1 a 15 en el grupo swIAV, 0 a 28 en el grupo PRRSV y 1,25 a 23,5 en el grupo swIAV + PRRSV) en todos los lechones inoculados con virus entre los días 2 y 10 post-inoculación. Los promedios de lesiones observadas en todos los grupos experimentales se presentan en la Figura 7.
A los 21 dpi, no se encontraron lesiones patológicas en 3 de los 5 lechones del grupo swIAV.
En el grupo PRRSV no se observaron lesiones a los 2 y 4 dpi mientras que a los 10 y 21 dpi se encontraron lesiones pulmonares típicas de la infección por PRRSV en todos los animales.

Los lechones del grupo control no mostraron lesiones patológicas.
A los 2 y 4 dpi, las puntuaciones de lesiones pulmonares observadas en los grupos swIAV y PRRSV + swIAV fueron significativamente mayores que las de los grupos PRRSV y control (P < 0,05).
A los 10 dpi, el promedio de puntuación de lesiones en el grupo PRRSV + swIAV fue mayor que en los grupos PRRSV y control (P < .05).
El promedio de la puntuación de lesiones difirió significativamente a los 21 dpi entre los grupos PRRSV y control (P < 0,05), así como en comparación con el grupo swIAV (P < 0,05).
FIGURA 7
Puntuaciones de las lesiones pulmonares (promedio ± DE) observadas en los cerdos inoculados con el virus de la Influenza A porcina (swIAV), con el virus del Síndrome Reproductivo y Respiratorio Porcino (PRRSV) o con ambos. a, diferencias significativas entre el grupo swIAV y PRRSV + swIAV vs PRRSV y el grupo de control (P < 0,05); b, diferencias significativas entre el grupo PRRSV + swIAV frente a los grupos PRRSV y control (P < 0,05); c, diferencias significativas entre el grupo PRRSV y PRRSV + swIAV frente a los grupos swIAV y control (P < 0,05)
c c
Las cargas virales en los pulmones a los 2, 4, 10 y 21 dpi se presentan en la Figura 8.
El ARN de swIAV se detectó en todas las muestras tomadas de los pulmones derechos de los cerdos inoculados con este virus a los 2 y 4 dpi. A los 10 y 21 dpi, no se detectó el swIAV en ninguno de los grupos. Los títulos medios de TCID50 del swIAV no difirieron significativamente entre los lechones inoculados solamente con este virus y los inoculados también con el PRRSV (P ≥ 0,05).

Se encontraron diferencias significativas entre el número medio de copias del PRRSV en los pulmones tomados de los cerdos de los grupos PRRSV y PRRSV + swIAV (P < 0,05) a los 2 dpi, siendo este valor significativamente mayor en los cerdos inoculados sólo con PRRSV. A los 4, 10 y 21 dpi, no se observaron diferencias significativas en la carga viral pulmonar de PRRSV (P ≥ .05).
El PRRSV se detectó en las muestras tomadas del pulmón derecho de todos los lechones inoculados solamente con PRRSV y aquellos inoculados también con swIAV desde el día 2 al 21 post-inoculación.
FIGURA 8
Título viral de swIAV (A) y el número medio de copias de PRRSV (B) (media ± SD) en los pulmones a los 2, 4, 10 y 21 días después de la inoculación única o la coinoculación de los cerdos. La línea discontinua representa el límite de detección. a, diferencias significativas entre el grupo PRRSV y PRRS + swIAV (P < .05).
CARGA VIRALCARGA VIRALLA CARGA VIRAL DE PRRSV A LOS 2 DPI FUE
MAYOR EN EL GRUPO PRRVS EN COMPARACIÓN CON EL GRUPO
+ sw IAV
Los resultados de este estudio muestran que la infección simultánea con el PRRSV y el swIAV tiene un impacto limitado en el desarrollo clínico y la respuesta inmunitaria frente a estos virus. Para la mayoría de los parámetros estudiados, no se observaron diferencias significativas entre los lechones infectados de forma individual con PRRSV o con swIAV, o simultáneamente con ambos virus, incluyendo la puntuación de lesiones pulmonares.
No obstante, a pesar de que las puntuaciones clínicas no mostraron diferencias estadísticamente significativas, se observó un mayor número de lechones con fiebre persistente y de mayor duración en el grupo coinfectado.
Estudios previos sobre las coinfecciones de PRRSV y swIAV han arrojado resultados contradictorios en relación a su impacto en su evolución clínica7 6 13 ,17. En este caso, no se observó ningún retraso o descenso en la excreción de swIAV en el grupo coinfectado (PRRSV + swIAV) en comparación con el grupo swIAV.
En contraste, se evidenció un breve descenso de la replicación de PRRSV en los pulmones el día 2 post-inoculación en el grupo coinfectado (PRRSV + swIAV) en comparación con el grupo PRRSV (P < 0,05).

El impacto limitado de la coinfección en la evolución clínica, la carga viral y la excreción puede ser el resultado de las diferencias en la diana celular de los dos virus.
Los macrófagos diferenciados, concretamente, los macrófagos alveolares pulmonares (MAP) y los macrófagos intravasculares pulmonares, son la diana principal del PRRSV, aunque este virus también puede replicarse en menor medida, en células dendríticas y macrófagos derivados de monocitos presentes en la mayoría de los órganos22
El swIAV infecta el epitelio del tracto respiratorio (bronquios, bronquiolos y alvéolos) y se replica ampliamente en los pulmones porcinos23
El coronavirus respiratorio porcino (PRCV), que también se replica principalmente en el epitelio del tracto respiratorio inferior, interfiere fuertemente con la infección ocasionada por el swIAV, disminuyendo la replicación del swIAV en un 99%32. Por otro lado, cerdos coinfectados con PRRSV y PRCV muestran lesiones clínicas y pulmonares más severas, pero no se observó ningún impacto en el nivel de replicación ni en la eliminación del virus17.
Aunque un estudio anterior en el que se utilizó una línea celular recombinante susceptible de ser infectada por ambos virus, confirmó que los virus interferían entre sí 24, en un hospedador natural sólo una pequeña población de células dendríticas y, en algunos casos, los neumocitos de tipo 1 pueden ser el objetivo común del PRRSV y del swIAV.
La interferencia del swIAV con la cantidad de PRRSV detectada a los 2 dpi podría ser el resultado de un aumento de la producción de interferón alfa (IFN-α) por parte de las células dendríticas plasmocitoides (pDC) y otros tipos de células en respuesta a la infección por el swIAV.
A los 2 dpi, cuando se detectó una disminución significativa de la replicación del PRRSV en los pulmones de los cerdos coinfectados (grupo PRRSV + swIAV), no se detectaron lesiones pulmonares visibles en el grupo PRRSV. Simultáneamente, la puntuación de lesiones en los grupos swIAV y PRRSV + swIAV eran comparables, lo que indica que durante este periodo de tiempo el swIAV fue la única causa de las lesiones patológicas en los pulmones.
Las diferencias en la puntuación de lesiones entre los grupos experimentales (infección individual o coinfección) observadas en este estudio probablemente están relacionadas con la dinámica de la infección por los virus (swIAV o PRRSV) y no con las interacciones que se producen entre ellos.
En el caso del swIAV, las lesiones pulmonares aparecieron antes y su disminución coincidió con el desarrollo más intenso de las lesiones pulmonares asociadas al PRRSV. El análisis del patrón de lesiones a lo largo del tiempo en el grupo coinfectado indicó que la puntuación reflejaba la dinámica aditiva de los grupos infectados únicamente con el swIAV o únicamente con el PRRSV. La puntuación de lesiones más alta se registró en el grupo coinfectado a los 10 dpi y superó significativamente la del grupo PRRSV. El promedio de la puntuación de lesiones en este momento también fue más alto, aunque no significativamente, en comparación con el grupo inoculado con swIAV.
Lo más probable es que el leve aumento de la gravedad de las lesiones clínicas y microscópicas, también señalado en estudios anteriores, sea un efecto del aumento del daño de la estructura pulmonar y de la inflamación en el caso de la coinfección13,17
La infección por el swIAV provoca la necrosis de las células epiteliales, el aumento de la producción de mediadores proinflamatorios y la infiltración con células fagocíticas susceptibles a la infección por el PRRSV25,26

Los signos respiratorios causados por el PRRSV también son el resultado de su acción sobre el pulmón y la interacción con el sistema inmunitario del hospedador. El virus provoca una neumonía intersticial e induce apoptosis mediada por TNF-α, también en los macrófagos transeúntes no infectados27
Dado que este estudio se realizó en condiciones estrictamente controladas en una instalación BSL3, no refleja las condiciones de campo en las que pueden intervenir muchos factores. Concretamente, las diferentes cargas de infección bacteriana en el tracto respiratorio pueden interferir en el curso clínico y patológico de las coinfecciones víricas y contribuir al resultado.
Nuestros resultados también muestran que la coinfección con cepas locales de PRRSV y swIAV no afectó a la intensidad y cinética de las respuestas de fase aguda e inmunitaria. Los resultados de un estudio anterior determinaron que la respuesta de fase aguda era notablemente diferente entre cepas en términos de intensidad y duración28, pero la Hp fue el biomarcador más sensible para la infección por PRRSV. Además, la Hp y la CRP discriminaron entre los cerdos infectados y los de control.
Estos hallazgos coinciden con nuestros resultados, ya que el aumento significativo de Hp y CRP se observó sólo en los grupos PRRSV y PRRSV + swIAV. Además, se observaron diferencias significativas con respecto a la Hp entre los grupos de PRRSV y PRRSV + swIAV y el grupo de swIAV entre los días 4 y 14 post-infección.
No se observaron diferencias significativas en el nivel de proliferación de las PBMC (células mononucleares de sangre periférica) ni en la respuesta humoral frente a ambos patógenos entre los grupos infectados o coinfectados (P ≥ 0,05).
Aunque el PRRSV puede ser inmunosupresor y actuar de forma sinérgica con algunos patógenos, la coinfección simultánea de cerdos con el swIAV y el PRRSV no potenció la gravedad de los signos clínicos, las lesiones pulmonares, la respuesta inmunitaria y la replicación de ambos virus en el tracto respiratorio.
La ausencia de sinergia entre ambos virus tras su replicación es beneficiosa para el hospedador, ya que no debería conducir a un empeoramiento de las alteraciones pulmonares y los signos clínicos, a pesar de la coinfección común en condiciones de campo.
Artículo traducido y adaptado de: Pomorska-Mól M, Podgórska K, Czyżewska-Dors E, et al. Kinetics of single and dual simultaneous infection of pigs with swine influenza A virus and porcine reproductive and respiratory syndrome virus. J Vet Intern Med. 2020;34:1903–1913. https://doi.org/10.1111/jvim.15832 (CC BY 4.0)
1. Goka EA, Vallely PJ, Mutton KJ, et al. Single, dual and multiple respiratory virus infections and risk of hospitalization and mortality. Epidemiol Infect. 2015;143:37-47.
2. Martin ET, Kuypers J, Wald A, et al. Multiple versus single virus respiratory infections: viral load and clinical disease severity in hospitalized children. Influenza Other Respir Viruses. 2011;6:71-77.
3. Zhang G, Hu Y, Wang H, Zhang L, Bao Y, Zhou X. High incidence of multiple viral infections identified in upper respiratory tract infected children under three years of age in Shanghai, China. PLoS One. 2012;7(9):e44568.
4. Dorr APM, Gebreyes WA, Almond GW. Porcine reproductive and respiratory syndrome virus: age and management system disease modeling for pathogenic co-infection. J Swine Health Prod. 2007;15:258-264.
5. Opriessnig T, Gimenez-Lirola LG, Halbur PG. Polymicrobial respiratory disease in pigs. Animal Health Res Rev. 2011;12:133-148.
6. Van Reeth K, Nauwynck H, Pensaert M. Clinical effects of experimental dual infections with porcine reproductive and respiratory syndrome virus followed by swine influenza virus in conventional and colostrum-deprived pigs. J Vet Med B Infect Dis Vet Public Health. 2001;48:283-292.
7. Pol JM, van Leengoed LA, Stockhofe N, et al. Dual infections of PRRSV/influenza or PRRSV/Actinobacillus pleuropneumoniae in the respiratory tract. Vet Microbiol. 1997;55:259-264.
8. Jung K, Renukaradhya G, Alekseev KP, et al. Porcine reproductive and respiratory syndrome virus modifies innate immunity and alters disease outcome in pigs subsequently infected with porcine respiratory coronavirus: implications for respiratory viral co-infections. J Gen Virol. 2009;90:2713-2723.
9. Choi YK, Goyal SM, Joo HS. Retrospective analysis of etiologic agents associated with respiratory diseases in pigs. Can Vet J. 2003;44: 735-737.
10. Fablet C, Marois-Crehan C, Simon G, et al. Infectious agents associated with respiratory diseases in 125 farrow-to-finish pig herds: a cross-sectional study. Vet Microbiol. 2012;157:152-163.
11. Pinky L, Dobrovolny HM. Coinfections of the respiratory tract: viral competition for resources. PLoS One. 2016;11:e0155589.
12. Brand HK, de Groot R, Galama JMD, et al. Infection with multiple viruses is not associated with increased disease severity in children with bronchiolitis. Pediatr Pulmonol. 2012;47:393-400.
13. Kitikoon P, Vincent AL, Jones KR, et al. Vaccine efficacy and immune response to swine influenza virus challenge in pigs infected with porcine reproductive and respiratory syndrome virus at the time of SIV vaccination. Vet Microbiol. 2009;139:235-244.
14. Ouyang T, Zhang X, Liu X, et al. Co-infection of swine with porcine circovirus type 2 and other swine viruses. Viruses. 2019;11:185.
15. Brockmeier SL, Halbur PG, Thacker EL. Porcine respiratory disease complex. In: Brogden KA, Guthmiller JM, eds. Polymicrobial Diseases. Washington, DC: ASM Press; 2002 (Chapter 13).
16. López-Soria S, Maldonado J, Riera P, et al. Selected swine viral pathogens in indoor pigs in Spain. Seroprevalence and farm-level characteristics. Transbound Emerg Dis. 2010;57:171-179.
17. Van Reeth K, Nauwynck H, Pensaert M. Dual infections of feeder pigs with porcine reproductive and respiratory syndrome virus followed by porcine respiratory coronavirus or swine influenza virus: a clinical and virological study. Vet Microbiol. 1996;48:325-335.
18. Mateu E, Diaz I. The challenge of PRRS immunology. Vet J. 2008;177:345-351.
19. Slomka MJ, Densham AL, Coward VJ, et al. Real time reverse transcription (RRT)-polymerase chain reaction (PCR) methods for detection of pandemic (H1N1) 2009 influenza virus and European
swine influenza A virus infections in pigs. Influenza Other Respir Viruses. 2010;4:277-293.
20. Halbur PG, Paul PS, Frey ML, et al. Comparison of the pathogenicity of two US porcine reproductive and respiratory syndrome virus isolates with that of the Lelystad virus. Vet Pathol. 1995;32:648-660.
21. Pomorska-Mól M, Markowska-Daniel I. Interferon- γ secretion and proliferative responses of peripheral blood mononuclear cells after vaccination of pigs against Aujeszky's disease in the presence of maternal immunity. FEMS Immunol Med Microbiol. 2010;58:405-411.
22. Singleton H, Graham SP, Bodman-Smith KB, et al. Establishing porcine monocyte-derived macrophage and dendritic cell systems for studying the interaction with PRRSV-1. Front Microbiol. 2016;7:832.
23. Van Reeth K, Nauwynck H. Proinflammatory cytokines and viral respiratory disease in pigs. Vet Res. 2010;31:187-213.
24. Provost C, Hamonic G, Gagnon CA, Meurens F. Dual infections of CD163 expressing NPTr epithelial cells with influenza A virus and PRRSV. Vet Microbiol. 2017;207:143-148.
25. Montoya M, Foni E, Solórzano A, et al. Expression dynamics of innate immunity in influenza virus-infected swine. Front Vet Sci. 2017;21:48.
26. Pomorska-Mol M, Markowska-Daniel I, Kwit K, et al. Immune and inflammatory response in pigs during acute influenza caused by H1N1 swine influenza virus. Arch Virol. 2014;159:26052614.
27. Choi C, Chae C. Expression of tumor necrosis factor-alpha is associated with apoptosis in lungs of pigs experimentally infected with porcine reproductive and respiratory syndrome virus. Res Vet Sci. 2002; 72:45-49.
28. Saco Y, Martínez-Lobo F, Cortey M, et al. C-reactive protein, haptoglobin and pig-major acute phase protein profiles of pigs infected experimentally by different isolates of porcine reproductive and respiratory syndrome virus. Vet Microbiol. 2016;183:9-15.


Descarga el PDF

Entrevista con Jesús Bollo sobre las propuestas vacunales de MSD Animal Health en relación a la mejora del manejo en las granjas porcinas a través del uso de nuevos programas vacunales.
Jesús Bollo, Product Manager Business Unit Swine en MSD Animal Health
En términos generales, nuestro objetivo es proveer productos biológicos que gocen de los mayores estándares de eficacia y seguridad con el fin último de ayudar a mejorar la salud y el bienestar de los animales.
Antes de responder a esta pregunta, primero debemos tener en cuenta la realidad de nuestras granjas donde, por un lado, el número de trabajadores en plantilla tiende a mantenerse estable a lo largo del tiempo y, por otro, concurren dos situaciones:
El aumento progresivo de producción de lechones que viene ocurriendo en los últimos años.
La tendencia general a ir incorporando nuevas referencias a los programas vacunales existentes, ya sea para evitar problemas sanitarios derivados de la reducción del uso de antibióticos, o bien, por la existencia de nuevas alternativas vacunales que sirven para mejorar los datos zootécnicos de nuestras granjas.

Como es lógico, para evitar posibles problemas de eficacia y seguridad de los productos aplicados, estos se deben utilizar de acuerdo con sus especificaciones. No obstante, existe el riesgo de que, a medida que se vayan añadiendo más referencias o variables al programa vacunal, puedan aumentar las posibilidades de que suceda alguna incidencia durante su implementación, siendo una situación que podría afectar a los resultados esperados. Por ello, debemos trabajar y mejorar en todo lo referente a hacer más fácil el manejo de las vacunas para todos aquellos que vayan a aplicarlas.
Lo más importante y evidente a la hora de plantear un plan vacunal es realizar previamente una evaluación sanitaria de la granja y decidir en base a sus necesidades.
En cuanto al tema que nos ocupa, en un primer lugar nos condicionará el número y calidad de los operarios disponibles en el momento de la vacunación, pues debemos ser conscientes de que, si en condiciones normales de vacunación la situación es apurada, en el caso de que coincidan vacaciones o bajas de trabajadores, la situación se podría complicar.
En segundo lugar, estarían las características del programa de vacunación en cuestión, que hagan más o menos fácil su adecuada ejecución. Aquí hemos de tener en cuenta:
El número de inyecciones a aplicar.
Edad y peso de los animales a vacunar.
Ruta de administración del producto (oral, intramuscular o intradérmica).

El diseño de las instalaciones del lugar donde se llevará a cabo la vacunación.
Si volvemos la vista unos años atrás, en lo referente a vacunas registradas para lechones, inicialmente había muy pocas referencias y eran vacunas monovalentes con una pauta de aplicación bidosis, lo que implica la necesidad de realizar dos manejos diferentes para inmunizar frente a una única patología, teniendo como ejemplo, la vacunación frente a Mycoplasma hyopneumoniae (M. hyopneumoniae).
En los últimos años hemos vivido una gran revolución en lo referente a programas vacunales y MSD Animal Health ha tenido un especial protagonismo, pues ha sido pionero en muchos de los avances conseguidos:
REGISTRO DE VACUNAS DE PAUTA MONODOSIS
REGISTRO DE VACUNAS DE PAUTA MONODOSIS
Gracias a nuevas formulaciones del producto, a pesar de aplicarse una única inyección es posible conseguir una duración de inmunidad muy elevada, reduciendo en definitiva el número de aplicaciones que se venían realizando tiempo atrás.
MSD Animal Health ha sido la primera empresa del sector farmacéutico en proporcionar al mercado la posibilidad de utilizar la vía intradérmica (ID) en productos que previamente solo se podían aplicar vía intramuscular.
Aquí tendríamos los casos de Circovirus porcino tipo 2 (PCV2), M. hyopneumoniae, PRRS y virus de la enfermedad de Aujeszky. Además, próximamente también se dispondrá de una versión ID para la vacunación frente a Lawsonia intracellularis (L. intracellularis).
El registro de Porcilis® Ery+Parvo+Lepto supuso una auténtica revolución dentro del vademécum de productos biológicos registrados para el ganado porcino, ya que, ante el predominio de las vacunas a base de uno o dos antígenos, el hecho de lanzar una vacuna que incluye 8 antígenos diferentes, sin ningún lugar a dudas, supuso un gran paso adelante.
En lo referente a vacunas multivalentes, y volviendo de nuevo a productos dirigidos a los lechones, MSD Animal Health fue la primera compañía en lanzar una vacuna bivalente basada en PCV2 y M. hyopneumoniae.
Este registro generó un antes y un después, ya que hablamos de dos vacunas que se venían aplicando de forma sistemática en la mayor parte de las granjas de nuestro país y, además, en muchos de los casos el momento de vacunación coincidía en el tiempo.
Un producto con estas características de manejo y que a la vez mantuviera inalterados elevados niveles de eficacia y seguridad, era algo muy demandado y esperado en nuestro sector, prueba de ello es que Porcilis® PCV M Hyo se ha convertido en una vacuna de referencia en el mercado, ya que, solo en España durante el año 2020 fueron vacunados aproximadamente 13 millones de lechones.
PORCILIS® PCV M HYO ES UNA VACUNA DE REFERENCIA EN EL MERCADO, CON 13
MILLONES DE LECHONES VACUNADOS EN 2020
REGISTROS DE NUEVAS VACUNAS PARA APLICACIÓN A TRAVÉS DE LA RUTA INTRAMUSCULAR
REGISTROS DE NUEVAS VACUNAS PARA APLICACIÓN A TRAVÉS DE LA RUTA INTRAMUSCULAR
En relación al registro de nuevas vacunas de aplicación intramuscular, tenemos el ejemplo de Porcilis® Lawsonia, ya que antes de disponer de esta vacuna solamente existía la posibilidad de inmunizar a través de la vía oral.

La posibilidad de inmunizar frente a la ileítis porcina utilizando la vía intramuscular ha servido para ofrecer una nueva alternativa en cuanto al manejo, ofreciendo un programa más sencillo para muchas de las granjas.
REGISTRO DEL USO
REGISTRO DEL USO MEZCLADO DE VACUNAS
DE VACUNAS
Se ha demostrado que, tras la mezcla y aplicación conjunta de dos vacunas diferentes, existe una perfecta compatibilidad y, de nuevo, se mantienen los niveles de eficacia y seguridad esperados y deseados. En este sentido, ya contábamos con precedentes como la posibilidad de excipientar Porcilis® PRRS junto con la vacuna Porcilis® M. Hyo.
En este caso, una novedad relativamente reciente ha sido conseguir el registro que permite la posibilidad de aplicar de forma conjunta Porcilis® PCV M Hyo junto con Porcilis® Lawsonia. De esta manera, con una única inyección y manejo estaríamos inmunizando frente a 3 de las patologías más relevantes del cerdo en crecimiento (PCV2, M. hyopneumoniae y L. intracellularis).
Por último, se da el caso de que un registro confirme la posibilidad de poder usar en un mismo día (mismo manejo de los animales) dos productos aplicados en puntos de inoculación diferentes.

En este caso estaríamos hablando de la posibilidad de utilizar Porcilis® PCV M Hyo y/o Porcilis® Lawsonia de forma simultánea a la vacunación con Porcilis® PRRS.
En el caso de utilizar estas 3 vacunas de forma simultánea, logramos inmunizar en un único manejo de animales (2 inoculaciones) frente a 4 de las enfermedades más relevantes de los animales en crecimiento (PCV2, M. hyopneumoniae, L. intracellularis y PRRS). Además, este programa proporciona versatilidad, pues en función de las necesidades de cada granja, se podría aplicar el programa (número de vacunas) más conveniente a cada caso.
¿EXISTE ALGUNA POSIBILIDAD DE MONITORIZAR LA ADECUADA IMPLEMENTACIÓN DE ESTAS VACUNAS?
En efecto, es importante monitorizar la correcta aplicación de las vacunas, pues se trata de un aspecto crítico, ya que hay muchas granjas o empresas donde unas pocas personas son responsables de la vacunación de miles de animales.
EL DEPARTAMENTO TÉCNICO

DE MSD ANIMAL HEALTH SE ENCUENTRA DISPONIBLE
PARA RESOLVER CUALQUIER
TIPO DE DUDA RESPECTO A LA MONITORIZACIÓN DE LA INMUNIZACIÓN
En este sentido, es ampliamente conocido que las tres vacunas del porfolio de MSD Animal Health frente a PCV2, en el caso de realizar una simple serología, muestran una seroconversión postvacunación frente a este agente, al igual que ocurre con Porcilis® Lawsonia.

En MSD Animal Health innovamos para poner a disposición del sector porcino vacunas eficaces y seguras que permitan reducir el manejo en las granjas, optimizando recursos y ayudando a mejorar el bienestar animal.
Recientemente se ha conseguido un registro único, gracias al cual, con un solo manejo de los animales es posible inmunizar frente hasta 4 de las principales enfermedades que afectan al ganado porcino.
LLa especie porcina es muy sensible a la toxicidad asociada a la exposición a las micotoxinas. Si bien, las principales micotoxinas y sus metabolitos han sido estudiadas en profundidad, también es necesario prestar atención a las “micotoxinas enmascaradas”, formas conjugadas de estas toxinas que pueden pasar desapercibidas en los análisis rutinarios, y a las “micotoxinas emergentes” potencialmente tóxicos para los cerdos.
MICOTOXINAS PRINCIPALES

Entre los animales de producción, el cerdo es una de las especies más sensibles a las micotoxinas1 Hasta la fecha, la atención se ha centrado en las principales micotoxinas que tienen efectos tóxicos en esta especie, con especial atención al deoxinivalenol (DON), la zearalenona (ZEN), las fumonisinas (FBs, especialmente FB1), las aflatoxinas (AFs, sobre todo AFB1), la ocratoxina A (OTA) y la toxina T2, producidas por diversos hongos, como
Aspergillus, Fusarium y Penicillium, ya que parecen representar la mayor amenaza para la salud y productividad de los cerdos en todo el mundo, y ocupan con razón la mayor parte de la investigación en ese campo científico. En relación a estas micotoxinas, también se investigan algunos de sus metabolitos, como la α-o β-zearalenol y el 3- y 15-acetil-DON por su potencial tóxico.

Panagiotis Tassis
Profesor Adjunto de Medicina y Reproducción
Porcina Clínica de Animales de Producción, Facultad de Medicina Veterinaria de la Universidad
Aristóteles de Tesalónica, Grecia
Además de las micotoxinas mencionadas, también existe la posible carga tóxica adicional ocasionada por sus formas conjugadas, también llamadas “micotoxinas enmascaradas”. Algunos de estos metabolitos son difíciles de evaluar mediante técnicas analíticas convencionales o pueden “pasar desapercibidos” en la evaluación rutinaria de los piensos.
Las principales micotoxinas enmascaradas son el deoxinivalenol-3- β -d-glucósido (DON-3-Glc), la zearalenona-14- β -d-glucopiranósido (ZEN-14-G) y la ZEN 16G2-4 Dichas formas son probablemente hidrolizadas en sus formas libres por los microorganismos intestinales en los mamíferos y, por tanto, representan una toxicidad imprevista5

Una tercera categoría de micotoxinas recientemente evaluada es la de las “micotoxinas emergentes”. Basado en su primera descripción en 20086, el término se refiere a las micotoxinas que no están reguladas legislativamente y que no suelen incluirse en los análisis rutinarios. Los principales representantes de esta categoría son las enniatinas (ENNs), la beauvericina (BEA) y la moniliformina (MON), además de muchos metabolitos fúngicos como los precursores de las aflatoxinas (esterigmatocistina, averufina, etc.) y los alcaloides ergóticos.
La presente revisión se centrará en las enniatinas, la beauvericina y la moniliformina.
Un estudio global a gran escala de análisis de piensos puso de manifiesto que la BEA, las ENNs y la MON son micotoxinas emergentes que aparecen con frecuencia en comparación con los precursores de aflatoxinas y alcaloides ergóticos.
MON y BEA aparecieron en el 79% y el 83% de las muestras, respectivamente, mientras que las ENN eran omnipresentes en las muestras de piensos finalizados. Concretamente, ENN A, A1, B y B1 estaban presentes en el 32%, 59%, 71% y 69% de las muestras, respectivamente (subconjunto de 1.113 muestras de piensos finalizados, maíz y ensilado de maíz de 1.926 muestras de 46 países recogidas entre 2012 y 2015)7
Según un estudio de Khoshal et al.8 , tras el análisis de 524 muestras de piensos para cerdos de engorde de todo el mundo, las 10 micotoxinas emergentes más prevalentes son:
Brevianamida F
Ciclo-(L-Pro-L-Tyr)
Triptofol
Enniatina A1
Enniatina B
LEGISLATIVAMENTE Y QUE NO SUELEN INCLUIRSE EN LOS ANÁLISIS RUTINARIOS
Enniatina B1
Emodina
Aurofusarina
Beauvericina
Apicidina
No se han establecido límites para la concentración de micotoxinas emergentes, pero la EFSA ha señalado la presencia de BEA y ENNs en los piensos a niveles elevados9
La contaminación simultánea de los granos por múltiples micotoxinas es más una tendencia que una excepción y la cromatografía líquida-espectrometría de masas (LC-MS) parece ser la principal herramienta para el hallazgo de nuevas formas, enmascaradas o modificadas, de micotoxinas10
Los cerdos pueden enfrentarse a la ingestión de granos contaminados con micotoxinas principales, formas enmascaradas y micotoxinas emergentes que pueden inducir varios efectos tóxicos combinados. A diferencia de las “micotoxinas principales”, actualmente no se han establecido unos niveles máximos u orientativos para las formas enmascaradas y emergentes.
ACTUALMENTE NO SE HAN ESTABLECIDO NIVELES MÁXIMOS U ORIENTATIVOS PARA MICOTOXINAS ENMASCARADAS Y EMERGENTES QUE PUEDEN SER UN RIESGO PARA EL PORCINO

–MECANISMOS DE ACCIÓN Y EFFECTOS
Las ENNs aparecen principalmente en los cereales y son producidas por varias cepas de Fusarium (F. acuminatum, avenaceum, langsethiae, lateritium, poae, proliferatum, sambucinum, sporotrichioides, tricinctum), así como por cepas de los géneros Alternaria, Halosarpheia y Verticillium 11,12
Se conocen aproximadamente 29 tipos de ENNs, detectándose con mayor frecuencia las ENNs A, A1, B y B1 en alimentos y piensos13
En 2014, las ENNs se encontraron con unas concentraciones medias de 250 μg/kg en Europa, a niveles similares a los del DON y el ZEN7 Además, hay que tener en cuenta que estos compuestos pueden entrar en el cuerpo a través de la piel, con una capacidad de penetración superior a la BEA14
Se han descrito también varios metabolitos de los ENNs en varias especies, entre ellos, los metabolitos monoxigenados, dioxigenados y N-desmetilados10
Las ENNs poseen numerosos efectos biológicos, incluyendo propiedades citotóxicas (muerte celular), antivirales, antibacterianas, antifúngicas, insecticidas, antihelmínticas, herbicidas/fitotóxicas, anticancerígenas e inmunotóxicas6,15
Las propiedades ionóforas de las ENNs son la base de su potencia tóxica. Debido a su naturaleza lipofílica pueden incorporarse a las bicapas lipídicas de las membranas celulares, creando poros selectivos de cationes que provocan un aumento de la permeabilidad para estos iones. Como resultado, se producen alteraciones en concentración celular fisiológica de cationes16.

Otro de sus efectos celulares-mo leculares es la desestabilización de la proteína 2 de membrana asociadas al lisosoma (LAMP-2) lo que provoca la alcalinización de los lisosomas y la permeabilización parcial de la membrana lisosomal así como la inducción de un efecto hipolipemiante celular. Este efecto se relaciona con la inhibición enzimática asociada a las ENNs y la disminución de la síntesis de triglicéridos.

Alteración del equilibrio iónico celular
Alteración de la función de los lisosomas

FIGURA 1

Efectos particulares de las Enniatinas a nivel celular-molecular. (A) La naturaleza lipofílica de las ENNs permite que se incorporen a la membrana celular, formando una estructura dimérica capaz de transportar iones a través de la membrana celular, alterando el equilibrio iónico de la célula. (B) La desestabilización de la proteína 2 de membrana asociadas al lisosoma (LAMP-2) conduce a la alcalinización y permeabilización de los lisosomas.

Hasta la fecha se ha demostrado la citotoxicidad asociada a las ENNs en diversas líneas celulares, estando la muerte celular mediada por la inducción de la apoptosis (vía mitocondrial) o la necrosis celular (daño lisosomal). También se ha sugerido que las ENNs son capaces de reducir la motilidad espermática en verracos, al tiempo que interactúan con las proteínas de diferentes formas10
En el estudio de Khosal et al.8 , se constató la citotoxicidad de 10 micotoxinas emergentes y del DON tras la evaluación in vitro de la viabilidad de células epiteliales porcinas intestinales (IPEC-1) en el siguiente orden de toxicidad: Apicidina > Enniatina A1
> DON > Beauvericina > Enniatina
B > Enniatina B1 > Emodina > Aurofusarina.
Un estudio en cerdos puso de manifiesto la alta biodisponibilidad oral (∼91%) y la rápida absorción (concentración plasmática máxima 15 minutos después de la administración oral), metabolización, distribución y eliminación de las ENN, lo que contribuye a su baja toxicidad general in vivo 18
Un estudio realizado en ratones reveló que las ENNs atraviesan rápidamente la barrera hematoencefálica (BHE) tras su administración intravenosa siguiendo un modelo de proceso bifásico con altas tasas de afluencia inicial seguidas de una fase de meseta. Se observó una distribución considerable en el parénquima cerebral sin indicios significativos de metabolización cerebral ni un eflujo cerebral significativo a la sangre19
Otro estudio in vitro sobre ENN B y B1 en un modelo de sistema porcino volvió a confirmar la transferencia con altas tasas de flujo a través de la BHE, por lo que no se puede descartar que tengan efectos neurotóxicos20
Hasta la fecha, la toxicidad in vitro de las ENNs está probada, pero los datos in vivo dan como resultado una potencia tóxica leve.
La BEA también es producida por varias especies de Fusarium (F. acuminatum, armeniacum, anthophilum, avenaceum, bulbicola, beomiforme, denticulatum, dlamini, equiseti, fujikuroi, globosum, lactis, langsethiae, longipes, nygamai, oxysporum, phyllophillum, poae, proliferatum, pseudoanthophilum, pseudocircinatum, sambucinum, semitectum, sporotrichioides, subglutinans, succisae, verticillioides) y puede detectarse en diferentes granos como el trigo, la avena, la cebada y el centeno11,12,21.
De forma similar a las ENNs, los estudios in vitro sugieren un potencial tóxico de la BEA, incluyendo muerte celular mediada por apoptosis (vía mitocondrial) o por necrosis También se han señalado sus propiedades mutagénicas y su capacidad para afectar a las células inmunitarias in vitro, estando sus propiedades ionóforas relacionadas con los mecanismos subyacentes a su toxicidad10
En la Figura 2 se presenta una cadena de eventos celulares basada en la revisión de Fraeyman et al. 22 Los mecanismos particulares implicados son15:
Interrupción de la progresión del ciclo celular (bloqueo del ciclo celular), apoptosis e inducción del estrés oxidativo.
Genotoxicidad.
Inmunotoxicidad.
Daño mitocondrial.
Inhibición de la actividad de la acil-CoA colesteroltransferasa (ACAT).
Interacción con transportadores dependientes de ATP o transportadores ABC (del inglés, ATP-binding cassette).
Inhibición de la actividad del citocromo P450 (CYP3A4/5, CYP2C19, CYP3A1/2).
LAS ENNIATINAS SE CARACTERIZAN POR SUS PROPIEDADES IONÓFORAS Y CITOTÓXICAS, CON UNA ALTA BIODISPONIBILIDAD ORAL Y RÁPIDA METABOLIZACION, DISTRIBUCIÓN Y ELIMINACIÓN
Desencadena-

Inserción de BEA y ENN en la membrana celular
Formación de poros selectivos de cationes
Influencia en la homeostasis iónica celular
Aumento del Ca2+ intracelular
Estimulación de la producción de especies reactivas de oxígeno (ROS)
Inducción de la peroxidación lipídica y depleción del nivel de glutatión
Según la revisión de Bertero et al.15 , la BEA es considerada como un potente compuesto bioactivo con actividad antibacteriana, antiviral, antifúngica, insecticida, antihelmíntica, fitotóxica, disruptora del sistema endocrino y anticancerígena.
Desde el punto de vista negativo, la BEA puede inducir efectos antagónicos de alteración endocrina, inhibición enzimática intracelular y estrés oxidativo, mientras que se ha comprobado que bajas concentraciones micromolares de BEA tienen efectos citotóxicos sobre diferentes líneas celulares de mamíferos in vitro. Esta citotoxicidad depende de la dosis, la duración y la forma de exposición, ya que también se ha señalado su baja capacidad de penetración cutánea14,23.
Por otra parte, la BEA puede tener efectos antifúngicos, antivirales o antibióticos12,24,25. Se ha demostrado su gran actividad antibacteriana (inhibitoria) en técnicas de bioensayo microbiano frente a Clostridium perfrigens , observándose que esta inhibición fue mayor en bacterias Gram positivas que en bacterias Gram negativas12
Necrosis
Al igual que en el caso de las ENNs, también se ha observado la capacidad de la BEA de atravesar la BHE en un estudio con ratones19 Asimismo, se ha sugerido un efecto tóxico asociado a la BEA y las ENNs sobre el sistema reproductivo, ya que la BEA puede perjudicar el desarrollo de ovocitos porcinos cultivados y de los embriones tempranos22.
Por otro lado, Ficheux et al2 6 señalan los efectos inmunomoduladores de la BEA y las ENNs. Concretamente, la BEA y la ENN B pueden reducir la endocitosis por parte de los macrófagos y aumentar la secreción de IL-10, además de afectar al inicio de la respuesta inmunitaria adaptativa al interferir en la migración de las células dendríticas.
EFECTOS ANTIMICROBIANOS DE LA BEA Y LAS ENNs DEBEN TENERSE EN CUENTA EN RELACIÓN A SU POSIBLE IMPACTO EN LA
La MON también es producida por varias cepas de Fusarium (F. acuminatum, avenaceum, culmorum, equiseti, fujikuroi, napiforme, nygamai, oxysporum, proliferatum, pseudonygamai, sporotrichioides, subglutinans, thapsinum, tricinctum, verticillioides) y puede encontrarse en distintos cereales11,27
Según los datos de toxicidad revisados por la EFSA27, existe un bajo riesgo para los cerdos en relación a la presencia de MON en los piensos teniendo en cuenta los niveles de exposición estimados según las prácticas alimentarias actuales.
Los efectos tóxicos de la MON se relacionan con la inactivación de las enzimas dependientes de la tiamina, incluida la piruvato deshidrogenasa, lo que da lugar a la formación de acetil-CoA (utilizado en el ciclo de Krebs), afectando así al suministro de energía celular22 Además, según Behrens et al. 28 , la MON también es capaz de atravesar la BHE.
La MON puede afectar al sistema inmunitario al alterar la diferenciación de los monocitos en células dendríticas y macrófagos26 También se ha señalado su hematotoxicidad, observándose una disminución del hematocrito (HCT) y de los niveles de hemoglobina (Hb), siendo estos los efectos adversos crónicos más importantes asociados a la MON en cerdos.
Otros efectos adversos de esta micotoxina para la salud de los cerdos incluyen la disminución de la ganancia de peso, efectos hematológicos, cardiotoxicidad y mortalidad acompañada de lesiones cardíacas27
Wei et al . describieron una respuesta humoral reducida tras la vacunación frente a la Peste Porcina en lechones alimentados con una dieta contaminada [extracto de MON de material de cultivo de Fusarium (30 mg MON/kg)]29
Anteriormente, los estudios de Harvey et al. 30,31 , tras alimentar a cerdos con piensos contaminados con MON (25-200 mg de MON/kg de pienso), mostraron una reducción del peso corporal con la ingestión de 100 mg de MON/kg de pienso, demostrándose asimismo una reducción del número de glóbulos rojos, del HCT y de los niveles de Hb tras la ingestión de piensos contaminados con 50 mg de MON/ kg de pienso y superiores.
En los mismos estudios se observó una mortalidad significativa en el grupo que recibió 200 mg de MON/kg de alimento, mientras que 100 mg de MON/kg de alimento fue el nivel de contaminación más bajo que indujo la mortalidad. La cardiomegalia fue el hallazgo post mortem más consistente en los casos de mortalidad. Además, se observó un líquido de color pajizo en los sacos pericárdicos en los cerdos muertos de forma aguda.
En base a los estudios mencionados, se sugiere un nivel de efecto adverso no observado (NOAEL, del inglés no-observed-adverse-effect level ) en relación a la reducción de la ganancia de peso corporal en los cerdos a un nivel de contaminación de los piensos de 50 mg de MON/ kg de pienso y un nivel de efecto adverso mínimo observado (LOAEL, del inglés lowest-observed-adverse effect level ) a 100 mg de MON/kg de pienso.
En cuanto a los efectos adversos hematológicos, se sugirió un NOAEL a 25 mg de MON/kg de pienso y un LOAEL a 50 mg de MON/kg de pienso. Sin embargo, se ha establecido un punto de referencia de 0,20 mg de MON/kg de peso corporal/día para la hematotoxicidad (disminución del HCT y Hb) asociada a la exposición a MON como indicativo de posibles efectos adversos para la salud, lo que representa el criterio de valoración más sensible para los cerdos27
En conjunto, la disminución de la ganancia de peso, los efectos hematológicos adversos y la mortalidad acompañada de lesiones cardíacas se identifican como efectos adversos críticos para la salud de los cerdos tras la ingestión de piensos contaminados con MON.
De acuerdo con la revisión de Smith et al.11 sobre la contaminación natural de alimentos y piensos con micotoxinas, se sugirió que las mezclas más frecuentes de micotoxinas emergentes incluyen:
ENNs + BEA
ENNs + Fusarenon X
ENNs + DON
ENNs + ZEN
BEA + ENNs + Fusarenon X
BEA + ENNs + MON
BEA + ENNs +NIV (nivalenol) +
ZEN
BEA + NIV
BEA + Fusarenon X
BEA + ENNs + AFs
BEA + Fusarenon X
BEA + ENNs + Fusarenon X
FB + BEA + OTA
FB + Fusarenon X + BEA
BEA + ENNs +T2 + HT2
MON + FB
BEA + DON
Los estudios in vitro sugieren un mecanismo de acción sinérgico de BEA + DON en los progenitores hematopoyéticos y un efecto antagónico en las células ováricas de hámster y en las células epiteliales de riñón de mono.
Las mezclas de la toxina BEA + T2, así como de BEA + T2 + DON tienen efectos sinérgicos en las células ováricas de hámster y antagónicos en las células epiteliales de riñón de mono.
Los efectos de BEA + FB1 en las células epiteliales de los túbulos renales proximales porcinos son aditivos a dosis bajas y antagónicos a la dosis más alta.
La interacción in vitro de una mezcla de las micotoxinas emergentes ENNs + BEA es sinérgica.
Los efectos in vitro de varias mezclas de ENNs (A, A1, B, B1) en células ováricas de hámster o en células de adenocarcinoma colorrectal epitelial humano (Caco-2) dio lugar a efectos sinérgicos, aditivos o antagónicos dependiendo del modelo celular, la combinación de toxinas y de la dosificación utilizada11
En otro estudio8, la comparación de la toxicidad individual entre ENNs y DON sugirió que ENN B1 reducía la viabilidad de las IPEC-1 en menor medida que la de DON, mientras que ENN B mostró un nivel de toxicidad cercano al de DON, y ENN A1 fue más tóxico que DON. Además, la evaluación de la toxicidad de DON y ENNs o de mezclas de DON y BEA sugirió una toxicidad similar o menor de cada mezcla que la toxicidad de DON por sí solo.
Finalmente, la ENN B1 y la toxina T-2 mostraron un efecto tóxico antagónico in vitro que podría estar relacionado con la capacidad de la ENN B1 de modular a la baja la toxicidad gastrointestinal de la toxina T-232.
Debido a su susceptibilidad relativamente alta a las toxinas de Fusarium y a los ionóforos, se considera que los cerdos son posiblemente más susceptibles a las ENN y a los efectos de la BEA (EFSA 2014 ).
Las micotoxinas emergentes pueden detectarse en una variedad de granos y poseen una amplia gama de actividades biológicas. Por ello, es necesario concienciar sobre este tema por el reto que supone el cambio climático en cuanto a la seguridad alimentaria y de los piensos.
Es bastante evidente que las micotoxinas emergentes a menudo pueden formar parte de una mezcla de dos o más micotoxinas que contaminan los ingredientes de los piensos. Hasta ahora, sus interacciones in vivo con otras micotoxinas no han sido totalmente aclaradas, por lo que también deben tenerse en cuenta como factores que contribuyen a los efectos tóxicos generales de la ingestión de mezclas de micotoxinas en los cerdos. Los efectos de la toxicidad combinada son muy difíciles de predecir, especialmente en los casos de exposición crónica a concentraciones de micotoxinas subtóxicas.
UNOS PROCEDIMIENTOS DE MUESTREO ADECUADOS, MÁS ESTUDIOS PERTINENTES Y NUEVOS MÉTODOS ANALÍTICOS FIABLES PUEDEN AYUDAR A
REVELAR LA COMPLEJA TOXICIDAD DE ESTOS COMPUESTOS Y LA
POSIBLE INTERACCIÓN ENTRE LAS DIFERENTES MICOTOXINAS PRESENTES EN CADA MATRIZ
1.Pierron, A.; Alassane-Kpembi, I.; Oswald, I.P. Impact of mycotoxin on immune response and consequences for pig health. Anim. Nutr. 2016, 2, 63–68.
2.Dänicke, S.; Brezina, U. Kinetics and metabolism of the Fusarium toxin deoxynivalenol in farm animals: Consequences for diagnosis of exposure and intoxication and carry over. Food Chem. Toxicol. 2013, 60, 58–75, doi:10.1016/j.fct.2013.07.017
3.Danicke, S.; Winkler, J. Invited review: Diagnosis of zearalenone (ZEN) exposure of farm animals and transfer of its residues into edible tissues (carry over). Food Chem. Toxicol. 2015, 84, 225–249, doi:10.1016/j. fct.2015.08.009.
4.Nagl V., Schatzmayr G. Deoxynivalenol and its masked forms in food and feed. Current Opinion in Food Science. Volume 5, 2015,Pages 43-49, https://doi. org/10.1016/j.cofs.2015.08.001.
5.Zhang Z., Nie D., Fan K., Yang J., Guo W., Meng J., Zhao Z., Han Z. (2020) A systematic review of plant-conjugated masked mycotoxins: Occurrence, toxicology, and metabolism, Critical Reviews in Food Science and Nutrition, 60:9, 1523-1537, doi: 10.1080/10408398.2019.1578944.
6.Jestoi, M. Emerging Fusarium mycotoxins fusaproliferin, beauvericin, enniatins, and moniliformin − a review. Crit. Rev. Food Sci. Nutr. 2008, 48, 21−49.
7.Kovalsky P, Kos G, Nährer K, Schwab C, Jenkins T, Schatzmayr G, Sulyok M, Krska R. Co-Occurrence of Regulated, Masked and Emerging Mycotoxins and Secondary Metabolites in Finished Feed and Maize-An Extensive Survey. Toxins (Basel). 2016 Dec 6;8(12):363. doi: 10.3390/toxins8120363.
8.Khoshal, A.K.; Novak, B.; Martin, P.G.P.; Jenkins, T.; Neves, M.; Schatzmayr, G.; Oswald, I.P.; Pinton, P. Co-Occurrence of DON and Emerging Mycotoxins in Worldwide Finished Pig Feed and Their Combined Toxicity in Intestinal Cells. Toxins 2019, 11, 727. https:// doi.org/10.3390/toxins11120727.
9.EFSA Panel on Contaminants in the Food Chain (CONTAM). Scientific Opinion on the risks to human and animal health related to the presence of beauvericin and enniatins in food and feed. EFSA J. 2014, 12, 3802. doi:10.2903/j.efsa.2014.3802.
10.Gruber-Dorninger, C.; Novak, B.; Nagl, V.; Berthiller, F. Emerging Mycotoxins: Beyond Traditionally Determined Food Contaminants. J. Agric. Food Chem. 2017, 65, 7052–7070.
11.Smith, M.-C.; Madec, S.; Coton, E.; Hymery, N. Natural Co-Occurrence
2016, 8, 94. https://doi.org/10.3390/ toxins8040094.
12.K
L., Dadáková, K., Dv ořá čková, M., & Kašparovský, T. (2021). Feedborne Mycotoxins Beauvericin and Enniatins and Livestock Animals. Toxins, 13(1), 32. https://doi.org/10.3390/ toxins13010032.
13.Ivanova L, Egge-Jacobsen WM, Solhaug A, Thoen E, Faeste CK. Lysosomes as a possible target of enniatin B-induced toxicity in Caco-2 cells. Chem Res Toxicol (2012) 25(8):1662–74. doi:10.1021/tx300114x
14.Taevernier, L.; Veryser, L.; Roche, N.; Peremans, K.; Burvenich, C.; Delesalle, C.; De Spiegeleer, B. Human skin permeation of emerging mycotoxins (beauvericin and enniatins). J. Expo. Sci. Environ. Epidemiol. 2016, 26, 277–287.
15.Bertero, A.; Fossati, P.; Tedesco, D.E.A.; Caloni, F. Beauvericin and Enniatins: In Vitro Intestinal Effects. Toxins 2020, 12, 686. https://doi.org/10.3390/ toxins12110686.
16.Tonshin AA, Teplova VV, Andersson MA, Salkinoja-Salonen MS. The Fusarium mycotoxins enniatins and beauvericin cause mitochondrial dysfunction by affecting the mitochondrial volume regulation, oxidative phosphorylation and ion homeostasis. Toxicology (2010) 276(1):49–57. doi:10.1016/j. tox.2010.07.001.
17.Oliveira, C.A.F.; Ivanova, L.; Solhaug, A.; Fæste, C.K. Enniatin B1-Induced Lysosomal Membrane Permeabilization in Mouse Embryonic Fibroblasts. Mycotoxin Res. 2020, 36, 23–30.
18.Devreese, M., Broekaert, N., De Mil, T., Fraeyman, S., De Backer, P., Croubels, S., 2014. Pilot toxicokinetic study and absolute oral bioavailability of the Fusarium mycotoxin enniatin B1 in pigs. Food Chem. Toxicol. 63, 161e165.
19.Taevernier L, Bracke N, Veryser L, Wynendaele E, Gevaert B, Peremans K, et al. Blood-brain barrier transport kinetics of the cyclic depsipeptide mycotoxins beauvericin and enniatins. Toxicology Letters 2016; 258: 175±184 [https://doi.org/10.1016/j. toxlet.2016.06.1741.
20.Krug I, Behrens M, Esselen M, Humpf HU (2018) Transport of enniatin B and enniatin B1 across the blood-brain barrier and hints for neurotoxic effects in cerebral cells. PLOS ONE 13(5): e0197406. https://doi. org/10.1371/journal.pone.0197406.
21.Santini, A.; Meca, G.; Uhlig, S.; Ritieni, A. Fusaproliferin, beauvericin and enniatins: Occurrence in food—A review. World Mycotoxin J. 2012, 5, 71–81.
22.Fraeyman, S.; Croubels, S.; Devreese, M.; Antonissen, G. Emerging Fusarium and Alternaria Mycotoxins: Occurrence, Toxicity and Toxicokinetics. Toxins 2017, 9, 228. https://doi.org/10.3390/ toxins9070228.
23.Macchia, L.; Caiffa, M.F.; Fornelli, F.; Calo, L.; Nenna, S.; Moretti, A.; Logrieco, A.; Tursi, A. Apoptosis induced by the Fusarium mycotoxin beauvericin in mammalian cells. Appl. Genet. 2002, 43, 363–371.
24.Olleik, H.; Nicoletti, C.; Lafond, M.; Courvoisier-Dezord, E.; Xue, P.; Hijazi, A.; Baydoun, E.; Perrier, J.; Maresca, M. Comparative Structure–Activity Analysis of the Antimicrobial Activity, Cytotoxicity, and Mechanism of Action of the Fungal Cyclohexadepsipeptides Enniatins and Beauvericin. Toxins 2019, 11, 514.
25.Escrivá, L.; Font, G.; Manyes, L. In vivo toxicity studies of fusarium mycotoxins in the last decade: A review. Food Chem. Toxicol. 2015, 78, 185–206.
26.Ficheux, A.S.; Sibiril, Y.; Parent-Massin, D. Effects of beauvericin, enniatin b and moniliformin on human dendritic cells and macrophages: An in vitro study. Toxicon 2013, 71, 1–10.
27.EFSA Panel on Contaminants in the Food Chain (CONTAM). Scientific Opinion on the risks to human and animal health related to the presence of moniliformin in food and feed. EFSA J. 2018;16(3):5082. doi: 10.2903/j.efsa.2018.5082.
28.Behrens M, Hüwel S, Galla H-J, Humpf H-U (2015) Blood-Brain Barrier Effects of the Fusarium Mycotoxins Deoxynivalenol, 3 Acetyldeoxynivalenol, and Moniliformin and Their Transfer to the Brain. PLoS ONE 10(11): e0143640. doi:10.1371/journal. pone.0143640.
29.Wei W-k, Huang L-h,, Wang K, Tang Z-x, Wei X-h, Zhou Z-r and Luo S-j, 2010. Effects of moniliformin on antibody of virus of classical swine fever in weaned piglets. Guangdong Agricultural Science, 9, Article No.: 1004-874X (2010) 09-0032-02.
30.Harvey RB, Edrington TS, Kubena LF, Rottinghaus GE, Turk JR, Genovese KJ and Nisbet DJ, 2001. Toxicity of moniliformin from Fusarium fujikuroi culture material to growing barrows. Journal of food protection, 64, 1780–1784.
31.Harvey RB, Edrington TS, Kubena LF, Rottinghaus GE, Turk JR, Genovese KJ, Xiprin RL and Nisbet DJ, 2001. Toxicity of Fumonisin from Fusarium verticillioides Culture Material and Moniliformin from Fusarium fujikuroi Culture Material When Fed Singly and in Combination to Growing Barrows. Journal of Food Protection, Vol. 65, No. 2, 2002, Pages 373–377
32.Kolf-Clauw, M.; Sassahara, M.; Lucioli, J.; Rubira-Gerez, J.; Alassane-Kpembi, I.; Lyazhri, F.; Borin, C.; Oswald, I. P. The emerging mycotoxin, enniatin B1, down-modulates the gastrointestinal toxicity of T-2 toxin in vitro on intestinal epithelial cells and ex vivo on intestinal explants. Arch. Toxicol. 2013, 87, 2233−2241.
of Mycotoxins in Foods and Feeds and Their in vitro Combined Toxicological Effects. Toxins řížová,
Elcircovirusporcino(PCV)sehaconvertidoenunviruscomúnenlacabañaporcinamundial desdequefuedescritoporprimeravezen1974.Afinalesdeladécadadelos90,enNorteamérica surgióunnuevocircovirusgenéticamentedistintoalconocidohastaelmomentocomoPCV.El PCVoriginalsedenominóPCVtipo1,mientrasqueelPCVemergentesedenominóPCVtipo2.
Según el Departamento de Diagnóstico Veterinario y Medicina de Animales de Producción de la Facultad de Veterinaria de la Universidad Estatal de Iowa, la aparición del PCV2 coincidió con la aparición de un nuevo síndrome clínico del ganado porcino denominado Síndrome Multisistémico de Adelgazamiento Posdestete (PMWS - del inglés, Postweaning Multisystemic Wasting Syndrome).
Darin Madson, anteriormente en el Laboratorio de Diagnóstico Veterinario de ISU, señaló en un webinar de National Hog Farmer sobre el PCV2 que el virus se había encontrado en Canadá en la década de los 90, pero no se definió realmente hasta 1999. Fue entonces cuando se observó en toda Norteamérica y se comprendió que el PCV2 causaba enfermedad.
Kevin ShulzNational Hog FarmerDesde su aparición, el PCV2 se ha difundido ampliamente en las industrias porcinas más avanzadas de todo el mundo. El término PCVAD (Porcine Circovirus- Associated Disease) se utiliza actualmente en Norteamérica para referirse a las diferentes manifestaciones de la enfermedad asociadas al PCV2.
No fue hasta 2005-2007 en EE.UU., cuando los laboratorios de diagnóstico evidenciaron los años de alta incidencia de casos, “cuando realmente se afianzó y causó muchos problemas”. Al empezar a surgir problemas con el PCV2 en EE.UU., la situación hizo que las empresas farmacéuticas se dedicaran a desarrollar vacunas, “y en ese momento pudimos controlar el número de casos”.
La Dra. Meggan Bandrick, Directora Global de Investigación de Biológicos para Cerdos de Zoetis, alerta al sector porcino sobre el nuevo giro que el PCV2 está dando al panorama sanitario.

La industria porcina ha visto evolucionar los virus a lo largo del tiempo y el PCV2 no es una excepción. Hasta ahora se han identificado las variantes PCV2 a, b, c, d, e y f, pero la Dra. Bandrick cree que no se conoce del todo el alcance de la recombinación del PCV2 en el campo.
“La recombinación consiste en el intercambio de material genético entre organismos -en este caso, virus- que infectan a la misma célula. En el caso del PCV2, la recombinación puede producirse entre virus PCV2 muy parecidos o muy diferentes.
Pongamos el ejemplo de la recombinación entre PCV2a y PCV2b. El virus resultante será una mezcla de PCV2a y PCV2b al contener fragmentos de ambos”.
¿Por qué es preocupante que dos variantes de PCV2 se repliquen y formen una nueva versión de sí mismos dentro de una sola célula porcina?
La Dra. Bandrick señala que algunos de esos virus recombinantes actuarán de forma similar al virus parental, y ni siquiera se sabrá que hay un virus recombinante presente. El virus recombinante podría provocar el mismo tipo de signos clínicos que el virus original. Así que, en efecto, serían muy parecidos y no causarían ningún problema diferente.
En otros casos, los virus recombinantes son en realidad bastante diferentes de cualquiera de sus progenitores. Así que tener una parte del genoma de uno de los padres y otra parte del genoma del otro puede hacer que ese virus recombinante sea más resistente, con mejor capacidad de replicación o para causar enfermedad o con mayor capacidad para escapar de la respuesta inmunitaria.
Si se está vacunando para proteger frente a uno de los virus parentales y el virus recombinante ha heredado parte de un virus diferente, eso le da una ventaja sobre sus progenitores. Esa ventaja puede hacer que sea más capaz de escapar a la respuesta inmunitaria.
La recombinación no es algo nuevo en el mundo de los virus, ya
“Los resultados de los estudios muestran que

Según señala la Dra. Bandrick, existen informes sobre virus recombinantes que causan enfermedad y es probable que conozcamos esos casos porque fueron lo suficientemente graves como para que se publicaran.
“Si bien, es importante saber que se trata de virus recombinantes, notenemossuficienteinformaciónparasaber si todos los casos de enfermedad por PCV2 están causados por recombinantes o no.
Los veterinarios y los productores son conscientes de que la recombinación se produce. Sin embargo, actualmente la mayor parte del trabajo sobre los virus recombinantes se realiza a nivel académico.
Sin duda, los veterinarios y los productores son conscientes de que la recombinación se produce en el caso del virus PRRS y sabemos que el reordenamiento, pero no la recombinación, se produce en el caso de del virus de la gripe. Pero en lo que se refiere al PCV2, no se sabe del todo que puede recombinarse, ni hay una verdadera conciencia de lo diverso que es o de cuánto cambia. Yo diría que la tasa de evolución del PCV2 es realmente más alta de lo que nunca pensamos que sería”.
Por este motivo, la Dra. Bandrick confirma que hay más variabilidad en los virus PCV2 de lo que se pensaba, ya que:
1 2
Tiene una tasa de mutación realmente alta.
Tiene una gran capacidad de recombinación.
LOS VIRUS DE LOS GENOTIPOS PCV2 a, b Y d
SON LOS MÁS FRECUENTES, POR LO QUE LA MAYORÍA DE LOS RECOMBINANTES QUE SE
OBSERVAN SON COMBINACIONES DE a, b Y d
Artículotraducidoyadaptadode:RecombinantPCV2addsnewwrinkletocontrolprograms–NationalHogFarmer
La Dra. Bandrick señala que los productores y los veterinarios deben saber qué virus PCV2 está circulando en la granja, si es del genotipo a, el b o el d, siendo importante evaluar la edad de los animales afectados y los signos clínicos que se observan para poder revisar su programa de vacunación.
“Si tienes problemas que no puedes controlar, puede merecer la pena una secuenciación adicional. Si este análisis revela que tienes más de un tipo de PCV2, es probable que también tengas virus recombinantes. En cualquier caso, si en una granja se encuentran virus recombinantes, la mejor forma de prepararse es mediante un programa de vacunación”.
LA MEJOR MANERA DE ESTAR PREPARADO PARA EL PCV2 Y PARA LOS CAMBIOS GENÉTICOS QUE
SABEMOS QUE
VENDRÁN ES VACUNAR
“Se debe vacunar con algo que ofrezca la más amplia cobertura frente la gran variabilidad que existe entre los PCV2. Esto permitirá educar al sistema inmunitario de modo que el cerdo esté protegido frente a una variedad de PCV2, siendo importante utilizar una vacuna que permita que menos virus PCV2 escapen a la respuesta inmunitaria”.


Antonio Rodríguez-Bertos1,2 , Estefanía Cadenas-Fernández1,3, Agustín Rebollada-Merino1,2 , Néstor Porras-González1, Francisco J. Mayoral-Alegre 1, Lucía Barreno
1,2 , Aleksandra Kosowska1,3, Irene Tomé-Sánchez1, José A. Barasona1,3 y José M. Sánchez-Vizcaíno1,3

1Centro de Vigilancia Sanitaria Veterinaria (VISAVET), Universidad Complutense de Madrid
2Departamento de Medicina Interna y Cirugía Animal, Facultad de Veterinaria, Universidad Complutense de Madrid
3Departamento de Sanidad Animal, Facultad de Veterinaria, Universidad Complutense de Madrid
La Peste Porcina Africana (PPA) es una enfermedad vírica de los suidos domésticos y silvestres que actualmente amenaza a la industria porcina mundial1,2. Considerada una Enfermedad de Declaración Obligatoria (EDO) a la Organización Mundial de Sanidad Animal (OIE), ha avanzado notablemente en África, Europa y Asia en los últimos años3.

En la Unión Europea, el virus de la Peste Porcina Africana (VPPA) afecta principalmente a los jabalíes, que son responsables de más del 90% de los focos en diferentes países como Polonia, Hungría y Alemania3 El considerable aumento del tamaño y la amplia distribución geográfica de las poblaciones de jabalíes hace que sean muy relevantes para el mantenimiento de la enfermedad6,7 y un factor de riesgo importante para la infección en cerdos domésticos.
A pesar del papel central del jabalí en la epidemiología actual del VPPA , no hay estudios detallados sobre la patogenia y la evolución de la PPA en esta especie con las cepas del VPPA que circulan actualmente en Eurasia, a pesar de que se conocen muy bien las características de la infección en cerdos domésticos5,6.

Es necesario tener un conocimiento exhaustivo de la enfermedad en los jabalíes para garantizar un diagnóstico diferencial preciso y para poder distinguirla de otras enfermedades hemorrágicas que también pueden afectar a estos animales, como la Peste Porcina Clásica (PPC), el Síndrome Reproductivo y Respiratorio Porcino (PRRS), la Erisipela Porcina, la Salmonelosis Septicémica o el Síndrome de Dermatitis y Nefropatía Porcina (SDNP)4
Por esta razón, un diagnóstico preliminar de la PPA basado en las principales lesiones macroscópicas es clave para la detección precoz de la enfermedad en nuevas zonas y puede contribuir ampliamente a los esfuerzos de vigilancia y control de la enfermedad6.
Para comprender mejor la patogenia y la evolución clínica de la PPA en los jabalíes, se infectó experimentalmente a jabalíes con la cepa Armenia 2007 (Arm07) del virus de la PPA , caracterizada por ser muy virulenta en cerdos domésticos y jabalíes8,9
En este estudio experimental se utilizó la cepa Arm07 del genotipo II del virus de la Peste Porcina Africana, caracterizada por ser altamente virulenta y hemadsorbente. Se utilizaron 17 hembras de jabalí de 3-4 meses de edad y 10-15 kg de peso procedentes de una granja comercial de jabalíes:
No habían sido vacunadas frente a ninguna enfermedad infecciosa.
Eran negativas a la prueba ELISA para las enfermedades infecciosas de la vigilancia sanitaria española en jabalíes (RD 1082/2009) y también para otras enfermedades con importante prevalencia en España: Virus de Aujeszky, Mycobacterium bovis, virus de la Peste Porcina Clásica (VPPC), virus de la Peste Porcina Africana (VPPA), virus de la Enfermedad Vesicular Porcina, Mycoplasma hyopneumoniae, virus del Síndrome Reproductivo y Respiratorio Porcino (PRRS) y Circovirus Porcino tipo 2 (PCV2).
El estudio se diseñó para comparar dos vías de infección diferentes. Para ello, los 17 jabalíes se dividieron en dos grupos:
Grupo inoculado intramuscular: seis jabalíes fueron inoculados por vía intramuscular (IM) con 1 mL de inóculo a una dosis de 10 HAD50 de la cepa Arm07 del VPPA.
Grupo en contacto: los 11 jabalíes restantes permanecieron alojados en contacto directo con los animales inoculados por vía IM durante todo el estudio.
Con el fin de describir con la mayor precisión posible la evolución de la enfermedad, se realizó una evaluación clínica diaria de los animales. Para ello, se utilizó una cámara de vídeo las 24 horas del día para vigilar a los jabalíes y garantizar su bienestar animal, y los veterinarios especialistas realizaron visitas diarias para registrar los signos clínicos.
La evolución de la infección por el VPPA se evaluó en términos de una puntuación clínica cuantitativa (CS) siguiendo los parámetros clínicos específicos de la PPA en jabalíes10,11 Esta evaluación clínica incluye:
Comportamiento
Condición corporal
Alteraciones cutáneas
Secreción ocular/nasal
Inflamación articular
Síntomas respiratorios
Síntomas digestivos
Síntomas neurológicos
Temperatura rectal: la fiebre se definió como una temperatura rectal superior a 40,0 ˚C.
Estos experimentos se llevaron a cabo en estricto cumplimiento de la normativa nacional y europea, mediante un protocolo de ensayo in vivo aprobado por los Comités de Ética de la Universidad Complutense de Madrid y de la Comunidad de Madrid (PROEX 004/18 y 124/18). El protocolo incluye una descripción detallada de los esfuerzos para prevenir y evitar el sufrimiento innecesario de los animales, incluyendo los criterios de valoración humanitaria y las pautas eutanásicas. El punto final humanitario fue predefinido con un CS > 18, también se incluyeron animales con signos clínicos graves (puntuación 3) de fiebre, condición corporal, síntomas respiratorios y digestivos durante más de dos días consecutivos, siguiendo las directrices descritas por Cadenas-Fernández et al.19. Además, los animales que sufrían condiciones inaceptables, según el criterio del veterinario, sin alcanzar el punto final humanitario predefinido, también fueron eutanasiados.
Todos los procedimientos fueron diseñados y llevados a cabo por veterinarios con formación específica (categorías de experimentación animal B, C y D) de acuerdo con la Directiva CE 86/609/CEE para la manipulación de animales y experimentos.
Los hallazgos macroscópicos se registraron siguiendo las pautas estandarizadas de lesiones macroscópicas para la infección por el VPPA en cerdos domésticos descritas previamente por GalindoCardiel et al., (2013) 12, con ligeras modificaciones, incluyendo más tejidos evaluados y adaptados al jabalí (Tabla 1).

Se examinaron las alteraciones patológicas y su distribución en los diferentes tejidos y órganos:
Examen externo (condición corporal, ojos/conjuntiva y piel)
Contenido torácico, abdominal y pericárdico
Corazón
Pulmón
Estómago
Intestino delgado y grueso
Hígado y vesícula biliar
Riñón
Vejiga urinaria
Bazo
Nódulos linfáticos
(mandibulares, retrofaríngeos, traqueales, mediastínicos, gastrohepáticos, renales, mesentéricos, inguinales, esplénicos)
Tonsila
Médula ósea
Glándula suprarrenal
Cerebro
EXAMEN EXTERNO
Tejido/Hallazgo patológico
Condición corporal
Ojos/Conjuntiva
Piel
Efusión torácica
Hidropericardio
Músculo cardiaco
CAVIDAD TORÁCICA
Corazón
Edema valvular
Colapso
Congestión o hemorragia
Pulmón
Edema
Neumonía
Pleura
TABLA 1
Escala de puntuación de las lesiones patológicas macroscópicas durante el examen post mortem de jabalíes infectados con una cepa altamente virulenta del virus de la Peste Porcina Africana de genotipo II, Armenia 2007
Puntuación
1 (Ligera)
2 (Moderada)
3 (Intensa)
Ligeramente delgado Delgado Caquéctico
Ligera congestión Congestión, hinchazón de los párpados y secreción ocular serosanguinolenta
Zonas con eritema cutáneo (orejas, flancos, abdomen)
Hidrotórax moderado (con líquido serosanguinolento)
Eritema de la piel, hemorragias múltiples
Hidrotórax severo

Mucosa ocular congestionada con hemorragias, párpados inflamados e hipema
Eritema cutáneo, hemorragias multifocales a coalescentes Edema subcutáneo Ocasionalmente áreas necróticas
Hemotórax
Ligero Moderado con adhesiones fibrinosas Intenso con adhesiones fibrinosas
Petequias en el epicardio
Ligero engrosamiento del endocardio de las válvulas atrioventriculares
Leve ausencia de colapso sin impresión de las costillas
Congestión leve difusa/parcheada del parénquima.
Ausencia de hemorragias
Escasa o nula presencia de material espumoso en tráquea/bronquios (edema alveolar) y mínimo edema intersticial
Consolidación craneoventral (uni/bilateral) mínima o leve (bronconeumonía)
Adhesiones fibrinosas
Hemorragias multifocales en el músculo cardiaco y el endocardio valvular
Engrosamiento moderado del endocardio de las válvulas atrioventriculares
Moderada ausencia de colapso con leves o escasas impresiones de las costillas
Grado variable de congestión Petequias o equimosis multifocales a coalescentes distribuidas heterogéneamente
Presencia leve-moderada de material espumoso en la tráquea/bronquio y distensión moderada de las paredes interlobulares
Consolidación craneoventral (uni/ bilateral) moderada (bronconeumonía)
Adhesiones pleurales/pleuritis focal fibrinosa
Extensas hemorragias coalescentes en el músculo cardíaco y el endocardio valvular
Engrosamiento severo del endocardio de las válvulas atrioventriculares y semilunares
Notable presencia de material espumoso en la tráquea e intensa distensión de los septos interlobulares
Grado variable de congestión Hemorragias multifocales a coalescentes distribuidas heterogéneamente por el parénquima pulmonar
Presencia marcada de material espumoso en la tráquea/bronquio y distensión intensa de las paredes interlobulares
Marcada consolidación craneoventral (uni/bilateral) (bronconeumonía) con hepatización roja y gris de los lóbulos
Pleuritis fibrinosa difusa con o sin edema pleural (Continúa en la página siguiente)
Tejido/Hallazgo patológico
Ascitis (fluido amarillento-rojizo)
Estómago
CAVIDAD ABDOMINAL
SISTEMA DIGESTIVO
Intestino delgado* Intestino grueso* Hígado
Vesícula biliar
Páncreas
Riñones (hemorragias)
SISTEMA URINARIO
Patrón medulocortical Patrón corticomedular Vejiga urinaria
Bazo Ganglios linfáticos
SISTEMA LINFOIDE
Linfadenomegalia Congestión o hemorragias Ganglios linfáticos afectados
Tonsilas
Médula ósea
SISTEMA ENDOCRINO Glándulas adrenales
SISTEMA NERVIOSO CENTRAL Cerebro
*Enteritis catarral, clasificado según Maxie13
1 (Ligera)
Gastritis catarral aguda
Enteritis catarral aguda con algunas petequias en la superficie de la serosa
Colitis/tiflitis/proctitis catarral aguda con algunas petequias en la superficie de la serosa
Cambios multifocales ligeros de color del parénquima con ligera hepatomegalia
Puntuación
2 (Moderada)
Gastritis catarral aguda con numerosas petequias/equimosis superficiales
Enteritis catarral aguda con numerosas petequias/equimosis en la superficie de la serosa
Colitis/tiflitis/proctitis catarral aguda con numerosas petequias/ equimosis en la superficie de la serosa Hiperplasia del tejido linfoide asociado al intestino (GALT, Gut-associated lymphoid tissue)
Hepatomegalia moderada, congestión moderada y presencia de áreas rojas multifocales y hemorragias Patrón lobulillar difuso ligero
3 (Intensa)
Gastritis hemorrágica (más del 50% de afectación) con ocasionales erosiones
Enteritis hemorrágica con ocasionales lesiones erosivas multifocales
Colitis/tiflitis/proctitis hemorrágica con ocasionales lesiones necrotizantes multifocales asociados con hiperplasia del GALT
Hepatomegalia intensa, congestión intensa y presencia de zonas rojas coalescentes intraparenquimatosas. Patrón panlobulillar moderado
Edema leve-moderado que afecta a la pared de la vesícula biliar/ conducto cístico Bilis normal
Leves petequias corticales y medulares multifocales con angiectasia vascular multifocal
Escasas-leves petequias corticales y medulares
Edema que afecta a la pared de la vesícula biliar/conducto cístico con hemorragias en la superficie de la serosa/submucosa Bilis con aspecto rojizo
Edema severo que afecta a la pared de la vesícula biliar/conducto cístico con hemorragias severas El contenido de la bilis muestra un color rojizo con coágulos de sangre Hemorragias multifocales superficiales Necrosis focal Necrosis extensa
Hemorragias moderadas multifocales corticales (petequias) y medulares (banda roja oscura) con dilatación moderada de la pelvis renal
Hemorragias moderadas multifocales corticales y medulares (petequias) con predominio de la afectación cortical Edema perirrenal
Marcadas hemorragias corticomedulares difusas con rojo oscuro generalizado, notable dilatación de la pelvis renal y extensas hemorragias subcapsulares
Marcadas hemorragias multifocales corticomedulares más frecuentes en la capa cortical con/sin zonas multifocales de color rojo oscuro moderado en la pelvis renal. Edema perirrenal
Leves petequias multifocales en la superficie de la mucosa sin/con leves cambios de color en la pared de la vejiga urinaria
Esplenomegalia leve (sangrado mínimo o leve al seccionar)
Petequias y equimosis multifocales en la pared de la vejiga urinaria con edema. Orina turbia
Esplenomegalia modera (sangrado moderado o leve al seccionar)
Hemorragias multifocales a coalescentes en la superficie de la mucosa Intenso edema intramural. Orina teñida de sangre con coágulos
Esplenomegalia intensa (hemorragia marcada al seccionar)
Ligera Moderada Severa
Cambios de color moderados con petequias ocasionales
1-3 ganglios linfáticos
Hinchazón y eritema
Congestión
Petequias/hemorragias multifocales corticales y medulares
Congestión de las meninges
Edema
Petequias y equimosis
Aumento de tamaño, edema y hemorragia
4-6 ganglios linfáticos 6 o más ganglios linfáticos
Hinchazón y eritema con fibrina en la superficie
Congestión con petequias y equimosis
Congestión medular Petequias y equimosis en la corteza
Congestión con ocasionales petequias
Hinchazón y eritema con fibrina y necrosis multifocal en la superficie
Congestión con hemorragias multifocales coalescentes
Hemorragias multifocalescoalescentes, predominantemente, en la corteza
Severos cambios vasculares con petequias y equimosis
Durante el examen post mortem, se tomaron muestras de sangre y de 18 tejidos sensibles, ocho de los cuales eran ganglios linfáticos (renal, mediastínico, retrofaríngeo, mesentérico, preescapular, gastrohepático, inguinal y mandibular), así como corazón, hígado, cerebro, bazo, tonsilas, pulmón, vejiga urinaria, riñón, médula ósea e intestino.
Estas muestras de tejido fueron analizadas mediante PCR en tiempo real (qPCR) para la detección del genoma viral según el protocolo descrito por King et al.14
Una dosis de 10 HAD50 de la cepa Arm07 fue suficiente para inducir el desarrollo de un cuadro clínico compatible con la PPA con un resultado letal en los seis animales inoculados por vía intramuscular (IM), así como para los once jabalíes puestos en contacto con los sujetos inoculados, manifestando una evolución clínica similar y el mismo grado de letalidad.
Los primeros síntomas observados fueron inespecíficos, como fiebre, disminución de actividad y ligera pérdida de condición corporal
JABALÍES INOCULADOS CON EL VPPA VÍA IM
Los seis jabalíes inoculados vía IM empezaron a mostrar los primeros signos clínicos a los 3-6 dpi, con un aumento de la temperatura corporal (40,5 ± 0,5°C; 4/6 animales; reducción de (4-10 dpi). Estos síntomas fueron seguidos eritema localizado o generalizado (6/6; 4-7 dpi), y ligera dificultad para caminar (6/6; 4-5 dpi).
Los once jabalíes puestos en contacto con los sujetos inoculados empezaron a mostrar los primeros signos clínicos entre los 9 y los 11 dpi, ligeramente más tarde en comparación con los animales inoculados por vía IM (prueba U de Mann-Whitney, p < 0,01), como era de esperar, debido al periodo de incubación. La presentación clínica en los 11 animales en contacto también comenzó con síntomas inespecíficos, caracterizados por un aumento de la temperatura corporal (40,8 ± 0,7 C; 10-14 dpi) y una reducción de la vitalidad (10-12 dpi).
Se observaron otros signos clínicos, como eritema generalizado (5/11; 10-12 dpi), dificultad para caminar (7/11; 12-13 dpi), ligera secreción ocular (9/11; 10-12 dpi) y síntomas digestivos, como heces con gran cantidad de moco y vómitos esporádicos (4/11; 10-14 dpi).

IMAGEN 1
Hallazgos patológicos macroscópicos de la conjuntiva y párpados de jabalíes infectados con una cepa altamente virulenta del virus de la peste porcina africana de genotipo II, Armenia 2007.

Puntuación 1 - congestión leve
Puntuación 2 - hinchazón de los párpados y serosanguinidad ocular
Puntuación 3 - congestión de la mucosa ocular con hemorragias de la esclerótica, párpados inflamados e hipema.
En todos los animales de ambos grupos de estudio, la necropsia reveló hallazgos macroscópicos consistentes con una infección aguda por el VPPA
El examen externo reveló un grado variable de congestión de la mucosa ocular con hemorragias, párpados hinchados (edema) y congestivos (Imagen 1)

Los animales presentaban una acumulación moderada-grave de líquido amarillento-rojizo en la cavidad abdominal (ascitis), el tórax (hidrotórax) (Imagen 3) y el pericardio (hidropericardio).


PUNTUACIÓN 1
Las lesiones cutáneas se caracterizaban por marcadas áreas eritematosas, más visibles en las zonas desprovistas de pelo, como la pared abdominal y las regiones inguinales o axilares (Imagen 2). Algunos jabalíes mostraban hemorragias multifocales o coalescentes en la piel y, ocasionalmente, zonas necróticas.


IMAGEN 2
A nivel macroscópico, los pulmones (principalmente los lóbulos caudales) se mostraban prominentes debido a la ausencia de colapso del parénquima pulmonar (Imagen 3).
PUNTUACIÓN 2
Hallazgos patológicos macroscópicos de la superficie cutánea de jabalíes infectados con una cepa altamente virulenta del virus de la peste porcina africana de genotipo II, Armenia 2007.
Puntuación 1 - áreas con eritema cutáneo (orejas, flancos, abdomen)
Puntuación 2 - eritema cutáneo y múltiples hemorragias
PUNTUACIÓN 3
Puntuación 3 - eritema cutáneo, hemorragias multifocales o coalescentes, edema subcutáneo y, ocasionalmente, áreas necróticas.
PUNTUACIÓN 1
PUNTUACIÓN 2
PUNTUACIÓN 3
Hallazgos patológicos macroscópicos de la cavidad torácica y pulmones de jabalíes infectados con una cepa altamente virulenta del virus de la peste porcina africana de genotipo II, Armenia 2007.

Puntuación 1 - Ausencia de colapso del parénquima pulmonar asociado a la dilatación de los septos interlobulares, debido al edema intersticial y a la presencia de algunas petequias (neumonía intersticial con edema pulmonar grave)
Puntuación 2 - áreas de consolidación lobular parcheada, caracterizadas por áreas ligeramente deprimidas con una distribución heterogénea (neumonía broncointersticial)
Puntuación 3 - consolidación lobular generalizada con un aspecto firme y rojo oscuro, debido a una intensa congestión y hemorragias (bronconeumonía lobular).
Otros hallazgos fueron la efusión torácica, edema septal y ausencia de colapso pulmonar.


La mayoría de los jabalíes (11/17) presentaban una dilatación de los tabiques interlobulares debido a un edema intersticial, así como la presencia de algunas petequias y pequeños focos de congestión lobular (Puntuación 1).
Las superficies pulmonares mostraban un aspecto “moteado” con múltiples petequias y equimosis, muchas de las cuales se habían unido para causar una extensa hemorragia.
Estos animales (4/17) mostraban múltiples áreas lobulares consolidadas caracterizadas por zonas ligeramente deprimidas con una distribución no homogénea compatible con una neumonía broncointersticial (Puntuación 2) asociada a adherencias pleurales o pleuritis fibrinosa. Puntualmente, se observó consolidación lobular generalizada en dos animales con aproximadamente el 90% del parénquima pulmonar afectado, mostrando un aspecto firme y rojo oscuro (Puntuación 3) debido a una intensa congestión y hemorragia.
La válvula mitral estaba ligeramente engrosada, edematosa y tenía un aspecto blanquecino en todos los animales de ambos grupos del estudio (válvula edematosa) (Imagen 4) y se observaron petequias y equimosis multifocales en el epicardio y miocardio, así como en el endocardio valvular y parietal.
Hallazgos patológicos macroscópicos del corazón de jabalíes infectados con una cepa altamente virulenta del virus de la peste porcina africana de genotipo II, Armenia 2007. Corazón:



Puntuación 1- hemorragias petequiales en el endocardio
Puntuación 2 - hemorragias multifocales en el músculo cardíaco y el endocardio valvular
Puntuación 3 - hemorragias coalescentes extensas en el músculo cardíaco y endocardio valvular. Observación de un grado variable de edema valvular en la válvula atrioventricular.
PUNTUACIÓN 1 PUNTUACIÓN 2 PUNTUACIÓN 3 PUNTUACIÓN 1 PUNTUACIÓN 2Hallazgos patológicos macroscópicos de la mucosa tonsilar de jabalíes infectados con una cepa altamente virulenta del virus de la peste porcina africana de genotipo II, Armenia 2007.




Puntuación 1- eritema
Puntuación 2 - hipertrofia y eritema con depósito de fibrina en la superficie
Puntuación 3 - hipertrofia y eritema con deposición de fibrina/pus y necrosis multifocal en la superficie.
Varios tejidos linfoides, como las tonsilas, el bazo y los ganglios linfáticos, mostraban cambios intensos en la mayoría de los animales.
La mucosa tonsilar (Imagen 5) mostraba una decoloración rojiza difusa debida a una congestión de leve a moderada.
En uno de los jabalíes, la mucosa tonsilar presentaba necrosis ulcerosa bilateral y depósito de material purulento amarillento (tonsilitis necrotizante y supurativa bilateral).


PUNTUACIÓN 1
El bazo tenía un color rojo oscuro y rezumaba abundante sangre de la superficie del corte (congestión), encontrándose notablemente aumentado de tamaño, con un rango de peso relativo de 0,11-0,20 peso corporal (valor normal de esplenomegalia 0,13 ± 0,1 peso corporal15).
PUNTUACIÓN 2
Se observó linfadenomegalia en todos los animales. La mayoría de los linfonódulos (mandibulares, retrofaríngeos, traqueales, mediastínicos, gastrohepáticos, renales, mesentéricos, inguinales, esplénicos) mostraban un mayor tamaño y eran de color rojo oscuro intenso y brillante, compatible con una linfadenopatía hemorrágica
PUNTUACIÓN 3
(Imagen 6)
Hallazgos patológicos macroscópicos de los linfonódulos de jabalíes infectados con una cepa altamente virulenta del virus de la peste porcina africana de genotipo II, Armenia 2007.
Puntuación 1 - cambio de color moderado con petequias ocasionales
Puntuación 2 - petequias y equimosis
Puntuación 3 - aumento de tamaño, edematoso y hemorrágico. Linfadenomegalia generalizada.
PUNTUACIÓN 1 PUNTUACIÓN 2Se observó un engrosamiento moderado de la mucosa del tracto digestivo. Estas zonas engrosadas mostraban pliegues edematosos prominentes, abundante moco amarillento y múltiples focos puntiformes de pequeño tamaño (petequias) a lo largo de la capa mucosa.



La mucosa gástrica evidenciaba erosiones multifocales (lesiones superficiales), con tejido normal alternando con pequeñas y profundas úlceras subagudas (Imagen 7).
IMAGEN 7
Hallazgos patológicos macroscópicos gástricos en jabalíes infectados con una cepa altamente virulenta del virus de la peste porcina africana de genotipo II, Armenia 2007.
Puntuación 1- gastritis catarral aguda
Puntuación 2 - gastritis catarral aguda con numerosas petequias/ equimosis en la superficie
Puntuación 3 - gastritis hemorrágica (más del 50% de afectación) con ocasionales lesiones erosivas.

El íleon, el colon y el recto mostraban numerosas hemorragias (Imagen 8) asociadas a la hiperplasia del tejido linfoide asociado al intestino (GALT, por sus siglas en inglés, Gut-associated lymphoid tissue).



IMAGEN 8
Hallazgos patológicos macroscópicos intestinales en jabalíes infectados con una cepa altamente virulenta del virus de la peste porcina africana de genotipo II, Armenia 2007.
Puntuación 1- enteritis catarral aguda con algunas petequias en la superficie de la serosa
Puntuación 2 - enteritis catarral aguda con numerosas petequias/ equimosis en la superficie de la serosa
Puntuación 3 - enteritis hemorrágica.
PUNTUACIÓN 1 PUNTUACIÓN 2 PUNTUACIÓN 3 PUNTUACIÓN 1 PUNTUACIÓN 2IMAGEN 9
Hallazgos patológicos macroscópicos pancreáticos en jabalíes infectados con una cepa altamente virulenta del virus de la peste porcina africana de genotipo II, Armenia 2007.
Puntuación 1- hemorragias multifocales en la superficie
Puntuación 2 - necrosis focal
Puntuación 3 - necrosis extensa.
Nueve de los 17 animales presentaban áreas necróticas en los bordes del páncreas (Imagen 9, flecha) y siete tenían petequias multifocales en la superficie.
HÍGADO
El hígado se encontraba aumentado de tamaño en todos los animales (hepatomegalia) (Imagen 10). Además, el parénquima hepático presentaba un color rojizo (congestión) con focos pálidos dispersos, lo que sugiere una necrosis hepática multifocal





IMAGEN 10
PUNTUACIÓN 1
Hallazgos patológicos macroscópicos hepáticos en jabalíes infectados con una cepa altamente virulenta del virus de la peste porcina africana de genotipo II, Armenia 2007.

Puntuación 1 - cambios parenquimatosos multifocales leves con ligera hepatomegalia
PUNTUACIÓN 2
Puntuación 2 - hepatomegalia moderada, congestión moderada y hemorragias, y patrón lobulillar difuso leve
Puntuación 3 - hepatomegalia intensa, congestión intensa y zonas rojas coalescentes parenquimatosas y patrón panlobulillar moderado.
PUNTUACIÓN 3
PUNTUACIÓN 3
Hallazgos patológicos macroscópicos renales en jabalíes infectados con una cepa altamente virulenta del virus de la peste porcina africana de genotipo II, Armenia 2007.
Puntuación 1- petequias corticomedulares de leves a mínimas
Puntuación 2 - petequias corticomedulares multifocales moderadas con predominio de afectación cortical
Puntuación 3 - hemorragias corticomedulares multifocales más frecuentes en la región cortical con/sin áreas de color rojo oscuro en la pelvis renal. Edema perirrenal.
Los riñones presentaban una congestión moderada tras la incisión, observándose petequias multifocales de hasta 1-2 mm en la corteza renal, así como en el parénquima cortical y medular (Imagen 11)
Por su parte, la pelvis renal mostraba un edema severo, que en algunos animales estaba asociado a hemorragia y grasa perirrenal edematosa (10/17).
La mucosa de la vejiga urinaria presentaba diferentes patrones de distribución de las hemorragias. La mayoría de los animales (11/17) presentaban petequias en la mucosa vesical de grado variable (Imagen 12)
PUNTUACIÓN 1
Seis animales presentaban también un engrosamiento con pliegues irregulares y prominentes en la mucosa vesical debido a hemorragias intramurales. En estos casos intensos, la orina contenía numerosos coágulos de sangre.






PUNTUACIÓN 2
IMAGEN 12
Hallazgos patológicos macroscópicos en la vejiga urinaria de jabalíes infectados con una cepa altamente virulenta del virus de la peste porcina africana de genotipo II, Armenia 2007.
Puntuación 1- petequias multifocales leves en la superficie de la mucosa con/sin cambios leves de color en la pared de la vejiga urinaria
PUNTUACIÓN 3
Puntuación 2 - petequias multifocales y equimosis en la pared de la vejiga urinaria con edema, así como orina turbia
Puntuación 3 - hemorragias multifocales a coalescentes en la superficie de la mucosa e Intenso edema intramural.
PUNTUACIÓN 1 PUNTUACIÓN 2PUNTUACIÓN 1
Los vasos sanguíneos submeníngeos del cerebro estaban notablemente congestionados (congestión vascular grave) y provocaban numerosas hemorragias superficiales y parenquimatosas (Imagen 13)
IMAGEN 13
Hallazgos patológicos macroscópicos en el cerebro de jabalíes infectados con una cepa altamente virulenta del virus de la peste porcina africana de genotipo II, Armenia 2007.
PUNTUACIÓN 2
PUNTUACIÓN 3
Puntuación 1 - congestión de las meninges y/o edema
Puntuación 2 - congestión vascular con petequias ocasionales
Puntuación 3 - cambios vasculares graves caracterizados por una intensa congestión vascular con hemorragias focales de las meninges (petequias y equimosis).
Frecuencia de presentación de lesiones macroscópicas asociadas a la cepa altamente virulenta del VPPA del genotipo II en jabalíes
Frecuencia alta Frecuencia media-baja
Linfadenomegalia generalizada (94,1%)
Esplenomegalia (76,5%)
Gastritis catarral aguda
Edema en la pared de la vesícula biliar
Petequias multifocales leves en la superficie de la vejiga urinaria
Lesiones cardiacas (hidropericardio, edema valvular y hemorragias)
Grados variables de pleuritis fibrinosa
Congestión vascular con hemorragias focales de las meninges



Lesiones necrohemorrágicas multifocales en la superficie del páncreas
En este estudio se llevó a cabo una infección experimental con una dosis baja de un aislado altamente virulento del VPPA, Arm07, en jabalíes. Se estudiaron dos vías de infección diferentes, la inoculación IM y el contagio por contacto para poder evaluar la progresión clínica de la enfermedad y detallar los principales hallazgos patológicos macroscópicos en los jabalíes.
Se observó linfadenomegalia y esplenomegalia la mayoría de jabalíes. Estos hallazgos son coherentes con los principales hallazgos macroscópicos encontrados en cerdos domésticos4,5
Los linfonódulos hipertróficos y hemorrágicos parecen ser una característica de la PPA, tanto en cerdos domésticos como en jabalíes16,17. Esta condición puede ser útil para caracterizar la PPA en jabalíes en libertad, junto con hallazgos patológicos macroscópicos menos frecuentes, pero más específicos, como hemorragias extensas en la mucosa vesical y focos necróticos en el páncreas, ya que estos últimos hallazgos no se habían caracterizado antes en cerdos domésticos6,17
De acuerdo con la descripción de la evolución clínica en cerdos5, se observó que el mayor porcentaje de mortalidad en jabalíes ocurría durante la fase subaguda de la enfermedad (15 días posteriores a la infección con el genotipo II altamente virulento del VPPA). Sin embargo, las lesiones macroscópicas corresponden al curso agudo de la infección en cerdos domésticos, según Sánchez-Vizcaíno et al. 5
Muchos animales mostraron lesiones más características de la forma aguda de la infección descrita en cerdos domésticos, como eritema cutáneo, esplenomegalia severa, linfadenopatía hemorrágica; y petequias en los riñones, y corazón (endocardio)5 Además, se apreciaron cambios vasculares (hemorragias, edema y congestión) característicos de la fase subaguda en cerdos domésticos:
1 2 3
Agrandamiento severo del bazo debido a la congestión
Efusión en las cavidades corporales (hidropericardio y ascitis de leves a moderados, e hidrotórax moderado a severo)
Múltiples hemorragias (incluyendo petequias y equimosis) en el pulmón, corazón (endocardio), cerebro, riñones y vejiga urinaria5
Este estudio proporciona información más detallada sobre la infección por el VPPA en jabalíes con cepas virulentas que están circulando en la actualidad. Como concluye una reciente revisión, existen extensos estudios sobre los aislados del genotipo I del VPPA procedentes de la anterior propagación de este virus en los años 1950-196018 .
Sin embargo, sigue habiendo carencias en cuanto a la patología asociada a cepas del genotipo II del VPPA procedentes de los escenarios epidémicos actuales, y mucho menos en jabalíes18 , a pesar de su importante papel en la epidemiología de la enfermedad.
Artículo traducido y adaptado de: Rodríguez-Bertos, A., Cadenas-Fernández, E., Rebollada-Merino,
1. Arias, M.; Jurado, C.; Gallardo, C.; Fernández-Pinero, J.; Sánchez-Vizcaíno, J.M. Gaps in African swine fever: Analysis and priorities. Transbound. Emerg. Dis. 2018, 65, 235–247
2. Sánchez-Cordón, P.J.; Montoya, M.; Reis, A.L.; Dixon, L.K. African swine fever: A re-emerging viral disease threatening the global pig industry. Vet. J. 2018, 233, 41–48.
3. OIEWAHIS.World Animal Health Information System. Available online: http://www.oie.int/ wahis_2/public/ wahid.php/Diseaseinformation/reportarchive (accessed on 15 July 2020).
4. Zimmerman, J.F.; Karriker, L.A.; Ramírez, A.; Schwartz, K.J.; Stevenson, G.W. Diseases of Swine, 10th ed.; Wiley-Blackwell: Hoboken, NJ, USA, 2012; pp. 396–404.
5. Sánchez-Vizcaíno, J.M.; Mur, L.; Gomez-Villamandos, J.C.; Carrasco, L. An update on the epidemiology and pathology of African swine fever. J. Comp. Pathol. 2015, 152, 9–21.
6. Pikalo, J.; Schoder, M.-E.; Sehl, J.; Breithaupt, A.; Tignon, M.; Cay, A.B.; Gager, A.M.; Fisher, M.; Beer, M.; Blome, S. The African swine fever virus isolate Belgium 2018/1 shows high virulence in European wild boar. Transbound. Emerg. Dis. 2020, 67, 1654–1659.
7. Massei, G.; Kindberg, J.; Licoppe, A.; Gaˇci´c, D.; Šprem, N.; Kamler, J.; Baubet, E.; Hohmann, U.; Monaco, A.; Ozolin, š, J.; et al. Wild boar populations up, numbers of hunters down? A review of trends and implications for Europe. Pest Manag. Sci. 2015, 71, 492–500.
En general, el conocimiento detallado de las lesiones asociados a la cepa altamente virulenta del virus de la Peste Porcina Africana (Arm07) en jabalíes pueden contribuir a la detección temprana de la infección en este hospedador en el campo.
Este estudio confirma que el bazo y el hígado son los tejidos de elección a la hora de tomar muestras para la vigilancia pasiva y activa en poblaciones de jabalíes y para el diagnóstico de laboratorio basado en la detección del genoma viral.
La médula ósea podría ser un buen tejido para la toma de muestras, ya que también ha mostrado buenos resultados con bajos umbrales de detección (CT) por PCR, y tiene un valor adicional por su gran interés en el campo, ya que este tejido podría ser un lugar donde el genoma viral se conserve mejor.
DIRECTRICES AMPLIAS, DETALLADAS Y ESPECÍFICAS PARA LA EVALUACIÓN DE LOS HALLAZGOS MACROSCÓPICOS DE LA INFECCIÓN POR VPPA EN JABALÍES
8. Barasona, J.A.; Gallardo, C.; Cadenas-Fernández, E.; Jurado, C.; Rivera, B.; Rodríguez-Bertos, A.; Arias, M.; Sánchez-Vizcaíno, J.M. First oral vaccination of Eurasian wild boar against African swine fever virus genotype II. Front. Vet. Sci. 2019, 6, 137.
9. Gallardo, C.; Sánchez, E.G.; Pérez-Núñez, D.; Nogal, M.; de León, P.; Carrascosa, A.L.; Nieto, R.; Soler, A.; Arias, M.L.; Revilla, Y. African swine fever virus (ASFV) protection mediated by NH/P68 and NH/P68 recombinant live-attenuated viruses. Vaccine 2018, 36, 2694–2704.
10. Barasona, J.; López-Olvera, J.; Beltrán-Beck, B.; Gortázar, C.; Vicente, J. Trap-effectiveness and response to tiletamine-zolazepam and medetomidine anaesthesia in Eurasian wild boar captured with cage and corral traps. BMC Vet. Res. 2013, 9, 107.
11. Salguero, F.J. Comparative pathology and pathogenesis of African Swine Fever infection in swine. Front. Vet. Sci. 2020, 7, 1–7.
12. Galindo-Cardiel, I.; Ballester, M.; Solanes, D.; Nofrarías, M.; López-Soria, S.; Argilaguet, J.M.; Lacasta, A.; Accensi, F.; Rodríguez, F.; Segalés, J. Standardization of pathological investigations in the framework of experimental ASFV infections. Virus Res. 2013, 173, 180–190.
13. Maxie, G. Jubb, Kennedy & Palmer’s Pathology of Domestic Animals, 6th ed.; Wiley-Blackwell: Hoboken, NJ, USA, 2015.
14. King, D.P.; Reid, S.M.; Hutchings, G.H.; Grierson,
S.S.; Wilkinson, P.J.; Dixon, L.K.; Bastos, A.D.; Drew, T.W. Development of a TaqMan®PCR assay with internal amplification control for the detection of African swine fever virus. J. Virol. Methods 2003, 107, 53–61
15. Razmaite, V.; Kerziene, S.; Jatkauskiene, V. Body and carcass measurements and organ weights of Lithuaninan indigenous pigs and their wild boar hybrids. Anim. Sci. Pap. Rep. 2009, 27, 331–342.
16. Pietschmann, J.; Guinat, C.; Beer, M.; Pronin, V.; Tauscher, K.; Petrov, A.; Keil, G.; Blome, S. Course and transmission characteristics of oral low-dose infection of domestic pigs and European wild boar with a Caucasian African swine fever virus isolate. Arch. Virol. 2015, 160, 1657–1667.
17. Fernández-Llario, P.; Parra, A.; Cerrato, R.; Hermosa de Mendoza, J. Spleen size variations and reproduction in a Mediterranean population of wild boar (Sus scrofa). Eur. J. Wild Res. 2004, 50, 13–17.
18. Sánchez-Cordón, P.J.;Nunez,A.;Neimanis,A.;Wikström-Lassa, E.;Montoya,M.; Crooke,H.; GavierWidén,D. African swine fever: Disease dynamics in wild boar experimentally infected with ASFV isolates belonging to genotype I and II. Viruses 2019, 11, 852.
19. Cadenas-Fernández, E.; Sánchez-Vizcaíno, J.M.; Kosowska, A.; Rivera, B.; MayoralAlegre, F.; Rodríguez-Bertos, A.; Yao, J.; Bray, J.; Lokhandwala, S.; Mwangi, W.; et al. Adenovirus-vectored African swine fever virus antigens cocktail is not protective against virulent Arm07 isolate in Eurasian wild boar. Pathogens 2020, 9, 171.
A., Porras-González, N., Mayoral-Alegre, F., & Barreno, L. et al. (2020). Clinical Course and Gross Pathological Findings in Wild Boar Infected with a Highly Virulent Strain of African Swine Fever Virus Genotype II. Pathogens, 9(9), 688. doi: 10.3390/pathogens9090688 (CC BY 4.0) Dra. Mª Jesús
Dra. Mª Jesús




 Andrés, Unizar-IA2
Andrés, Unizar-IA2
Descarga el PDF
El gran desarrollo experimentado por la ganadería en los últimos años ha facilitado el acceso a productos de calidad a un elevado porcentaje de la población. Esta mejora en la productividad ha ido asociada al uso de productos antibióticos, tan necesarios a niveles de producción como perjudiciales si se hace un mal uso de ellos.
La exposición de los microorganismos a estos compuestos es la base de la generación de antibiorresistencias, proceso mediante el cual las bacterias dejan de ser sensibles a los antibióticos, que ya no serán eficaces para el tratamiento de enfermedades comunes. Tan grave es esta problemática que la OMS (Organización Mundial de la Salud) considera la resistencia antimicrobiana como una de las mayores amenazas que la humanidad debe afrontar en las próximas décadas (OMS, 2017). El mayor consumo de antibióticos, así como de otros antimicrobianos, se da en el ámbito de la Sanidad Animal (EMA, 2017). Por tanto, existe una gran preocupación por el hecho de que los alimentos de origen animal puedan representar una posible vía de entrada de estos compuestos en la cadena alimentaria, y de este modo, de generación de antibiorresistencias en los consumidores.

En este ámbito, las autoridades sanitarias cuentan con una legislación amplia y protectora que, junto al uso responsable y los programas de control, han logrado reducir la aparición de alimentos contaminados con residuos de antibióticos hasta porcentajes tan bajos como el 0,3% en 2018 (EFSA, 2020).
Precisamente es el Reglamento 2377/90 el que fija los Límites Máximos de Residuos (LMRs) de estos compuestos permitidos en alimentos de origen animal, punto clave en el establecimiento de los periodos de supresión requeridos para todo medicamento veterinario (Directiva 2001/82/CE).
Los LMRs son también punto de referencia para la implementación de los métodos de vigilancia y control (Decisión de la Comisión 2002/657/ CE) y, por ende, en los planes nacionales de vigilancia (Directiva 96/23/CE).
Así, los datos oficiales dan seguridad al consumidor y reflejan, no solo el buen hacer de los productores sino la efectividad de los planes de vigilancia.
En España, el PNIR (Plan Nacional de Investigación de Residuos) engloba los métodos oficiales de control. Estos métodos incluyen, por norma general, varios pasos secuenciales en sus exploraciones.
En un primer momento, se lleva a cabo un método de cribado que permite el análisis rápido de un elevado número de compuestos Este método es cualitativo y necesita de un segundo paso en el que se lleva a cabo la determinación y cuantificación del compuesto
Tradicionalmente, los métodos de cribado han tenido base biológica. De hecho, fueron los primeros métodos en desarrollarse (Mitchell et al., 1998) y se basan en la inhibición del crecimiento de un microorganismo sensible a la presencia de antimicrobianos En la actualidad siguen siendo ampliamente empleados ya que son baratos y de amplio espectro (Pikkemaat, 2009).
Cuando el microorganismo muestra cierto nivel de inhibición del crecimiento por exposición a la muestra estudiada, ésta se considera positiva y es necesario llevar a cabo su confirmación mediante un método que permita identificar el compuesto inhibitorio y determinar su concentración.
Normalmente, estos métodos confirmatorios se basan en las propiedades físico-químicas de los antibióticos (HPLC, LC-MS/MS) (Gaudin, 2017 ).
LEER REGLAMENTO 2377/90




LEER DIRECTIVA 2001/82/CE
LEER DECISIÓN DE LA COMISIÓN 2002/657/CE
LEER DIRECTIVA 96/23/CE
Aunque los planes de vigilancia cumplen con los requisitos propuestos en la Directiva 96/23/CE y han probado cumplir sus objetivos, presentan un inconveniente derivado de los métodos de control: son baratos y fáciles de manejar, pero todos ellos se llevan a cabo tras el sacrificio del animal.
A pesar de preservar la salud del consumidor, los métodos actuales no evitan los problemas ligados a la aparición de una canal positiva que ha de ser decomisada:
• La repercusión económica es importante para los productores, que se enfrentan a la pérdida del capital invertido en criar el animal, desvanecido por su venta frustrada, sin olvidar las consecuencias legales que podría tener el incumplimiento de la normativa vigente.
• El nocivo impacto medioambiental ligado a la cría de animales que terminan como un desecho, no sólo por los recursos consumidos (agua, energía, etc.) sino por las emisiones al medio (aguas residuales, purines, emisiones de gases, etc.) y la complicada gestión de canales contaminadas (Djekic et al., 2015 ).
Es importante señalar que estos inconvenientes no son las implicaciones más graves de la existencia de canales contaminadas, ya que un fallo en su detección derivaría en la incorporación de residuos antibióticos en la cadena alimentaria, con el consiguiente impacto directo e indirecto en la salud humana (alergias, antibiorresistencias, etc.).
Con el objetivo de dar solución a los efectos colaterales de los antibióticos sobre el medio ambiente, la economía de los ganaderos y la Salud Pública, surgió el proyecto TESTACOS.
Este proyecto une el esfuerzo de universidades públicas, centros de investigación y empresas privadas del área transfronteriza España - Francia - Andorra (POCTEFA) en su afán por ofrecer herramientas innovadoras y ponerlas al servicio de todos los agentes de la cadena alimentaria. En concreto, el proyecto está liderado por la Universidad de Zaragoza - Instituto Agroalimentario de Aragón (IA2) y cuenta con la colaboración de la Universidad de La Rioja, el Laboratorio de Salud Pública del Gobierno Vasco, la Fundación Vasca de Innovación e Investigación Sanitaria y Zeulab S.L. como socios españoles, y la Universidad de Perpignan Vía Domitia y el INRA (Institut National de la Recherche Agronomique) como socios franceses.

Sin embargo, a pesar de que existen estudios sobre la concentración de antibióticos en músculo (Reyes-Herrera et al., 2005 ) y plasma sanguíneo (Hernández et al., 2005; Ziółkowski et al., 2016 ), sorprendentemente, existe poca información sobre la relación entre los niveles de antibióticos de estas dos matrices. Además, no se puede obviar la dependencia de esta relación y la farmacocinética característica de cada familia de antibióticos.
Estas entidades, de acreditada experiencia en diversos aspectos relacionados con esta problemática, propusieron una la adaptación de los métodos de cribado actuales para la detección de Este nuevo enfoque requiere para fácil obtención a nivel de producción y que presente una buena correlación con la concentración presente en músculo.
Son muchas las matrices que pueden obtenerse de un animal vivo mediante un método mínimamente invasivo, pero al igual que en muchas otras pruebas, de resultar adecuado, la sangre sería el fluido idóneo.
Así pues, el presente estudio se planteó para explorar esta correspondencia a través de la creación de un banco de muestras naturalmente contaminadas por antimicrobianos de distintas familias (quinolonas, sulfonamidas, β-lactámicos y tetraciclinas) con objeto de obtener muestras pareadas de sangre y músculo con distintas concentraciones de antimicrobianos (correspondientes a diferentes días del periodo de supresión) y averiguar si la sangre es un buen indicador de la presencia de residuos antibióticos en músculo y, por ende, una matriz adecuada para el desarrollo de métodos de detección aptos para análisis ante mortem
Los antimicrobianos seleccionados para cada tratamiento fueron oxitetraciclina (una tetraciclina), sulfametoxipiridazina (una sulfonamida), enrofloxacina (una quinolona) y amoxicilina (una penicilina), ya que están entre los antimicrobianos de mayor importancia en medicina humana y se metabolizan siguiendo rutas diferentes (Riviere, 2009). La Tabla 1 recoge la información principal de cada antimicrobiano.
La caracterización de las muestras de músculo y sangre se llevó a cabo en el Laboratorio de Salud Pública del Gobierno Vasco por HPLC-FLD y LC-MS/MS.
Para obtener muestras biológicas contaminadas de forma natural por los antibióticos de elección, se adquirieron 120 cerdos. La Tabla 1 resume las principales características de los tratamientos antimicrobianos. Tras la administración intramuscular de los antibióticos, los animales fueron sacrificados a intervalos de tiempo preseleccionados durante el periodo de supresión (PS) y se conservaron músculo (lomos, cuartos delanteros y traseros) y suero sanguíneo en congelación (-20°C).
Los animales fueron sacrificados de acuerdo al Reglamento (CE) Nº. 1099/2009 relativo a la protección de los animales en el momento de la matanza. La Comisión Ética Asesora para la Experimentación Animal de la Universidad de Zaragoza aprobó el protocolo experimental (PI58/17).
LEER REGLAMENTO (CE) N º. 1099/2009

TABLA 1
Principales características de los antimicrobianos empleados
En primer lugar, tras la obtención de las muestras, se comprobó que la distribución del antibiótico fuese homogénea entre los distintos grupos musculares (lomos, cuartos delanteros y traseros).
Las diferencias fueron pequeñas y las mayores concentraciones se describieron en los lomos, por lo que se decidió analizar por HPLC o LC-MS/MS únicamente el lomo y el suero sanguíneo, obteniendo la evolución de su concentración a lo largo del periodo de supresión (Figura 1).
Evolución de la concentración de oxitetraciclina (a), sulfametoxipiridazina (b), enrofloxacina (c) y amoxicilina (d) en músculo ( ) y sangre (▲). La línea discontinua marca el LMR y el LD (Límite de Detección) del análisis.
SE COMPARÓ LA CONCENTRACIÓN DE LOS ANTIBIÓTICOS EN EL LOMO Y EL SUERO SANGUÍNEO A LO LARGO DEL PERIODO DE SUPRESIÓN
Para todos los compuestos, las muestras correspondientes a los primeros días del periodo de supresión contenían concentraciones elevadas de antimicrobiano que disminuían por debajo del LMR antes de su finalización.
La Tabla 2 muestra la diversidad de las muestras que componen el banco de muestras, formado por más de 11.000 (1.500 de ellas de animales no tratados), de las cuales más del 50% están contaminadas por encima del LMR
TABLA 2
Concentraciones máximas y mínimas de las muestras de músculo y sangre que componen el banco de muestras naturalmente contaminadas por los cuatro compuestos estudiados.
A partir de las concentraciones descritas en músculo a lo largo del periodo de supresión, se calcularon los tiempos de vida media para cada antibiótico y matriz , que se recogen en la Tabla 3
TABLA 3
Tiempos de vida media (días) hallados para los antibióticos y matrices objeto de estudio, calculados a partir de las concentraciones detectadas a lo largo del periodo de supresión.
abValores con diferentes letras (a y b) en la misma fila presentan diferencias estadísticamente significativas (P<0,05).
INVESTIGACIÓN
EVOLUCIÓN DE LA CONCENTRACIÓN DE LOS ANTIMICROBIANOS
EVOLUCIÓN DE LA CONCENTRACIÓN DE LOS ANTIMICROBIANOS
La oxitetraciclina muestra un prolongado tiempo medio de residencia (Ziółkowski et al., 2016 ), que se refleja en un largo periodo de supresión (Tabla 1). La Figura 1a muestra la evolución de la concentración de oxitetraciclina en muestras de músculo y sangre de animales tratados con este antibiótico.
En ambas matrices la concentración de antimicrobiano descendió a lo largo del periodo de supresión siguiendo un ritmo de eliminación exponencial, situación descrita para xenobióticos en animales (Berninger y Brooks, 2010).
No se observaron diferencias (P˃0,05) en los tiempos de vida media de ambas matrices (Tabla 3): 3,43 días para músculo y 3,59 días para suero
Este hecho, junto con una concentración igual de este compuesto en sangre y músculo, hace de la sangre una matriz adecuada para el desarrollo de nuevos métodos de detección de residuos antibióticos in vivo.
LA SANGRE PUEDE SER
UNA MATRIZ ADECUADA PARA LA DETECCIÓN DE RESIDUOS DE
OXITETRACICLINA IN VIVO
La sulfametoxipiridazina está catalogada como una sulfonamida de larga acción y tiene largos periodos de supresión en animales de ganadería (Tabla 1). La Figura 1b muestra un ritmo de eliminación similar en músculo y sangre, de 0,55 días (Tabla 3), aunque se describieron diferencias significativas entre las concentraciones descritas en ambas matrices (P<0,05).
En concreto, la concentración descrita en sangre fue 3 veces superior a la descrita en músculo, de forma que, aunque esta matriz sea un buen indicador de lo que está sucediendo en músculo, la adaptación de un test comercial actual requeriría la disminución de su sensibilidad a este compuesto. No obstante, dado que los métodos de cribado pretenden evitar la entrada de residuos antibióticos a la cadena alimentaria, la aparición de falsos positivos no supondría un riesgo sanitario y el análisis confirmatorio ofrecería el resultado real.
LA SANGRE PUEDE SER
UNA MATRIZ ADECUADA PARA LA DETECCIÓN DE RESIDUOS DE SULFAMETOXIPIRIDAZINA IN VIVO SI SE DISMINUYE LA SENSIBILIDAD DEL TEST COMERCIAL
En este estudio, la enrofloxacina siguió un ritmo de eliminación exponencial (Figura 1c) distinto en músculo y sangre (Tabla 3). Mientras que en músculo el tiempo de vida media fue de 0,92 días, en sangre fue de 1,90 Además, la concentración durante los primeros días del periodo de supresión fue mayor en músculo que en sangre, hallazgo ya descrito por otros autores en otros modelos animales (Cars, 1997 ).
Esta situación obligaría a un incremento en la sensibilidad del test a este compuesto a la hora de adaptarlo.
La Figura 1d muestra la rápida eliminación de este compuesto, que baja a concentraciones cercanas al LMR el primer día del periodo de supresión, escenario ya descrito en otras especies (Delis et al., 2010; Hung et al., 2019). Aunque esta eliminación rápida impide la identificación de un ritmo de eliminación exponencial claro, éste ha sido previamente descrito por otros autores (Hernández et al., 2005 ).
LA SANGRE PUEDE SER
UNA MATRIZ ADECUADA PARA LA DETECCIÓN
DE ENROFLOXACINA IN VIVO SI SE AUMENTA LA SENSIBILIDAD DEL TEST COMERCIAL
Todas las sustancias estudiadas en este trabajo siguieron un ritmo de eliminación exponencial, a excepción de la amoxicilina que, por su rápida eliminación, no pudo evaluarse adecuadamente.
La Figura 2 muestra el ritmo de eliminación hallado en músculo (Figura 2a) y sangre (Figura 2b).
La oxitetraciclina y la sulfametoxipiridazina siguieron el mismo ritmo de eliminación, mientras que la enrofloxacina mostró un ritmo de eliminación mayor en músculo que en sangre. Entre estos compuestos, el mayor ritmo de eliminación se describió en sulfametoxipiridazina, seguida por enrofloxacina y oxitetraciclina para ambas matrices (Tabla 1).
FIGURA 2A pesar de que existe un amplio abanico de métodos para la detección de residuos antibióticos en carne, es común que los métodos de cribado estén basados en la inhibición del crecimiento microbiano (Sanz et al., 2011 ).
En base a los datos expuestos, un nuevo método ante mortem basado en sangre no requeriría ninguna adaptación para la oxitetraciclina, aunque debería estudiarse el efecto que la sangre puede tener sobre el crecimiento en sí mismo. Por su parte, puesto que la concentración de sulfametoxipiridazina en sangre fue 3 veces superior a la detectada en músculo, la sensibilidad del test a la sulfametoxipiridazina debería reducirse, por ejemplo, reduciendo la concentración de trimetropim añadida al medio de crecimiento, puesto que este compuesto se añade de forma común a los tests para incrementar la sensibilidad a sulfonamidas (Suzuki et al, 2012).
El escenario con la enrofloxacina es el contrario: la concentración por encima y próxima al LMR es mayor en músculo que en sangre, de forma que el desarrollo de nuevos test in vivo debería disminuir su límite de detección para incrementar la sensibilidad.
Como la enrofloxacina es un antibiótico que inhibe la replicación del ADN, la sensibilidad se vería incrementada con la reducción de la concentración bacteriana en el test de cribado. A pesar de que los datos extraídos de las muestras pareadas de amoxicilina no permitieron comparar el comportamiento en músculo y sangre, la eliminación de este compuesto es tan rápida que su paso a la cadena alimentaria a través de la carne es improbable y no resultaría un compuesto limitante a la hora de desarrollar nuevos test de cribado de base biológica.
El proyecto ha sido cofinanciado al 65% por el Fondo Europeo de Desarrollo Regional (FEDER) a través del Programa Interreg V-A España-Francia-Andorra (POCTEFA 2014-2020).
Más información del proyecto POCTEFA-TESTACOS en www.testacos.com
Berninger, J.P.; Brooks, B.W. Leveraging mammalian pharmaceutical toxicology and pharmacology data to predict chronic fish responses to pharmaceuticals. Toxicol. Lett. 2010, 193, 69–78. Cars, O. Efficacy of beta-lactam antibiotics: Integration of pharmacokinetics and pharmacodynamics. Diagn. Microbiol. Infect. Dis. 1997, 27, 29–33.Decisión de la Comisión de 12 de agosto de 2002 por la que se aplica la Directiva 96/23/CE del Consejo en cuanto al funcionamiento de los métodos analíticos y la interpretación de los resultados. Diario Oficial de la Unión Europea, L221, 8-36. Delis, G.A.; Koutsoviti-Papadopoulou, M.; Theodosiadou, E.; Kounenis, G.; Batzias, G.C. Peripheral distribution of amoxicillin in sheep and influence of local inflammation. Vet. J. 2010, 185, 310–316.
Directiva 2001/82/CE del Parlamento Europeo y del Consejo, de 6 de noviembre de 2001, por la que se establece un código comunitario sobre medicamentos veterinaries. Diario Oficial de las Comunidades Europeas, L311, 1-110. Directiva 96/23/CE del Consejo de 29 de abril de 1996 relativa a las medidas de control aplicables respecto de determinadas sustancias y sus residuos en los animales vivos y sus productos y por la que se derogan las Directivas 85/358/CEE y 86/469/CEE y las Decisiones 89/187/ CEE y 91/664/CEE. Diario Oficial de las Comunidades Europeas, L125, 10-31. Djekic, I.; Radovi ć, Č.; Luki ć, M.; Staniši ć, N.; Lili ć, S. Environmental life-cycle assessment in production of pork products. Meso 2015, 17. EFSA, European Food Safety Authority (2020). Report for 2018 on the results from the monitoring of veterinary medicinal product residues and other substances in live animals and animal products. Disponible online: https://efsa.
Puesto que los test de cribado son una herramienta ampliamente extendida en los planes de vigilancia, su adaptación a animal vivo supondría ventajas, no sólo desde el punto de vista sanitario, sino también económico y medioambiental.
Una forma eficiente de encontrar una matriz sustituta de la carne que sea reflejo de su status es a través del estudio de muestras pareadas obtenidas de un mismo animal. Así, tras la creación de un banco de muestras y el estudio del comportamiento de 4 antimicrobianos (oxitetraciclina, sulfametoxipiridazina enrofloxacina y amoxicilina) de distintas familias en músculo y sangre de cerdos tratados, se concluyó que la sangre es una matriz adecuada para el desarrollo de nuevos métodos in vivo para la detección de antibióticos En este sentido, y en el ámbito del proyecto TESTACOS, actualmente se está procediendo a la validación de dos nuevos test de detección de antibióticos, sulfamidas y quinolonas para animales vivos basados en el uso de la sangre como matriz de diagnóstico
onlinelibrary.wiley.com/doi/epdf/10.2903/sp.efsa.2020. EN-1775%20Consultado%20el%2003/02/2020" https://efsa.onlinelibrary.wiley.com/doi/epdf/10.2903/ sp.efsa.2020.EN-1775 Consultado el 03/02/2020. EMA, European Medicines Agency (2020). Sales of veterinary antimicrobial agents in 31 European countries in 2018. Trends from 2010 to 2018. Tenth ESVAC report. Disponible online: https://www.ema.europa.eu/en/documents/ report/sales-veterinary-antimicrobial-agents-31-european-countries-2018-trends-2010-2018-tenth-esvac-report_en.pdf.%20Consultado%20el%2003/02/2020" https://www.ema.europa.eu/en/documents/report/ sales-veterinary-antimicrobial-agents-31-european-countries-2018-trends-2010-2018-tenth-esvac-report_en.pdf. Consultado el 03/02/2020. Gaudin, V. Advances in biosensor development for the screening of antibiotic residues in food products of animal origin—A comprehensive review. Biosens. Bioelectron. 2017, 90, 363–377. Hernández, E.; Rey, R.; Puig, M.; Garcia, M.A.; Solans, C.; Bregante, M.A. Pharmacokinetics and residues of a new oral amoxicillin formulation in piglets: A preliminary study. Vet. J. 2005, 170, 237–242. Hung, Y.W.; Lin, Y.H.; Chan, C.Y.; Wang, W.S.; Chiu, C.F.; Chiu, C.C.; Chiu, H.W.; Tsai, W.H.; Hung, S.W. Pharmacokinetic study of amoxicillin in Japanese eel Anguilla japonica by high performance liquid chromatography with fluorescence detection. Aquac. Rep. 2019, 13, 100184. Mitchell, J.M.; Griffiths, M.W.; McEwen, S.A.; McNab, W.B.; Yee, A.J. Antimicrobial drug residues in milk and meat: Causes, concerns, prevalence, regulations, tests, and test performance. J. Food Prot. 1998, 61, 742–756.
OMS, Organizción Munsial de la Salud (2017). El enfoque multisectorial de la OMS “Una salud”. Disponible online: https://www.who.int/features/qa/one-health/ es/. Consultado el 04/02/2020 Pikkemaat, M.G. Microbial screening methods for detection of antibiotic residues in slaughter animals. Anal. Bioanal. Chem. 2009, 395, 893–905. Reglamento (CE) No 1099/2009 del Consejo de 24 de septiembre de 2009 relativo a la protección de los animales en el momento de la matanza. Diario Oficial de la Unión Europea, 303, 1-30. Reglamento (CEE) No 2377/90 del Consejo de 26 de junio de 1990 por el que se establece un procedimiento comunitario de fijación de los límites máximos de residuos de medicamentos veterinarios en los alimentos de origen animal. Diario Oficial de las Comunidades Europeas, L224, 1-8. Reyes-Herrera, I.; Schneider, M.J.; Cole, K.; Farnell, M.B.; Blore, P.J.; Donoghue, D.J. Concentrations of antibiotic residues vary between different edible muscle tissues in poultry. Research note. J. Food Prot. 2005, 68, 2217–2219. Riviere, J.E. 2. Absorption, distribution, metabolism, and elimination. In Veterinary Pharmacology and Therapeutics, 9th ed.; Riviere, J.E. & Papich, M.G., Eds.; Willey Blackwell: Ames, IA, USA, 2009; 11-46. Sanz, D.; Mata, L.; Condón, S.; Sanz, M.Á.; Razquin, P. Performance of a new microbial test for quinolone residues in muscle. Food Anal. Methods 2011, 4, 212–220. Suzuki, S.; Hoa, P.T.P. Distribution of quinolones, sulfonamides, tetracyclines in aquatic environment and antibiotic resistance in Indochina. Front. Microbiol. 2012, 3, 67. Vaden, S.L.; Riviere, J.E. Chapter 4
NO ESPERES A QUE LA BURBUJA ESTALLE
Actúa ya. La prohibición del óxido de zinc está cada vez más cerca y requiere preparación previa; con ello contribuiremos tanto en la lucha contra las resistencias antibióticas como a mantener unos beneficios saludables en las explotaciones.
Elije lo probado, la vacuna oral que protege a los cerdos contra la diarrea posdestete (DPD) causada por E.coli *, ayudando a mejorar la salud intestinal1.
Te acompañamos en esta preparación para el cambio.

* Diarrea posdestete causada por cepas F4/F18 ETEC E.coli
en Coliprotec.
1. Vangroenweghe, Frédéric. Improved weight gain and reduced mortality and antibiotic use following vaccination with Coliprotec® F4, an oral live vaccine against post-weaning diarrhoea. 2017. Proceedings ESPHM, Prague, Czech Republic: 254.
Coliprotec F4/F18 liofilizado para suspensión oral para porcino. Titular de la autorización de comercialización: Prevtec Microbia GmbH, Geyerspergerstr. 27, 80689 Múnich, ALEMANIA. Composición cualitativa y cuantitativa, Sustancia activa: Cada dosis de la vacuna contiene: Sustancias activas: Escherichia coli, viva no patógena cepa O8:K87* (F4ac): 1,3x108 a 9,0x108 UFC** E. coli, viva no patógena cepa O141:K94* (F18ac): 2,8x108 a 3,0x109 UFC** * no atenuadas **UFC: unidades formadoras de colonias. Indicaciones de uso: Porcino. Para la inmunización activa de porcino a partir de los 18 días de vida contra E. coli enterotoxigénica F4 positiva y F18 positiva, a fin de: reducir la incidencia de diarrea posdestete (DPD), moderada o grave, causada por E. coli en los lechones infectados; reducir la excreción fecal de E.coli enterotoxigénica F4 positiva y F18 positiva por los lechones infectados. Establecimiento de la inmunidad: 7 días después de la vacunación. Duración de la inmunidad: 21 días después de la vacunación. Contraindicaciones: Ninguna. No se recomienda vacunar animales que estén en tratamiento con inmunodepresores ni vacunar animales que estén recibiendo un tratamiento antibacteriano eficaz contra E. coli.. Precauciones especiales para su uso en animales: Vacunar solamente animales sanos. Los lechones vacunados pueden excretar las cepas vacunales durante al menos 14 días después de la vacunación. Las cepas vacunales se transmiten fácilmente a otros cerdos en contacto con los lechones vacunados. Los cerdos no vacunados en contacto con lechones vacunados albergarán y excretarán las cepas vacunales igual que los lechones vacunados. Durante este tiempo, debe evitarse el contacto de cerdos inmunodeprimidos con los lechones vacunados. Precauciones específicas que debe tomar la persona que administre el medicamento veterinario a los animales: Usar un equipo de protección personal consistente en guantes protectores desechables y gafas de seguridad al manipular el medicamento veterinario. En caso de ingestión accidental, consulte con un médico inmediatamente y muéstrele el prospecto o la etiqueta. En caso de derrame sobre la piel, lave la zona con agua y consulte con un médico inmediatamente y muéstrele el prospecto o la etiqueta. Tiempo de espera: Cero días. Medicamento sujeto a prescripción veterinaria. Nº de registro: EU/2/16/202/001-003. Coliprotec, Elanco, y la barra diagonal son marcas registradas de Elanco o sus afiliadas ©2020 Elanco o sus afiliadas . PM-ES-20-0332
En agradecimiento a las empresas patrocinadoras:

El medio técnico-científico, innovador y exclusivo para veterinarios de